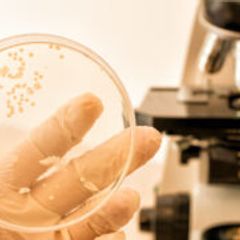

| |
Current News Review at 1 p.m. EST Daily
Current News: https://www.inoreader.com/stream/user/1006407045/tag/Current%20News/view/html?cs=m&sb=y
The News And Times - https://thenewsandtimes.blogspot.com/
Current Selected Articles: https://www.inoreader.com/stream/user/1006407045/tag/user-favorites/view/html
All Current Articles: https://www.inoreader.com/stream/user/1006407045/tag/all-articles/view/html |
|
|
|
| Donald Trump set to be booked, fingerprinted, and to appear before judge in Manhattan... |
| Donald Trump set to be booked, fingerprinted, and to appear before judge in Manhattan court San Bernardino... |
 "George Santos" - Google News "George Santos" - Google News | now | |
|
|
|
| A look inside protests near the Manhattan courthouse ahead of ... - Axios |
| A look inside protests near the Manhattan courthouse ahead of ... Axios |
 "George Santos" - Google News "George Santos" - Google News | now | |
|
|
|
| Radio Station WHMI 93.5 FM — Livingston County Michigan News, Weather, Traffic, Sports,... |
| Radio Station WHMI 93.5 FM — Livingston County Michigan News, Weather, Traffic, Sports, School Updates,... |
 "George Santos" - Google News "George Santos" - Google News | now | |
|
|
|
| Embattled Rep. George Santos joins pro-Trump protest outside Manhattan courthouse... |
| Embattled Rep. George Santos joins pro-Trump protest outside Manhattan courthouse Yahoo News |
 "George Santos" - Google News "George Santos" - Google News | now | |
|
|
|
| Global Monkeypox Virus Outbreak 2022: A Bibliometric Analysis - Cureus |
| Global Monkeypox Virus Outbreak 2022: A Bibliometric Analysis Cureus |
 "2022 monkeypox outbreak" - Google News "2022 monkeypox outbreak" - Google News | now | |
|
|
|
| Live updates: Donald Trump set for historic arraignment - Midland Daily News |
| Live updates: Donald Trump set for historic arraignment Midland Daily News |
 "Investigations of US Elections 2016" - Google News "Investigations of US Elections 2016" - Google News | now | |
|
|
|
| Putin will be angry Finland has joined Nato – but he only has himself ... - Yahoo... |
| Putin will be angry Finland has joined Nato – but he only has himself ... Yahoo News |
 "Russia plans to annex parts of eastern Ukraine" - Google News "Russia plans to annex parts of eastern Ukraine" - Google News | 1m | |
|
|
|
 | Jill Biden Walks Back White House Invitation For Both LSU And Iowa Women's Basketball... |
| A record number of people tuned into Sunday's women's NCAA championship game. |
 Markets and Business News Review Markets and Business News Review | 2m | |
|
|
|
 | ExxonMobil Emphasizes Hydrogen, CCS In Low Carbon Solutions Spotlight |
| During a session highlighting its Low Carbon Business Solutions business unit Tuesday, executives from... |
 Markets and Business News Review Markets and Business News Review | 2m | |
|
|
|
 | 5,000 GM Employees Take Buyouts In Cost-Cutting Program |
| GM had reportedly laid off as many as 500 employees last month. |
 Markets and Business News Review Markets and Business News Review | 2m | |
|
|
|
 | India Box Office: 'Bholaa' Grosses $8 Million, 'Dasara' $11 Million |
| India box office report: Nani's new film 'Dasara' has earned more than Ajay Devgn's Hindi film 'Bholaa'... |
 Markets and Business News Review Markets and Business News Review | 2m | |
|
|
|
| AMC Down 21% Premarket as APE-Conversion Lawsuit Settled |
| A court filing on Monday showed that AMC has agreed to settle a lawsuit relating to converting its preferred... |
 Markets and Business News Review Markets and Business News Review | 2m | |
|
|
|
 | Trump Faces 34 Felony Counts For Falsifying Records, Report Says |
| Former President Donald Trump will be charged with 34 felony counts for falsifying business records,... |
 Markets and Business News Review Markets and Business News Review | 2m | |
|
|
|
 | Regulatory Reform's Role In Addressing The Debt Limit |
| Among other regulatory streamlining imperatives, any increase in the debt limit should be accompanied... |
 Markets and Business News Review Markets and Business News Review | 2m | |
|
|
|
 | Western Union Becomes Oversold |
| In the case of Western Union, the RSI reading has hit 29.2 — by comparison, the universe of dividend... |
 Markets and Business News Review Markets and Business News Review | 2m | |
|
|
|
| G7 Trade Ministers Back Tech Export Controls - Barron's |
| G7 Trade Ministers Back Tech Export Controls Barron's |
 "G7" - Google News "G7" - Google News | 2m | |
|
|
|
| Top Mexico cartel member extradited to US to face drug charges -Justice Dept |
| 2023-04-04T16:40:17ZA top member of Mexico's powerful Sinaloa drug cartel has been extradited to the... |
 Reuters Reuters | 2m | |
|
|
|
 | Traders bet Fed won"t raise rates further as job market cools |
| 2023-04-04T16:28:51ZThe U.S. Federal Reserve building is pictured in Washington, March 18, 2008. REUTERS/Jason... |
 Reuters Reuters | 2m | |
|
|
|
 | Branson"s Virgin Orbit files for bankruptcy after launch failure squeezed finances |
| 2023-04-04T16:47:36ZRichard Branson's Virgin Orbit filed for Chapter 11 bankruptcy on Tuesday (April... |
 Reuters Reuters | 2m | |
|
|
|
 | Ford"s quarterly US auto sales jump 10.1% on pent-up demand, easing supply |
| 2023-04-04T16:25:12ZFord Motor Co (F.N) posted a 10.1% rise in first-quarter U.S. auto sales on Tuesday,... |
 Reuters Reuters | 2m | |
|
|
|
| Civilians Organize to Resist Russian Occupation in Ukraine - Human Rights First |
| Civilians Organize to Resist Russian Occupation in Ukraine Human Rights First |
 "kharkiv" - Google News "kharkiv" - Google News | 3m | |
|
|
|
| 'He's a war criminal': Elite Putin security officer defects |
| AP correspondent Charles de Ledesma reports on Russia Elite Defector. |
 AP Audio Wire AP Audio Wire | 3m | |
|
|
|
| Former top aide to Maryland governor dead after manhunt |
| AP correspondent Jennifer King reports on Maryland Manhunt. |
 AP Audio Wire AP Audio Wire | 3m | |
|
|
|
| Idaho man arrested for alleged revenge killing of main suspect in his mother's murder... |
| Idaho man arrested for alleged revenge killing of main suspect in his mother's murder New York Post... |
 "Idaho murders" - Google News "Idaho murders" - Google News | 3m | |
|
|
|
 | US sanctions Lebanese brothers who sold 'compromised fuel' |
| WASHINGTON (AP) — The U.S. Treasury Department on Tuesday sanctioned two Lebanese brothers who are accused... |
 Associated Press News: Breaking News | Latest News Today Associated Press News: Breaking News | Latest News Today | 3m | |
|
|
|
| COVID shots are 'low priority' for healthy kids, teens, WHO says. What does that... |
| COVID shots are 'low priority' for healthy kids, teens, WHO says. What does that mean? Miami Herald |
 "COVID" - Google News "COVID" - Google News | 5m | |
|
|
|
| Future Covid Shots Need Broader Coverage, FDA Vaccine Head Says - Bloomberg Law |
| Future Covid Shots Need Broader Coverage, FDA Vaccine Head Says Bloomberg Law |
 "COVID" - Google News "COVID" - Google News | 5m | |
|
|
|
| US rule to allow some inmates to stay home after COVID emergency ... - Reuters |
| US rule to allow some inmates to stay home after COVID emergency ... Reuters |
 "COVID" - Google News "COVID" - Google News | 5m | |
|
|
|
| US rule to allow some inmates to stay home after COVID emergency lifts - Yahoo News |
| US rule to allow some inmates to stay home after COVID emergency lifts Yahoo News |
 "COVID" - Google News "COVID" - Google News | 5m | |
|
|
|
| Updated Pfizer-BioNTech COVID-19 Vaccine Now Available as ... - Fairfax County Government... |
| Updated Pfizer-BioNTech COVID-19 Vaccine Now Available as ... Fairfax County Government NewsCenter |
 "COVID" - Google News "COVID" - Google News | 5m | |
|
|
|
| Exchanged Russian Sniper Convicted for Striking Civilian | Institute ... - Institute... |
| Exchanged Russian Sniper Convicted for Striking Civilian | Institute ... Institute for War & Peace... |
 "kyiv" - Google News "kyiv" - Google News | 6m | |
|
|
|
| Trump's expected surrender creates New York spectacle |
| |
 All Stories All Stories | 6m | |
|
|
|
| About 5K GM salaried workers take buyouts, avoiding layoffs |
| |
 All Stories All Stories | 6m | |
|
|
|
 | |
| Today, we are honored to welcome Finland as @NATO's 31st Ally. Finland's membership strengthens our collective... |
 Secretary Antony Blinken (Twitter) Secretary Antony Blinken (Twitter) | 8m | |
|
|
|
| AP News Summary at 11:22 a.m. EDT - FOX 28 Spokane |
| AP News Summary at 11:22 a.m. EDT FOX 28 Spokane |
 "FBI AND ITS ROLE IN ELECTION 2016" - Google News "FBI AND ITS ROLE IN ELECTION 2016" - Google News | 8m | |
|
|
|
| Should India Respond To NATO's Overtures? – Analysis - Eurasia Review |
| Should India Respond To NATO's Overtures? – Analysis Eurasia Review |
 "Intelligence Assessments of Russia Ukraine War 2022" - Google News "Intelligence Assessments of Russia Ukraine War 2022" - Google News | 9m | |
|
|
|
| Fox News show descends into fighting on Trump arraignment day: 'I'm getting heckled... |
| Fox News show descends into fighting on Trump arraignment day: 'I'm getting heckled here' Yahoo News |
 "special counsel jack smith" - Google News "special counsel jack smith" - Google News | 12m | |
|
|
|
| 'Harry Potter' to Reportedly Become a TV Show, With J.K. Rowling in Tow - Vanity... |
| 'Harry Potter' to Reportedly Become a TV Show, With J.K. Rowling in Tow Vanity Fair |
 "special counsel jack smith" - Google News "special counsel jack smith" - Google News | 12m | |
|
|
|
| Kroll to Exhibit at RISKWORLD Conference 2023 - Kroll |
| Kroll to Exhibit at RISKWORLD Conference 2023 Kroll |
 "global threats to U.S. security 2023" - Google News "global threats to U.S. security 2023" - Google News | 12m | |
|
|
|
| Finland joins NATO in major blow to Russia over Ukraine war - Oregon Public Broadcasting |
| Finland joins NATO in major blow to Russia over Ukraine war Oregon Public Broadcasting |
 "global threats to U.S. security 2023" - Google News "global threats to U.S. security 2023" - Google News | 12m | |
|
|
|
| Additional U.S. Security Assistance for Ukraine - United States ... - Department... |
| Additional U.S. Security Assistance for Ukraine - United States ... Department of State |
 "Ukraine" - Google News "Ukraine" - Google News | 12m | |
|
|
|
| Ukraine Latest: Finland Joins NATO; US Provides More Weapons Aid - Financial Post |
| Ukraine Latest: Finland Joins NATO; US Provides More Weapons Aid Financial Post |
 "weapons for ukraine" - Google News "weapons for ukraine" - Google News | 13m | |
|
|
|
| Three quarters in the US worry the Russia-Ukraine war will go ... - Daily Mail |
| Three quarters in the US worry the Russia-Ukraine war will go ... Daily Mail |
 "weapons for ukraine" - Google News "weapons for ukraine" - Google News | 13m | |
|
|
|
 | Trump to surrender at NY courthouse ahead of arraignment | LIVE |
| Donald Trump is expected to travel from Trump Tower to the courthouse in New York for his booking and... |
 Associated Press Associated Press | 15m | |
|
|
|
 | The women rule on ABC's 'General Hospital' |
| (4 Apr 2023) As "General Hospital" marks its 60th anniversary, much remains the same for the series,... |
 Associated Press Associated Press | 15m | |
|
|
|
 | Rep. Santos makes surprise appearance outside of NY courthouse ahead of Trump's arraignment.... |
| George Santos, the Republican congressman facing multiple investigations into lies he told while running... |
 Associated Press Associated Press | 15m | |
|
|
|
 | Trump llega a la Torre Trump antes de entregarse |
| (4 Apr 2023) El expresidente Donald Trump llegó a la Torre Trump en Nueva York el lunes un día antes... |
 Associated Press Associated Press | 15m | |
|
|
|
 | Concerns about Fukushima quake resistance |
| (4 Apr 2023) Concerns about Fukushima quake resistance Subscribe for more Breaking News: http://smarturl.it/AssociatedPress... |
 Associated Press Associated Press | 15m | |
|
|
|
| Global Monkeypox Virus Outbreak 2022: A Bibliometric Analysis - Cureus |
| Global Monkeypox Virus Outbreak 2022: A Bibliometric Analysis Cureus |
 "monkeypox" - Google News "monkeypox" - Google News | 16m | |
|
|
|
| Japanese PM To Hold Meetings Before G7 Summit, War In Ukrain... - MENAFN.COM |
| Japanese PM To Hold Meetings Before G7 Summit, War In Ukrain... MENAFN.COM |
 "G7 and Russia Ukraine war" - Google News "G7 and Russia Ukraine war" - Google News | 17m | |
|
|
|
 | F-22 Raptor Upgrades to Keep it Flying for 2070 or Longer |
| After delivering some of the first strikes in the U.S.-led coalition military action against ISIS, the... |
 19FortyFive 19FortyFive | 17m | |
|
|
|
 | Fokker D. VII: The Best Fighter Plane of World War I? |
| While there are a number of contenders for the best Allied aircraft of the First World War, most aviation... |
 19FortyFive 19FortyFive | 17m | |
|
|
|
 | The SR-71C 'Bastard' was the Frankenstein Spy Plane |
| The Lockheed SR-71 "Blackbird" was quite an aircraft – it was designed to enter hostile airspace, take... |
 19FortyFive 19FortyFive | 17m | |
|
|
|
 | XB-70A Valkyrie: Supersonic Bomber Turned Passenger Jet? |
| According to released documents, the U.S. military considered transforming its massive experimental XB-70A... |
 19FortyFive 19FortyFive | 17m | |
|
|
|
 | Donald Trump's Biggest Fear Might Come True Today (Not Jail) |
| Donald Trump has already used the indictment as a way to raise at least $7 million for his campaign.... |
 19FortyFive 19FortyFive | 17m | |
|
|
|
 | UConn emerges victorious after March Madness full of upsets |
| The Cinderellas certainly had their moments in this March Madness. Morethanafew, actually.In the end,... |
 Associated Press News: Breaking News | Latest News Today Associated Press News: Breaking News | Latest News Today | 19m | |
|
|
|
 | Rory McIlroy returns to Masters in search of green jacket |
| AUGUSTA, Ga. (AP) — Rory McIlroy has had plenty of memorable moments on the back nine on Sunday, but... |
 Associated Press News: Breaking News | Latest News Today Associated Press News: Breaking News | Latest News Today | 19m | |
|
|
|
| |
| A month ago, I released my budget to invest in America and lower costs. House Republicans still haven't... |
 President Biden (Twitter) President Biden (Twitter) | 19m | |
|
|
|
| |
| We're building out our manufacturing capacity and making things in America again. That way we never... |
 President Biden (Twitter) President Biden (Twitter) | 19m | |
|
|
|
| Albanian Daily News - albaniandailynews.com |
| Albanian Daily News albaniandailynews.com |
 "Charles McGonigal" - Google News "Charles McGonigal" - Google News | 22m | |
|
|
|
| Public Health Supports the Warfighter, Military Community Worldwide - Health.mil |
| Public Health Supports the Warfighter, Military Community Worldwide Health.mil |
 "global threats to U.S. security" - Google News "global threats to U.S. security" - Google News | 22m | |
|
|
|
| Foreign Ministry Spokesperson Mao Ning's Regular Press ... - MFA China |
| Foreign Ministry Spokesperson Mao Ning's Regular Press ... MFA China |
 "global threats to U.S. security" - Google News "global threats to U.S. security" - Google News | 22m | |
|
|
|
| Secretary Blinken's Meeting with NATO Secretary General ... - Department of State |
| Secretary Blinken's Meeting with NATO Secretary General ... Department of State |
 "Stoltenberg" - Google News "Stoltenberg" - Google News | 23m | |
|
|
|
| |
| ISW said that Tatarsky shared his ideology and activities with many other #Russian milbloggers and so... |
 ISW (Twitter) ISW (Twitter) | 24m | |
|
|
|
 | |
| @TheStudyofWar The commitment of VDV units with TOS-1 support to this, or any axis, is unlikely to lend... |
 ISW (Twitter) ISW (Twitter) | 24m | |
|
|
|
| |
| @TheStudyofWar TOS-1A thermobaric artillery systems are mil. district–lvl assets & are not tied to... |
 ISW (Twitter) ISW (Twitter) | 24m | |
|
|
|
 | |
| Apr. 3 Assessment Highlight: #Russian sources reported on Apr. 3 that units of the Russian Airborne... |
 ISW (Twitter) ISW (Twitter) | 24m | |
|
|
|
| Danilov calls Shoigu's statement about transferring Iskanders to Belarus a bluff... |
| Danilov calls Shoigu's statement about transferring Iskanders to Belarus a bluff Ukrinform |
 "shoigu" - Google News "shoigu" - Google News | 25m | |
|
|
|
| Finland joins NATO, doubling military alliance's border with Russia ... - CBS 6 News... |
| Finland joins NATO, doubling military alliance's border with Russia ... CBS 6 News Richmond WTVR |
 "Scholz and Putin" - Google News "Scholz and Putin" - Google News | 27m | |
|
|
|
| Is the internet down? Twitter & Virgin users reporting issues - NationalWorld |
| Is the internet down? Twitter & Virgin users reporting issues NationalWorld |
 "twitter down" - Google News "twitter down" - Google News | 27m | |
|
|
|
| Twitter is down as thousands of users report problems with social ... - The Scotsman |
| Twitter is down as thousands of users report problems with social ... The Scotsman |
 "twitter down" - Google News "twitter down" - Google News | 27m | |
|
|
|
| Twitter is down as thousands of users report problems with social media platform... |
| Twitter is down as thousands of users report problems with social media platform The Scotsman |
 "twitter down" - Google News "twitter down" - Google News | 27m | |
|
|
|
| Cartoons: Donald Trump's mug shot, fingerprints and orange jumpsuit - The Columbus... |
| Cartoons: Donald Trump's mug shot, fingerprints and orange jumpsuit The Columbus Dispatch |
 trump - Google News trump - Google News | 27m | |
|
|
|
| Alvin Bragg is Playing to Trump's Strengths, Reagan Speechwriter Says - Newsweek |
| Alvin Bragg is Playing to Trump's Strengths, Reagan Speechwriter Says Newsweek |
 trump - Google News trump - Google News | 27m | |
|
|
|
| Marjorie Taylor Greene Stumps at Trump Rally, Quickly Whisked Away - NBC New York |
| Marjorie Taylor Greene Stumps at Trump Rally, Quickly Whisked Away NBC New YorkMarjorie Taylor Greene... |
 trump - Google News trump - Google News | 27m | |
|
|
|
| Trump Tower Stakeout - C-SPAN |
| Trump Tower Stakeout C-SPAN |
 trump - Google News trump - Google News | 27m | |
|
|
|
| Hours from his own arraignment, Trump says Manhattan DA Alvin Bragg should 'INDICT... |
| Hours from his own arraignment, Trump says Manhattan DA Alvin Bragg should 'INDICT HIMSELF' Yahoo! Voices |
 trump - Google News trump - Google News | 27m | |
|
|
|
| A peek behind the curtain of NPR's coverage of Trump's indictment - NPR |
| A peek behind the curtain of NPR's coverage of Trump's indictment NPR |
 trump - Google News trump - Google News | 27m | |
|
|
|
| Trump Indictment: Why It's So Hard to Forecast What Comes Next - Barron's |
| Trump Indictment: Why It's So Hard to Forecast What Comes Next Barron's |
 trump - Google News trump - Google News | 27m | |
|
|
|
| Art Market Has Climbed Above Prepandemic Level, Major Study Says - The New York Times |
| Art Market Has Climbed Above Prepandemic Level, Major Study Says The New York Times |
 "g-7 2022" - Google News "g-7 2022" - Google News | 27m | |
|
|
|
| German opposition seeks inquiry over Scholz and tax scheme - WGN Radio - Chicago |
| German opposition seeks inquiry over Scholz and tax scheme WGN Radio - Chicago |
 "scholz" - Google News "scholz" - Google News | 28m | |
|
|
|
 | County sisters hope for awards success with beauty range - East Lothian Courier |
| East Lothian Courier |
 "project raven" - Google News "project raven" - Google News | 29m | |
|
|
|
 | First Look: 2023 Habit - Cannondale's Most Popular Bike Gets ... - Pinkbike.com |
| Pinkbike.com |
 "project raven" - Google News "project raven" - Google News | 29m | |
|
|
|
| Trump indictment live updates: George Santos, Marjorie Taylor Greene outside court... |
| Trump indictment live updates: George Santos, Marjorie Taylor Greene outside court WOKV |
 "George Santos" - Google News "George Santos" - Google News | 32m | |
|
|
|
| Circus underway: Marjorie Taylor Greene, George Santos home in ... - POLITICO |
| Circus underway: Marjorie Taylor Greene, George Santos home in ... POLITICO |
 "George Santos" - Google News "George Santos" - Google News | 32m | |
|
|
|
| Live updates for Trump's New York arraignment - PBS NewsHour |
| Live updates for Trump's New York arraignment PBS NewsHour |
 "George Santos" - Google News "George Santos" - Google News | 32m | |
|
|
|
| Protests in Georgia and Tbilisi's Complicated Relationship with ... - Crisis Group |
| Protests in Georgia and Tbilisi's Complicated Relationship with ... Crisis Group |
 "Will Russia turn to the West?" - Google News "Will Russia turn to the West?" - Google News | 32m | |
|
|
|
| Teen in serious condition after being shot - Odessa American |
| Teen in serious condition after being shot Odessa American |
 "Odessa" - Google News "Odessa" - Google News | 32m | |
|
|
|
| A new church has been planted in Odessa - The Laker/Lutz News |
| A new church has been planted in Odessa The Laker/Lutz News |
 "Odessa" - Google News "Odessa" - Google News | 32m | |
|
|
|
| OPD investigating major crash - KMID - Local 2 News |
| OPD investigating major crash KMID - Local 2 News |
 "Odessa" - Google News "Odessa" - Google News | 32m | |
|
|
|
| G7 trade ministers hold first meeting of year amid global trade tension - Reuters |
| G7 trade ministers hold first meeting of year amid global trade tension Reuters |
 "G7" - Google News "G7" - Google News | 32m | |
|
|
|
| Blog Series: Sanctions Enforcement Around the G7, the Italian ... - Sanctions & Export... |
| Blog Series: Sanctions Enforcement Around the G7, the Italian ... Sanctions & Export Controls Update... |
 "G7" - Google News "G7" - Google News | 32m | |
|
|
|
| Last Year’s 24 Biggest Scandals |
| Last week, Donald Trump became the first current or former U.S. president to be charged with a crime.... |
 Markets and Business News Review Markets and Business News Review | 33m | |
|
|
|
 | IRS Extends Tax Deadline To More Tornado Victims |
| The IRS has extended tax deadlines for several storm-hit states over the past few weeks, most recently... |
 Markets and Business News Review Markets and Business News Review | 33m | |
|
|
|
 | Manchester United's Right-Back Battle Is Close Says Erik Ten Hag |
| Aaron Wan-Bissaka and Diogo Dalot have both impressed during the current campaign. |
 Markets and Business News Review Markets and Business News Review | 33m | |
|
|
|
 | Why Walgreens Boots Alliance Is A Top 25 SAFE Dividend Stock |
| Walgreens Boots Alliance has been named to the Dividend Channel ''S.A.F.E. 25'' list, signifying a stock... |
 Markets and Business News Review Markets and Business News Review | 33m | |
|
|
|
 | Jimin Ties His BTS Bandmate Suga On The Hot 100 Thanks To His New Hit |
| Jimin and Suga have both landed a trio of Hot 100 charting singles on their own. |
 Markets and Business News Review Markets and Business News Review | 33m | |
|
|
|
 | Trump's Arraignment: Here's What Time He'll Appear In Court And How To Get Updates |
| Former President Donald Trump will surrender to law enforcement Tuesday after being indicted last week... |
 Markets and Business News Review Markets and Business News Review | 33m | |
|
|
|
 | Photos: Manhattan Officials And Reporters Prepare Overnight For Trump's Arraignment |
| The NYPD said it is "ready to respond as needed" in the event of possible protests. |
 Markets and Business News Review Markets and Business News Review | 33m | |
|
|
|
 | New Set Footage Shows 'Walking Dead' Rick And Michonne Reunion |
| We are about to see the debut of Dead City, starring Negan and Maggie, then Daryl Dixon some time after... |
 Markets and Business News Review Markets and Business News Review | 33m | |
|
|
|
 | Wall St slips on recession worries after weak economic data |
| 2023-04-04T16:06:16ZTraders work on the floor of the New York Stock Exchange (NYSE) in New York City,... |
| |
|
|
|
 | Russia says Finland"s NATO accession is dangerous historic mistake |
| 2023-04-04T16:21:56ZFinnish and NATO flags are seen printed on paper this illustration taken April 13,... |
| |
|
|
|
 | Mine waste finds new life as source of rare earths |
| 2023-04-04T16:03:17ZSweden, South Africa and Australia are at the forefront of a push to transform piles... |
| |
|
|
|
 | In Russia"s St Petersburg, locals say Finland "making problems" with NATO accession |
| 2023-04-04T16:20:32ZA Finnish border officer stands on duty at the border between Finland and Russia... |
| |
|
|
|
 | Suspect in killing of Russian war blogger charged with terrorism |
| 2023-04-04T16:23:18ZDarya Trepova, suspected of bringing explosives to the cafe where war blogger Vladlen... |
| |
|
|
|
 | US job openings hit lowest level in nearly two years; more workers quit |
| 2023-04-04T16:01:02ZA pedestrian passes a "Help Wanted" sign in the door of a hardware store in Cambridge,... |
| |
|
|
|
| New AI technique could soon be used to triage wounded in Ukraine - Interesting Engineering |
| New AI technique could soon be used to triage wounded in Ukraine Interesting Engineering |
 "kharkiv" - Google News "kharkiv" - Google News | 34m | |
|
|
|
| Saturday's Billy Joel, Stevie Nicks Concert in Arlington Postponed Due to Ongoing... |
| Saturday's Billy Joel, Stevie Nicks Concert in Arlington Postponed Due to Ongoing Illness NBC 5 Dallas-Fort... |
 "COVID" - Google News "COVID" - Google News | 35m | |
|
|
|
| WHO Won't Advise COVID-19 Boosters for Healthy Groups, Ohio Sues PBMs - HealthCareExecIntelligence |
| WHO Won't Advise COVID-19 Boosters for Healthy Groups, Ohio Sues PBMs HealthCareExecIntelligence |
 "COVID" - Google News "COVID" - Google News | 35m | |
|
|
|
| Monoclonal Antibody Treatments Cut COVID Hospitalizations, Deaths by 39% - Tyler... |
| Monoclonal Antibody Treatments Cut COVID Hospitalizations, Deaths by 39% Tyler Morning Telegraph |
 "COVID" - Google News "COVID" - Google News | 35m | |
|
|
|
| Have we found the 'animal origin' of Covid? - BBC |
| Have we found the 'animal origin' of Covid? BBC |
 "COVID" - Google News "COVID" - Google News | 35m | |
|
|
|
| U.S. pledges another $2.6 billion in weapons aid to Kyiv - statement - Reuters |
| U.S. pledges another $2.6 billion in weapons aid to Kyiv - statement Reuters |
 "kyiv" - Google News "kyiv" - Google News | 35m | |
|
|
|
| Orthodox monks at Kyiv monastery brace for planned eviction - prairiepress.net |
| Orthodox monks at Kyiv monastery brace for planned eviction prairiepress.net |
 "kyiv" - Google News "kyiv" - Google News | 35m | |
|
|
|
| In Ukraine: Kyiv's Book Arsenal Plans a June Festival - Publishing Perspectives |
| In Ukraine: Kyiv's Book Arsenal Plans a June Festival Publishing Perspectives |
 "kyiv" - Google News "kyiv" - Google News | 35m | |
|
|
|
| Pompeo meets Zelenskyy in Kyiv visit, tells Fox arming Ukraine is 'least costly way... |
| Pompeo meets Zelenskyy in Kyiv visit, tells Fox arming Ukraine is 'least costly way to move forward' Yahoo... |
 "kyiv" - Google News "kyiv" - Google News | 35m | |
|
|
|
| 'Heat' Turns Up On Pro-Putin Pop Stars Following Latest Zhara Festival Cancellation... |
| 'Heat' Turns Up On Pro-Putin Pop Stars Following Latest Zhara Festival Cancellation In Tashkent Radio... |
 "Putin in Beijing" - Google News "Putin in Beijing" - Google News | 36m | |
|
|
|
| Trade and politics intersect as Macron and von der Leyen visit Beijing - The Irish... |
| Trade and politics intersect as Macron and von der Leyen visit Beijing The Irish Times |
 "Putin in Beijing" - Google News "Putin in Beijing" - Google News | 36m | |
|
|
|
| China is not only asserting itself geopolitically but openly ... - MarketWatch |
| China is not only asserting itself geopolitically but openly ... MarketWatch |
 "Putin in Beijing" - Google News "Putin in Beijing" - Google News | 36m | |
|
|
|
 | |
| Good to see Turkish Foreign Minister @MevlutCavusoglu again after our discussions on earthquake recovery... |
 Secretary Antony Blinken (Twitter) Secretary Antony Blinken (Twitter) | 36m | |
|
|
|
| Okmulgee deputies asking for help identifying witnesses, suspect ... - KTUL |
| Okmulgee deputies asking for help identifying witnesses, suspect ... KTUL |
 "Tulsa shooting" - Google News "Tulsa shooting" - Google News | 37m | |
|
|
|
| NPR refuses to air Trump's speech from Mar-a-Lago live: 'Not what we owe our audience'... |
| NPR refuses to air Trump's speech from Mar-a-Lago live: 'Not what we owe our audience' WJAR |
 "Mar-a-Lago" - Google News "Mar-a-Lago" - Google News | 39m | |
|
|
|
| Putin accused of ordering bombing hit on propagandist blown up in Russia - Express |
| Putin accused of ordering bombing hit on propagandist blown up in Russia Express |
 "Gen. Gerasimov was wounded" - Google News "Gen. Gerasimov was wounded" - Google News | 41m | |
|
|
|
| Cohen Media Group Takes Ukraine Doc From Bernard-Henri Lévy for U.S. - Hollywood... |
| Cohen Media Group Takes Ukraine Doc From Bernard-Henri Lévy for U.S. Hollywood Reporter |
 "Ukraine" - Google News "Ukraine" - Google News | 42m | |
|
|
|
| Child deaths hit 'tragic milestone' in Ukraine | Department of Political ... - Department... |
| Child deaths hit 'tragic milestone' in Ukraine | Department of Political ... Department of Political... |
 "Ukraine" - Google News "Ukraine" - Google News | 42m | |
|
|
|
| Trump calls for his criminal case to be moved from Manhattan to Staten Island: 'VERY... |
| Trump calls for his criminal case to be moved from Manhattan to Staten Island: 'VERY UNFAIR!' Yahoo... |
 "special counsel jack smith" - Google News "special counsel jack smith" - Google News | 43m | |
|
|
|
| Trump to be arraigned in Manhattan in alleged hush money case - Brunswick News |
| Trump to be arraigned in Manhattan in alleged hush money case Brunswick News |
 "special counsel jack smith" - Google News "special counsel jack smith" - Google News | 43m | |
|
|
|
| U.S. Assistance Provides Critical Support to Help Ukraine Emerge ... - USAID |
| U.S. Assistance Provides Critical Support to Help Ukraine Emerge ... USAID |
 "kherson" - Google News "kherson" - Google News | 44m | |
|
|
|
| JUST IN - Biden Sends Another $2.6 Billion in Weapons to Ukraine ... - LatestLY |
| JUST IN - Biden Sends Another $2.6 Billion in Weapons to Ukraine ... LatestLY |
 "weapons for ukraine" - Google News "weapons for ukraine" - Google News | 44m | |
|
|
|
| Trump arraignment, US journalist detained by Russia, oil production ... - Yahoo Finance |
| Trump arraignment, US journalist detained by Russia, oil production ... Yahoo Finance |
 "U.S. and Russia" - Google News "U.S. and Russia" - Google News | 44m | |
|
|
|
 | |
| A rare defection from an officer in Vladimir Putin's elite security team raises questions about how deep... |
 The Associated Press (Twitter) The Associated Press (Twitter) | 44m | |
|
|
|
 | |
| George Santos, the Republican congressman facing multiple investigations into lies he told while running... |
 The Associated Press (Twitter) The Associated Press (Twitter) | 44m | |
|
|
|
| |
| Twenty-five years ago, the Good Friday Agreement halted much of the violence of Northern Ireland's Troubles.... |
 The Associated Press (Twitter) The Associated Press (Twitter) | 44m | |
|
|
|
 | |
| Republican Rep. Marjorie Taylor Greene briefly spoke to supporters of Donald Trump outside the Manhattan... |
 The Associated Press (Twitter) The Associated Press (Twitter) | 44m | |
|
|
|
| |
| The Associated Press retweeted: In a bad mood:... |
 The Associated Press (Twitter) The Associated Press (Twitter) | 44m | |
|
|
|
| |
| A plan announced last week to return Lolita, a killer whale held captive for more than a half-century,... |
 The Associated Press (Twitter) The Associated Press (Twitter) | 44m | |
|
|
|
| |
| The European Union's foreign policy chief has lashed out at China for its support of Russia amid the... |
 The Associated Press (Twitter) The Associated Press (Twitter) | 44m | |
|
|
|
 | |
| Former President Donald Trump will surrender and be arraigned on criminal charges stemming from 2016... |
 The Associated Press (Twitter) The Associated Press (Twitter) | 44m | |
|
|
|
| |
| Images captured by a robotic probe inside one of the three melted reactors at Japan's wrecked Fukushima... |
 The Associated Press (Twitter) The Associated Press (Twitter) | 44m | |
|
|
|
| |
| The Berger Action Fund is a nondescript name for a group with a rather specific purpose: steering the... |
 The Associated Press (Twitter) The Associated Press (Twitter) | 44m | |
|
|
|
| |
| Britain's privacy watchdog has hit TikTok with a multimillion-dollar penalty for misusing children's... |
 The Associated Press (Twitter) The Associated Press (Twitter) | 44m | |
|
|
|
| |
| Travis Kelce is living his best life: On the heels of winning the Super Bowl and hosting "Saturday Night... |
 The Associated Press (Twitter) The Associated Press (Twitter) | 44m | |
|
|
|
 | |
| The Associated Press retweeted: The scene outside... |
 The Associated Press (Twitter) The Associated Press (Twitter) | 44m | |
|
|
|
| |
| The Associated Press retweeted: Bayleef it... |
 The Associated Press (Twitter) The Associated Press (Twitter) | 44m | |
|
|
|
| |
| A U.S. military laboratory has helped Swedes confirm that a woman was on a 17th century warship that... |
 The Associated Press (Twitter) The Associated Press (Twitter) | 44m | |
|
|
|
 | Elon Musk loses his position atop Forbes' annual billionaires list |
| Elon Musk has officially been dethroned from the top of Forbes' annual "World's Billionaire's List." |
 CNN.com - Top Stories CNN.com - Top Stories | 46m | |
|
|
|
 | Video: 'You can't make this up.' The dramatic history within Trump's legal team |
| |
 CNN.com - Top Stories CNN.com - Top Stories | 46m | |
|
|
|
 | Austin and Seattle among fastest-cooling areas for home prices. See where it's hot |
| CNN's Chief Business Correspondent Christine Romans explains divergent trends in the US housing market,... |
 CNN.com - Top Stories CNN.com - Top Stories | 46m | |
|
|
|
 | This Secret to the Best Buttery Chicken Breasts Are Already in Your Pantry |
| Take it easy for dinner tonight with this delicious meal that's ready in a flash. Ritz cracker chicken... |
 The Epoch Times | The Epoch Times The Epoch Times | The Epoch Times | 46m | |
|
|
|
 | Shen Yun 'Made Me Very Happy and Very Touched,' Says Former Canadian MP |
| TORONTO, Canada—Chungsen Leung, a former member of the Canadian Parliament, attended Shen Yun's evening... |
 The Epoch Times | The Epoch Times The Epoch Times | The Epoch Times | 46m | |
|
|
|
 | Tennessee Lawmakers Face Expulsion After Joining Pro-Gun Control Protest at State... |
| Three Democratic lawmakers in the Tennessee House of Representatives who took part in pro-gun control... |
 The Epoch Times | The Epoch Times The Epoch Times | The Epoch Times | 46m | |
|
|
|
 | @mikenov: #VladlenTatarsky #GRU #RussianGenerals | Was Vladlen Tatarsky liquidated... |
| Selected Articles - Michael Novakhov's favorite articles on Inoreader - The News And TimesWas Vladlen... |
 The News And Times The News And Times | 46m | |
|
|
|
 | Joe Biden Just Won't Stop Lying to America |
| The president again talked about how the wealthy must pay more in taxes, bringing up questionable numbers... |
 19FortyFive 19FortyFive | 47m | |
|
|
|
 | 'You Don't Deserve to Be President': Nikki Haley Tells Joe Biden From Southern Border |
| Nikki Haley, former U.N. ambassador and South Carolina governor, visited the nation's southern border... |
 19FortyFive 19FortyFive | 47m | |
|
|
|
 | Terror convict back in prison after meetings with Lindh |
| This booking photo provided by Alexandria Sheriff's Office shows Ali Shukri Amin. Amin, convicted on... |
 Associated Press News: Breaking News | Latest News Today Associated Press News: Breaking News | Latest News Today | 50m | |
|
|
|
 | Biden to host NCAA champs UConn, LSU; doesn't mention Iowa |
| WASHINGTON (AP) — President Joe Biden said Tuesday that he looks forward to hosting the NCAA men's and... |
 Associated Press News: Breaking News | Latest News Today Associated Press News: Breaking News | Latest News Today | 50m | |
|
|
|
| Russian fighter jets are reportedly ambushing Ukrainian pilots in ... - msnNOW |
| Russian fighter jets are reportedly ambushing Ukrainian pilots in ... msnNOW |
 "Air Superiority Over Ukraine" - Google News "Air Superiority Over Ukraine" - Google News | 51m | |
|
|
|
| Ukraine Will Join NATO - NATO Secretary General Stoltenberg Vows - Tori.ng |
| Ukraine Will Join NATO - NATO Secretary General Stoltenberg Vows Tori.ng |
 "Stoltenberg" - Google News "Stoltenberg" - Google News | 53m | |
|
|
|
| U.S. computer chip controls threaten China's tech ambitions - PBS NewsHour |
| U.S. computer chip controls threaten China's tech ambitions PBS NewsHour |
 "global threats to U.S. security" - Google News "global threats to U.S. security" - Google News | 53m | |
|
|
|
| Jailed WSJ Reporter Appeals Arrest in Russia on Spying Claims - The Moscow Times |
| Jailed WSJ Reporter Appeals Arrest in Russia on Spying Claims The Moscow Times |
 "shoigu" - Google News "shoigu" - Google News | 54m | |
|
|
|
 | AP Headline News - Apr 04 2023 12:00 (EDT) |
| |
 Associated Press Bulletins Associated Press Bulletins | 54m | |
|
|
|
| Live: Facebook, Twitter and Virgin Media all down as users report issues - Devon... |
| Live: Facebook, Twitter and Virgin Media all down as users report issues Devon Live |
 "twitter down" - Google News "twitter down" - Google News | 56m | |
|
|
|
| Elon Musk's obsession with blue checks is a verified problem - The Verge |
| Elon Musk's obsession with blue checks is a verified problem The Verge |
 "twitter down" - Google News "twitter down" - Google News | 56m | |
|
|
|
| India's average crude oil imports from Russia at 1 million barrels/day in FY23 -... |
| India's average crude oil imports from Russia at 1 million barrels/day in FY23 BusinessLine |
 "g-7 2022" - Google News "g-7 2022" - Google News | 57m | |
|
|
|
| What does hypersonic missile arms race mean for Israeli security? - The Jerusalem... |
| What does hypersonic missile arms race mean for Israeli security? The Jerusalem Post |
 "Israel and Russia- Ukraine war 2022" - Google News "Israel and Russia- Ukraine war 2022" - Google News | 57m | |
|
|
|
| Will Ukraine Target Russian War Criminals After the Invasion? - SOFREP |
| Will Ukraine Target Russian War Criminals After the Invasion? SOFREP |
 "Israel and Russia- Ukraine war 2022" - Google News "Israel and Russia- Ukraine war 2022" - Google News | 57m | |
|
|
|
| Anti-war officer from Putin's elite security team defects - The Associated Press |
| Anti-war officer from Putin's elite security team defects The Associated Press |
 "russia-ukraine war 2022" - Google News "russia-ukraine war 2022" - Google News | 58m | |
|
|
|
| Marjorie Taylor Greene Appears at Trump Rally Outside NYC Court - The New York Times |
| Marjorie Taylor Greene Appears at Trump Rally Outside NYC Court The New York Times |
 trump - Google News trump - Google News | 58m | |
|
|
|
| Trump arraignment live: Indicted ex-president to appear in court ... - Al Jazeera... |
| Trump arraignment live: Indicted ex-president to appear in court ... Al Jazeera English |
 trump - Google News trump - Google News | 58m | |
|
|
|
| President Trump, Health Care, and Gwyneth Paltrow - theSkimm |
| President Trump, Health Care, and Gwyneth Paltrow theSkimm |
 trump - Google News trump - Google News | 58m | |
|
|
|
| Ukraine-Russia war: Putin sacks top general over disastrous failed ... - msnNOW |
| Ukraine-Russia war: Putin sacks top general over disastrous failed ... msnNOW |
 "Russia - China new strategic alliance by Putin and Xi" - Google News "Russia - China new strategic alliance by Putin and Xi" - Google News | 1h | |
|
|
|
| Robert De Niro To Star In Crime Drama Series 'Bobby Meritorious' In The Works At... |
| Robert De Niro To Star In Crime Drama Series 'Bobby Meritorious' In The Works At Paramount+ From Billy... |
 "James Comey" - Google News "James Comey" - Google News | 1h | |
|
|
|
| FM Dendias Speaks with UNESCO Director-General Azoulay about ... - The National Herald |
| FM Dendias Speaks with UNESCO Director-General Azoulay about ... The National Herald |
 "Odessa" - Google News "Odessa" - Google News | 1h | |
|
|
|
 | Chiefs' Travis Kelce to host music festival in Kansas City |
| LOS ANGELES (AP) — Travis Kelce is living his best life: On the heels of winning the Super Bowl and hosting... |
 Associated Press News: Breaking News | Latest News Today Associated Press News: Breaking News | Latest News Today | 1h | |
|
|
|
 | Dimon: Bank rules should change after Silicon Valley Bank |
| NEW YORK (AP) — JPMorgan's Jamie Dimon told investors Tuesday that government and banks should work to... |
 Associated Press News: Breaking News | Latest News Today Associated Press News: Breaking News | Latest News Today | 1h | |
|
|
|
 | Masters only big show in town as other tours take week off |
| AUGUSTA NATIONAL GOLF CLUBSite: Augusta, Georgia.Course: Augusta National GC. Yardage: 7,545. Par: 72.Prize... |
 Associated Press News: Breaking News | Latest News Today Associated Press News: Breaking News | Latest News Today | 1h | |
|
|
|
| Trump NYC protests: Small group of former president's supporters, foes face off ahead... |
| Trump NYC protests: Small group of former president's supporters, foes face off ahead of court appearance ABC... |
 "George Santos" - Google News "George Santos" - Google News | 1h | |
|
|
|
| Rep George Santos spotted outside of Manhattan court amid Trump arraignment, says... |
| Rep George Santos spotted outside of Manhattan court amid Trump arraignment, says he is out to 'support'... |
 "George Santos" - Google News "George Santos" - Google News | 1h | |
|
|
|
| MTG Flees Her Own Trump Arrest Protest as Hecklers Drown Her Out - Rolling Stone |
| MTG Flees Her Own Trump Arrest Protest as Hecklers Drown Her Out Rolling StoneTrump arraignment: MTG,... |
 "George Santos" - Google News "George Santos" - Google News | 1h | |
|
|
|
| Circus underway: Marjorie Taylor Greene, George Santos home in on Trump indictment... |
| Circus underway: Marjorie Taylor Greene, George Santos home in on Trump indictment POLITICO |
 "George Santos" - Google News "George Santos" - Google News | 1h | |
|
|
|
| Circus underway: Marjorie Taylor Greene, George Santos home in on Trump indictment... |
| Circus underway: Marjorie Taylor Greene, George Santos home in on Trump indictment Yahoo News |
 "George Santos" - Google News "George Santos" - Google News | 1h | |
|
|
|
| Live updates: Donald Trump set for historic arraignment - Kenosha News |
| Live updates: Donald Trump set for historic arraignment Kenosha News |
 "George Santos" - Google News "George Santos" - Google News | 1h | |
|
|
|
| Trump arraignment: MTG, George Santos appear in Manhattan - Axios |
| Trump arraignment: MTG, George Santos appear in Manhattan Axios |
 "George Santos" - Google News "George Santos" - Google News | 1h | |
|
|
|
 | US details plan to draw clean energy into oil, coal communities |
| 2023-04-04T15:35:50ZA pile of coal in an active coal mine located next to a new solar power plant development... |
 Reuters Reuters | 1h | |
|
|
|
 | Dogecoin jumps as Musk"s Twitter flips logo to Shiba Inu dog |
| 2023-04-04T15:28:11ZDogecoin's Shiba Inu dog replaced Twitter's blue bird as the social media company's... |
 Reuters Reuters | 1h | |
|
|
|
 | SNAPSHOT S&P 500, Nasdaq rise as economic data eases rate hike worries |
| 2023-04-04T15:29:27ZTraders work on the floor of the New York Stock Exchange (NYSE) in New York City,... |
 Reuters Reuters | 1h | |
|
|
|
 | Study explains how primordial life survived on "Snowball Earth" |
| 2023-04-04T15:50:01ZAn illustration shows Earth during the Marinoan Ice Age, 651–635 million years ago,... |
 Reuters Reuters | 1h | |
|
|
|
 | Traders up bets Fed won"t hike rates in May, cuts to begin in summer |
| 2023-04-04T15:50:39ZThe U.S. Federal Reserve building is pictured in Washington, March 18, 2008. REUTERS/Jason... |
 Reuters Reuters | 1h | |
|
|
|
| Russian intelligence head claims situation in Ukraine has taken ... - Anadolu Agency... |
| Russian intelligence head claims situation in Ukraine has taken ... Anadolu Agency | English |
 "kyiv" - Google News "kyiv" - Google News | 1h | |
|
|
|
| Monoclonal Antibody Treatments Cut COVID Hospitalizations ... - Cedar Valley Daily... |
| Monoclonal Antibody Treatments Cut COVID Hospitalizations ... Cedar Valley Daily Times |
 "COVID" - Google News "COVID" - Google News | 1h | |
|
|
|
| Reminder: COVID-19 updates coming tomorrow, April 5 – Michigan ... - Michigan Medicine... |
| Reminder: COVID-19 updates coming tomorrow, April 5 – Michigan ... Michigan Medicine Headlines |
 "COVID" - Google News "COVID" - Google News | 1h | |
|
|
|
 | In Pictures: Scenes Outside New York Court Prior to Donald Trump's Arraignment |
| Protesters outside the New York County Supreme Court ahead of former President Donald Trump's arraignment... |
 The Epoch Times | The Epoch Times The Epoch Times | The Epoch Times | 1h | |
|
|
|
 | Vaping Can Be More Damaging Than Smoking Cigarettes, Study Finds |
| Vaping can cause more damage to DNA compared to smoking regular cigarettes, according to a new study... |
 The Epoch Times | The Epoch Times The Epoch Times | The Epoch Times | 1h | |
|
|
|
 | Update Windows Now to Avoid Potentially Exposing Account Details |
| Microsoft has released an emergency security update for Windows 10 and Windows 11, according to a new... |
 The Epoch Times | The Epoch Times The Epoch Times | The Epoch Times | 1h | |
|
|
|
 | Book Review: 'Raising Victims: The Pernicious Rise of Critical Race Theory' |
| Leonydus Johnson book's "Raising Victims: The Pernicious Rise of Critical Race Theory" is a good salve... |
 The Epoch Times | The Epoch Times The Epoch Times | The Epoch Times | 1h | |
|
|
|
 | China's Dual-Use Moon Ambitions |
| Commentary It appears that a 2022 agreement between China and the United Arab Emirates (UAE) to have... |
 The Epoch Times | The Epoch Times The Epoch Times | The Epoch Times | 1h | |
|
|
|
 | Police Say Missing Akwesasne Man Tied to Migrants Found Dead in St Lawrence River |
| Authorities investigating the disappearance of an Akwesasne man whose boat was found near the bodies... |
 The Epoch Times | The Epoch Times The Epoch Times | The Epoch Times | 1h | |
|
|
|
 | LIVE 12 PM ET: Marjorie Taylor Greene Leads Protest Near Manhattan Courthouse |
| Rep. Marjorie Taylor Greene (R-Ga.) will lead a pro-Trump protest at a park near the Manhattan courthouse... |
 The Epoch Times | The Epoch Times The Epoch Times | The Epoch Times | 1h | |
|
|
|
 | Quebec Shipyard Formally Added to Federal Shipbuilding Plan After Lobbying, Delays |
| Ottawa and Quebec shipyard Chantier Davie finally have a deal, after years of lobbying followed by years... |
 The Epoch Times | The Epoch Times The Epoch Times | The Epoch Times | 1h | |
|
|
|
 | DNA Test Results From Woman Claiming to Be Madeleine McCann Revealed |
| A Polish woman who has claimed to be missing British girl Madeleine McCann is not the same person who... |
 The Epoch Times | The Epoch Times The Epoch Times | The Epoch Times | 1h | |
|
|
|
 | Afghan Taliban Raid Kills 6 Members of ISIS |
| ISLAMABAD—An overnight raid by Taliban members in Afghanistan's northern Balkh Province killed six members... |
 The Epoch Times | The Epoch Times The Epoch Times | The Epoch Times | 1h | |
|
|
|
 | Best Exercise for Weight Loss? |
| Is aerobic exercise or strength training better for weight loss or do you have to do both? I really want... |
 The Epoch Times | The Epoch Times The Epoch Times | The Epoch Times | 1h | |
|
|
|
 | Major UK Airport Scraps Security Rules on Liquids and Electronics |
| The UK's first major airport has scrapped security protocols on liquids and electronics. London City... |
 The Epoch Times | The Epoch Times The Epoch Times | The Epoch Times | 1h | |
|
|
|
| The Retail Market Size Is Expected To Grow At An Annual Rate Of ... - GlobeNewswire |
| The Retail Market Size Is Expected To Grow At An Annual Rate Of ... GlobeNewswire |
 "Intelligence Assessments of Russia Ukraine War 2022" - Google News "Intelligence Assessments of Russia Ukraine War 2022" - Google News | 1h | |
|
|
|
| Grassroots faith leaders navigate a Northern Ireland in flux |
| |
 All Stories All Stories | 1h | |
|
|
|
| Suspect in Farmington-area school threats is in police custody |
| |
 All Stories All Stories | 1h | |
|
|
|
| Anti-war officer from Putin's elite security team defects |
| |
 All Stories All Stories | 1h | |
|
|
|
| Terror convict back in prison after meetings with Lindh |
| |
 All Stories All Stories | 1h | |
|
|
|
| Adviser to Lula met Putin to discuss peace talks for Ukraine - Buenos Aires Times |
| Adviser to Lula met Putin to discuss peace talks for Ukraine Buenos Aires Times |
 "Putin in Beijing" - Google News "Putin in Beijing" - Google News | 1h | |
|
|
|
| The Taylor Sheridan Effect Is Impacting Everything from Production Incentives to... |
| The Taylor Sheridan Effect Is Impacting Everything from Production Incentives to Headshots IndieWire |
 "Tulsa shooting" - Google News "Tulsa shooting" - Google News | 1h | |
|
|
|
| Santos appears outside Manhattan court ahead of Trump arraignment - Yahoo News |
| Santos appears outside Manhattan court ahead of Trump arraignment Yahoo News |
 "FBI AND ITS ROLE IN ELECTION 2016" - Google News "FBI AND ITS ROLE IN ELECTION 2016" - Google News | 1h | |
|
|
|
| Paranoid Putin personally ordered blogger’s assassination & will use it to... |
| Paranoid Putin personally ordered blogger's assassination & will use it to crush rivals, claim Kremlin... |
 "Is Putin MAD?" - Google News "Is Putin MAD?" - Google News | 1h | |
|
|
|
| Ukrainian Security Chief's View: Russia Will Collapse Within 3-7 years - Kyiv Post |
| Ukrainian Security Chief's View: Russia Will Collapse Within 3-7 years Kyiv Post |
 "Putin and Xi Jinping" - Google News "Putin and Xi Jinping" - Google News | 1h | |
|
|
|
| Webby Award nominations for Harry Styles, Lizzo, Post Malone |
| AP correspondent Margie Szaroleta reports on Webby Awards-Nominations. |
 AP Audio Wire AP Audio Wire | 1h | |
|
|
|
| How to break the Xi-Putin axis? Biden must engage with Beijing - The Guardian |
| How to break the Xi-Putin axis? Biden must engage with Beijing The Guardian |
 "Putin and Xi" - Google News "Putin and Xi" - Google News | 1h | |
|
|
|
| Biden Administration Announces Additional Security Assistance for ... - Department... |
| Biden Administration Announces Additional Security Assistance for ... Department of Defense |
 "Ukraine" - Google News "Ukraine" - Google News | 1h | |
|
|
|
| Ukraine war: Battle for Bakhmut 'stabilising', says commander - BBC |
| Ukraine war: Battle for Bakhmut 'stabilising', says commander BBC |
 "russia-ukraine war" - Google News "russia-ukraine war" - Google News | 1h | |
|
|
|
 | What We Know About the Bomb Attack on a Russian Pro-War Blogger |
| The killing of Vladlen Tatarsky came at a volatile moment in Russia, and could herald a further crackdown... |
 NYT > Russia-Ukraine War NYT > Russia-Ukraine War | 1h | |
|
|
|
| French President Emmanuel Macron heads to China for delicate talks on Ukraine, trade... |
| French President Emmanuel Macron heads to China for delicate talks on Ukraine, trade Washington Times |
 "Russia Ukraine peace talks" - Google News "Russia Ukraine peace talks" - Google News | 1h | |
|
|
|
| Tuesday, 4 April '23 | Institute for War and Peace Reporting - Institute for War... |
| Tuesday, 4 April '23 | Institute for War and Peace Reporting Institute for War & Peace Reporting... |
 "kherson" - Google News "kherson" - Google News | 1h | |
|
|
|
 | 'Significant Portion' of UK Lethal Aid for Ukraine Stays Secret - Consortium News |
| Consortium News |
 "weapons for ukraine" - Google News "weapons for ukraine" - Google News | 1h | |
|
|
|
| Kyiv Post Daily Thread – The Latest News From and About Ukraine ... - Kyiv Post |
| Kyiv Post Daily Thread – The Latest News From and About Ukraine ... Kyiv Post |
 "G7 and Russia Ukraine war" - Google News "G7 and Russia Ukraine war" - Google News | 1h | |
|
|
|
| Zelensky Says Ukraine 'Will Never Forgive' on Bucha Anniversary - Kyiv Post |
| Zelensky Says Ukraine 'Will Never Forgive' on Bucha Anniversary Kyiv Post |
 "Bucha" - Google News "Bucha" - Google News | 1h | |
|
|
|
 | Could the U.S. Ban Guns? Australia Tried Something Pretty Close |
| This doesn't mean we should ignore the problem in America, but a gun confiscation and buyback that worked... |
 19FortyFive 19FortyFive | 1h | |
|
|
|
 | P-75 Eagle: The Worst Fighter Aircraft of World War II? |
| The Eagle was redesigned with a new tail assembly and a bubble canopy was added. The engine was even... |
 19FortyFive 19FortyFive | 1h | |
|
|
|
 | DNA: Woman was on famed 17th century Swedish warship |
| COPENHAGEN, Denmark (AP) — A U.S. military laboratory has helped Swedes confirm what was suspected for... |
 Associated Press News: Breaking News | Latest News Today Associated Press News: Breaking News | Latest News Today | 1h | |
|
|
|
 | Feb job openings slip to 9.9M; a win in inflation fight? |
| WASHINGTON (AP) — U.S. job openings slipped to 9.9 million in February, fewest since May 2021 and a sign... |
 Associated Press News: Breaking News | Latest News Today Associated Press News: Breaking News | Latest News Today | 1h | |
|
|
|
| Putin triggered 'historic" Nordic enlargement of NATO with Ukraine war -Stoltenberg... |
| Putin triggered 'historic" Nordic enlargement of NATO with Ukraine war -Stoltenberg Yahoo Finance |
 "Stoltenberg" - Google News "Stoltenberg" - Google News | 1h | |
|
|
|
| Belarus receives aircraft and Iskander missiles capable of delivering nuclear strikes... |
| Belarus receives aircraft and Iskander missiles capable of delivering nuclear strikes – Russian Defence... |
 "shoigu" - Google News "shoigu" - Google News | 1h | |
|
|
|
| AP News Summary at 10:09 a.m. EDT - FOX 28 Spokane |
| AP News Summary at 10:09 a.m. EDT FOX 28 Spokane |
 "FBI and election 2016" - Google News "FBI and election 2016" - Google News | 1h | |
|
|
|
| NCAA championship win spurs celebration, destruction at UConn - ESPN.co.uk |
| NCAA championship win spurs celebration, destruction at UConn ESPN.co.uk |
 "twitter down" - Google News "twitter down" - Google News | 1h | |
|
|
|
| Record flows of Russian diesel to Mideast boost exports to Europe ... - Reuters |
| Record flows of Russian diesel to Mideast boost exports to Europe ... Reuters |
 "g-7 2022" - Google News "g-7 2022" - Google News | 1h | |
|
|
|
| Khloe Kardashian's Ex Tristan Thompson Seen At True's Birthday ... - Radar Online |
| Khloe Kardashian's Ex Tristan Thompson Seen At True's Birthday ... Radar Online |
 "Is Putin ill with blood cancer?" - Google News "Is Putin ill with blood cancer?" - Google News | 1h | |
|
|
|
| 'He's a war criminal': Elite Putin security officer defects - The Associated Press |
| 'He's a war criminal': Elite Putin security officer defects The Associated Press |
 "russia-ukraine war 2022" - Google News "russia-ukraine war 2022" - Google News | 1h | |
|
|
|
| Global Electric Resistance Welded (ERW) Pipes and Tubes ... - GlobeNewswire |
| Global Electric Resistance Welded (ERW) Pipes and Tubes ... GlobeNewswire |
 "russia-ukraine war 2022" - Google News "russia-ukraine war 2022" - Google News | 1h | |
|
|
|
| Pro- and Anti-Trump Demonstrators Converge Outside NY Court - The New York Times |
| Pro- and Anti-Trump Demonstrators Converge Outside NY Court The New York Times |
 trump - Google News trump - Google News | 1h | |
|
|
|
| Live updates: Trump makes appearance in New York court following grand jury indictment... |
| Live updates: Trump makes appearance in New York court following grand jury indictment CNN International |
 trump - Google News trump - Google News | 1h | |
|
|
|
| Trump lawyer Joe Tacopina warns that we might be on the 'eve of destruction' the... |
| Trump lawyer Joe Tacopina warns that we might be on the 'eve of destruction' the night before Trump's... |
 trump - Google News trump - Google News | 1h | |
|
|
|
| Pope Francis Accepts Resignation of Archbishop Michael Jackels of ... - USCCB |
| Pope Francis Accepts Resignation of Archbishop Michael Jackels of ... USCCB |
 "pope francis" - Google News "pope francis" - Google News | 1h | |
|
|
|
| Glencore's bid for Teck Resources revives animal spirits in race for copper |
| Mining M&A is back with copper driving deals as cash-rich companies anticipate shortfall of the metal... |
 Markets and Business News Review Markets and Business News Review | 1h | |
|
|
|
 | Global Luxury Brands Ready For A U.S. Retail Resurgence |
| To capture market share, luxury brands are expanding retail space and capitalizing on their experiential... |
 Markets and Business News Review Markets and Business News Review | 1h | |
|
|
|
 | Why Trump May Not Get A Mugshot—And When We Might See It If He Does |
| New York State Law Limits Who Can See Booking Photos |
 Markets and Business News Review Markets and Business News Review | 1h | |
|
|
|
| Gupta's Wyelands Bank censured by BoE for regulatory failings |
| Lender criticised for over-reliance on companies related to steel magnate's now struggling empire |
 Markets and Business News Review Markets and Business News Review | 1h | |
|
|
|
 | Forbes Announces Eighth Annual List Of America's Top Wealth Advisors |
| Forbes Announces Eighth Annual List Of America's Top Wealth Advisors |
 Markets and Business News Review Markets and Business News Review | 1h | |
|
|
|
 | Chelsea FC In Danger Of Becoming A Poisoned Chalice |
| Former Chelsea FC manager Thomas Tuchel had every reason for a wry smile when asked about the fortunes... |
 Markets and Business News Review Markets and Business News Review | 1h | |
|
|
|
 | Bill Gates Rejects 'Pause' On AI, Suggesting It's Impractical |
| Last week more than 1,000 AI experts asked to pause the development of some AI systems. |
 Markets and Business News Review Markets and Business News Review | 1h | |
|
|
|
 | A New Raspberry Flavor For Your Tastebuds: Brought To You By Fermentation |
| Raspberries, anyone? Delivering on the synbio industry's promise, Insempra has launched its first functional... |
 Markets and Business News Review Markets and Business News Review | 1h | |
|
|
|
 | Virgin Orbit Collapses, Laying Off 700 Jobs And Marking A Turning Point In The Private... |
| Virgin Orbit, Virgin's satellite transport business, has filed for bankruptcy and put itself up for sale. |
 Markets and Business News Review Markets and Business News Review | 1h | |
|
|
|
 | On, The $1 Billion Swiss Running-Shoe Company, Declares Cyclon Its Sustainability... |
| On is challenging the athletic footwear industry to become truly sustainable and circular. It is leading... |
 Markets and Business News Review Markets and Business News Review | 1h | |
|
|
|
 | Journalism With Impact |
| The old saw has it that there are two types of writers: those who work to please themselves, and those... |
 Markets and Business News Review Markets and Business News Review | 1h | |
|
|
|
 | Trump Faces 34 Felony Counts For Falsifying Records, Report Says |
| A spokesperson for the former president said his legal team had not been briefed on the charges. |
 Markets and Business News Review Markets and Business News Review | 1h | |
|
|
|
| In Photos: Orthodox Believers, Pro-Ukrainian Protesters Stand Off at Historic Kyiv... |
| In Photos: Orthodox Believers, Pro-Ukrainian Protesters Stand Off at Historic Kyiv Monastery The Moscow... |
 "kyiv" - Google News "kyiv" - Google News | 1h | |
|
|
|
| Contact Us: - Latest Tweet by The Kyiv Independent - LatestLY |
| Contact Us: - Latest Tweet by The Kyiv Independent LatestLY |
 "kyiv" - Google News "kyiv" - Google News | 1h | |
|
|
|
| The Economic Prospects of the Transnistrian Peace Settlement after ... - Georgetown... |
| The Economic Prospects of the Transnistrian Peace Settlement after ... Georgetown Journal of International... |
 "russia - ukraine war 2022" - Google News "russia - ukraine war 2022" - Google News | 1h | |
|
|
|
 | For many Palestinian citizens of Israel, judicial battle leaves them out |
| 2023-04-04T15:17:20ZA man holds an Israeli flag as he stands in front of a large picture of Israeli Prime... |
 Reuters Reuters | 1h | |
|
|
|
 | Credit Suisse chairman "truly sorry" as anger grows |
| 2023-04-04T15:11:06ZCredit Suisse's chairman (CSGN.S) apologised for taking the bank to the brink of... |
 Reuters Reuters | 1h | |
|
|
|
| Trump Protest Outside NYC Arraignment Attracts MTG, George Santos - NBC New York |
| Trump Protest Outside NYC Arraignment Attracts MTG, George Santos NBC New York |
 "George Santos" - Google News "George Santos" - Google News | 1h | |
|
|
|
| Rep. George Santos tells Trump to 'stay strong' - NBC News |
| Rep. George Santos tells Trump to 'stay strong' NBC News |
 "George Santos" - Google News "George Santos" - Google News | 1h | |
|
|
|
| Video NYPD enhances security ahead of Trump's expected arrival at arraignment - ABC... |
| Video NYPD enhances security ahead of Trump's expected arrival at arraignment ABC News |
 "George Santos" - Google News "George Santos" - Google News | 1h | |
|
|
|
| Santos appears outside Manhattan court ahead of Trump arraignment - The Hill |
| Santos appears outside Manhattan court ahead of Trump arraignment The HillTrump arraignment: MTG, George... |
 "George Santos" - Google News "George Santos" - Google News | 1h | |
|
|
|
| Live updates: Donald Trump set for historic arraignment - Channel3000.com - WISC-TV3 |
| Live updates: Donald Trump set for historic arraignment Channel3000.com - WISC-TV3 |
 "George Santos" - Google News "George Santos" - Google News | 1h | |
|
|
|
| Live updates: Donald Trump set for historic arraignment - WCF Courier |
| Live updates: Donald Trump set for historic arraignment WCF Courier |
 "George Santos" - Google News "George Santos" - Google News | 1h | |
|
|
|
| George Santos mocked as he appears at Trump arraignment rally - The Independent |
| George Santos mocked as he appears at Trump arraignment rally The Independent |
 "George Santos" - Google News "George Santos" - Google News | 1h | |
|
|
|
| From Warzone to Fusion Power: Breakthrough in Cooking Up ... - SciTechDaily |
| From Warzone to Fusion Power: Breakthrough in Cooking Up ... SciTechDaily |
 "kharkiv" - Google News "kharkiv" - Google News | 1h | |
|
|
|
| SBU: Moscow Patriarchate official blessed Russian soldiers during occupation of Kharkiv... |
| SBU: Moscow Patriarchate official blessed Russian soldiers during occupation of Kharkiv Oblast Yahoo... |
 "kharkiv" - Google News "kharkiv" - Google News | 1h | |
|
|
|
| University facing class-action over COVID campus lockdown - WGN TV Chicago |
| University facing class-action over COVID campus lockdown WGN TV Chicago |
 "COVID" - Google News "COVID" - Google News | 1h | |
|
|
|
| Covid Vax Beats Infection for Revving Up Killer T Cells - Nextgov |
| Covid Vax Beats Infection for Revving Up Killer T Cells Nextgov |
 "COVID" - Google News "COVID" - Google News | 1h | |
|
|
|
| Biodegradable Plastics Market to Touch USD 58.11 Billion by 2030 ... - GlobeNewswire |
| Biodegradable Plastics Market to Touch USD 58.11 Billion by 2030 ... GlobeNewswire |
 "Intelligence Assessments of Russia Ukraine War 2022" - Google News "Intelligence Assessments of Russia Ukraine War 2022" - Google News | 1h | |
|
|
|
| Industrial Energy Management System Market Growth 2022 to 2031, Global Industry Size,... |
| Industrial Energy Management System Market Growth 2022 to 2031, Global Industry Size, Recent Trends,... |
 "Intelligence Assessments of Russia Ukraine War 2022" - Google News "Intelligence Assessments of Russia Ukraine War 2022" - Google News | 1h | |
|
|
|
| 'He's a war criminal': Elite Putin security officer defects |
| |
 All Stories All Stories | 1h | |
|
|
|
| Ukraine war: Who are Russia's war bloggers and why are they popular? - bbc.com |
| Ukraine war: Who are Russia's war bloggers and why are they popular? bbc.comThe Latest: War in Ukraine:... |
 "russia-ukraine war news" - Google News "russia-ukraine war news" - Google News | 1h | |
|
|
|
| Finland joins NATO, dealing blow to Russia for Ukraine war - The Indian Express |
| Finland joins NATO, dealing blow to Russia for Ukraine war The Indian Express |
 "russia-ukraine war news" - Google News "russia-ukraine war news" - Google News | 1h | |
|
|
|
| To Walk the Earth in Safety (2023) - United States Department of State - Department... |
| To Walk the Earth in Safety (2023) - United States Department of State Department of State |
 "global threats to U.S. security 2023" - Google News "global threats to U.S. security 2023" - Google News | 1h | |
|
|
|
| Special counsel in classified documents investigation secures new evidence - CNN |
| Special counsel in classified documents investigation secures new evidence CNN |
 "Mar-a-Lago" - Google News "Mar-a-Lago" - Google News | 1h | |
|
|
|
| Nine General Lee's Up There – 105.7 The Point - 105.7 The Point |
| Nine General Lee's Up There – 105.7 The Point 105.7 The Point |
 "aggressive rats in new york city" - Google News "aggressive rats in new york city" - Google News | 1h | |
|
|
|
| Trump investigations: What to know about 4 criminal probes in New York, Georgia and... |
| Trump investigations: What to know about 4 criminal probes in New York, Georgia and by special counsel CBS... |
 "FBI AND ITS ROLE IN ELECTION 2016" - Google News "FBI AND ITS ROLE IN ELECTION 2016" - Google News | 1h | |
|
|
|
| More Republicans Support Stricter Gun Laws After Nashville Shooting - Morning Consult |
| More Republicans Support Stricter Gun Laws After Nashville Shooting Morning Consult |
 "Uvalde" - Google News "Uvalde" - Google News | 1h | |
|
|
|
 | King visits Netherlands train crash site |
| (4 Apr 2023) King visits Netherlands train crash site Subscribe for more Breaking News: http://smarturl.it/AssociatedPress... |
 Associated Press Associated Press | 1h | |
|
|
|
| Ukrainian official offers plan for a Crimea without Russia - The Independent |
| Ukrainian official offers plan for a Crimea without Russia The Independent |
 "russia-ukraine war" - Google News "russia-ukraine war" - Google News | 1h | |
|
|
|
| Your Wednesday Briefing: China, Japan Divided on Ukraine - The New York Times |
| Your Wednesday Briefing: China, Japan Divided on Ukraine The New York Times |
 "Russia Ukraine peace talks" - Google News "Russia Ukraine peace talks" - Google News | 1h | |
|
|
|
| Trump asks appeals court for emergency order blocking testimony from top aides in... |
| Trump asks appeals court for emergency order blocking testimony from top aides in DOJ's Jan. 6 probe CNN |
 "special counsel jack smith" - Google News "special counsel jack smith" - Google News | 1h | |
|
|
|
| Learning to Squeeze Russia's Energy Revenues by Simon Johnson ... - Project Syndicate |
| Learning to Squeeze Russia's Energy Revenues by Simon Johnson ... Project Syndicate |
 "G7 and Russia Ukraine war" - Google News "G7 and Russia Ukraine war" - Google News | 1h | |
|
|
|
| G20 Sherpa meeting: Some nations pull up G7 over global banking crisis - Business... |
| G20 Sherpa meeting: Some nations pull up G7 over global banking crisis Business Standard |
 "G7 and Russia Ukraine war" - Google News "G7 and Russia Ukraine war" - Google News | 1h | |
|
|
|
 | |
| Because of our historic investments, companies across America are expanding factories and building new... |
 President Biden (Twitter) President Biden (Twitter) | 1h | |
|
|
|
| Finland joins NATO in major blow to Russia over Ukraine war |
| AP correspondent Charles de Ledesma reports on NATO Finland-Ceremony. |
 AP Audio Wire AP Audio Wire | 1h | |
|
|
|
 | Russia Might Have Lost Over 100 Nuclear Weapons |
| The Nuclear Threat Initiative (NTI) also published a report in September 1997 that quoted former Russian... |
 19FortyFive 19FortyFive | 1h | |
|
|
|
 | Paris Gun: The Longest Range Artillery Weapon Ever |
| Years back, the U.S. Army tested its Extended Range Cannon Artillery System, or ERCA, at the Yuma Proving... |
 19FortyFive 19FortyFive | 1h | |
|
|
|
 | Guns of Star Wars: Just Dressed Up World War II Guns? |
| It may have been set in a galaxy far, far away but the Star Wars films feature some rather familiar looking... |
 19FortyFive 19FortyFive | 1h | |
|
|
|
 | GAU-8 Avenger: The Monster Cannon That Powers the A-10 Warthog |
| The GAU-8 Avenger is one impressive weapon system and the foundation of the A-10 Warthog, despite its... |
 19FortyFive 19FortyFive | 1h | |
|
|
|
 | Panzer Killers: 5 Best Anti-Tank Weapons of World War II |
| The Second World War saw significant advances in tanks, and throughout the war, all of the major powers... |
 19FortyFive 19FortyFive | 1h | |
|
|
|
 | 5 Most Dangerous Sniper Rifles of All Time |
| A tool is only as useful as the person who uses it, and when it comes to military small arms a weapon... |
 19FortyFive 19FortyFive | 1h | |
|
|
|
| U.S. Government and Jordan Armed Forces Jointly Participate in ... - DVIDS |
| U.S. Government and Jordan Armed Forces Jointly Participate in ... DVIDS |
 "global threats to U.S. security" - Google News "global threats to U.S. security" - Google News | 1h | |
|
|
|
 | AP Headline News - Apr 04 2023 11:00 (EDT) |
| |
 Associated Press Bulletins Associated Press Bulletins | 1h | |
|
|
|
| Apple's Weather app briefly went down and rained on everyone's morning - CNN |
| Apple's Weather app briefly went down and rained on everyone's morning CNN |
 "twitter down" - Google News "twitter down" - Google News | 1h | |
|
|
|
| Elon Musk loses his position atop Forbes' annual billionaires list - CNN |
| Elon Musk loses his position atop Forbes' annual billionaires list CNN |
 "twitter down" - Google News "twitter down" - Google News | 1h | |
|
|
|
| NYPD announces two arrests in gay bar robberies and drugging ... - Washington Blade |
| NYPD announces two arrests in gay bar robberies and drugging ... Washington Blade |
 "project raven" - Google News "project raven" - Google News | 1h | |
|
|
|
| 'Absurd and destructive:' Zelenskyy slams Russia's UN Security Council presidency... |
| 'Absurd and destructive:' Zelenskyy slams Russia's UN Security Council presidency POLITICO Europe |
 "russia-ukraine war 2022" - Google News "russia-ukraine war 2022" - Google News | 1h | |
|
|
|
| Cooper, other governors, hold call with Ukraine's Zelensky - WRAL News |
| Cooper, other governors, hold call with Ukraine's Zelensky WRAL News |
 "Zelensky" - Google News "Zelensky" - Google News | 1h | |
|
|
|
| Ukraine's Zelensky meets US congressional delegation in Kyiv - Egypt Independent |
| Ukraine's Zelensky meets US congressional delegation in Kyiv Egypt Independent |
 "Zelensky" - Google News "Zelensky" - Google News | 1h | |
|
|
|
| Game Preview: Pacers vs Knicks - NBA.com |
| Game Preview: Pacers vs Knicks NBA.com |
 "g-7 2022" - Google News "g-7 2022" - Google News | 1h | |
|
|
|
| India's average crude oil imports from Russia at 1 million barrels/day ... - BusinessLine |
| India's average crude oil imports from Russia at 1 million barrels/day ... BusinessLine |
 "g-7 2022" - Google News "g-7 2022" - Google News | 1h | |
|
|
|
 | Selected Articles Review at 11 a.m. - "Мы стоим на пороге военно-политической... |
| ... |
 The News And Times The News And Times | 1h | |
|
|
|
| 'There will be no guilty plea,' Trump attorney says ahead of arraignment - WSET |
| 'There will be no guilty plea,' Trump attorney says ahead of arraignment WSET |
 trump - Google News trump - Google News | 2h | |
|
|
|
| Trump will have 'a very bad day' on Tuesday, Christie says - NJ.com |
| Trump will have 'a very bad day' on Tuesday, Christie says NJ.com |
 trump - Google News trump - Google News | 2h | |
|
|
|
| Chinese premier, Russian PM hold phone talks - Xinhua |
| Chinese premier, Russian PM hold phone talks Xinhua |
 "Russia - China new strategic alliance by Putin and Xi" - Google News "Russia - China new strategic alliance by Putin and Xi" - Google News | 2h | |
|
|
|
| Minister Mendicino Highlights Budget Investments for Middle Class ... - Mirage News |
| Minister Mendicino Highlights Budget Investments for Middle Class ... Mirage News |
 "G7" - Google News "G7" - Google News | 2h | |
|
|
|
| ODESSA MAN SERIOUSLY INJURED AFTER COLLISION WITH ... - kmmo.com |
| ODESSA MAN SERIOUSLY INJURED AFTER COLLISION WITH ... kmmo.com |
 "Odessa" - Google News "Odessa" - Google News | 2h | |
|
|
|
 | Colombia to evacuate those closest to Nevado del Ruiz volcano |
| 2023-04-04T14:38:15ZColombian authorities plan to evacuate people living within 15 kilometers of the... |
 Reuters Reuters | 2h | |
|
|
|
 | Finland joins NATO in historic shift, Russia threatens "counter-measures" |
| 2023-04-04T14:44:36ZFinland formally joined NATO on Tuesday, its flag unfurling outside the military... |
 Reuters Reuters | 2h | |
|
|
|
 | Breakaway candidate could give Erdogan a lifeline in tight Turkey election |
| 2023-04-04T14:54:20ZMuharrem Ince, then-presidential candidate of Turkey's main opposition Republican... |
 Reuters Reuters | 2h | |
|
|
|
| Flee West Virginia as Soon as Possible |
| West Virginia ended up near the bottom of another list that measures states for livability, business... |
 Markets and Business News Review Markets and Business News Review | 2h | |
|
|
|
| Earnings Previews: Conagra, Constellation Brands, Lamb Weston |
| In early trading on Tuesday, the Dow Jones industrials were down 0.01%, but the S&P 500 was up 0.07%... |
 Markets and Business News Review Markets and Business News Review | 2h | |
|
|
|
 | |
| Met with @NATO Secretary General @JensStoltenberg today in advance of the NATO Foreign Ministers' Meeting... |
 Secretary Antony Blinken (Twitter) Secretary Antony Blinken (Twitter) | 2h | |
|
|
|
 | |
| As Ukrainian Foreign Minister @DmytroKuleba and I discussed in Brussels today, the United States and... |
 Secretary Antony Blinken (Twitter) Secretary Antony Blinken (Twitter) | 2h | |
|
|
|
| Cops Investigate White Man's Viral N-Word Rant in Supermarket Parking Lot - Yahoo... |
| Cops Investigate White Man's Viral N-Word Rant in Supermarket Parking Lot Yahoo News |
 "Is Putin PSYCHOTIC?" - Google News "Is Putin PSYCHOTIC?" - Google News | 2h | |
|
|
|
| London Airport Scraps Liquid Carry-On Limits That Drive Travelers ... - The Daily... |
| London Airport Scraps Liquid Carry-On Limits That Drive Travelers ... The Daily Beast |
 "George Santos" - Google News "George Santos" - Google News | 2h | |
|
|
|
| Donald Trump: Former president lashes out at judge before he ... - BBC |
| Donald Trump: Former president lashes out at judge before he ... BBC |
 "George Santos" - Google News "George Santos" - Google News | 2h | |
|
|
|
| Rep. George Santos swamped by people at Donald Trump rally in New York City - New... |
| Rep. George Santos swamped by people at Donald Trump rally in New York City New York Daily News |
 "George Santos" - Google News "George Santos" - Google News | 2h | |
|
|
|
| Donald Trump's historic arraignment: Marjorie Taylor Greene, George Santos arrive... |
| Donald Trump's historic arraignment: Marjorie Taylor Greene, George Santos arrive for rally (live updates) OregonLive |
 "George Santos" - Google News "George Santos" - Google News | 2h | |
|
|
|
| Trump to surrender to criminal charges; George Santos spotted outside courthouse;... |
| Trump to surrender to criminal charges; George Santos spotted outside courthouse; Trump supporters plan... |
 "George Santos" - Google News "George Santos" - Google News | 2h | |
|
|
|
| French Minister Faces Backlash After Posing for Playboy Cover - The Daily Beast |
| French Minister Faces Backlash After Posing for Playboy Cover The Daily Beast |
 "George Santos" - Google News "George Santos" - Google News | 2h | |
|
|
|
| General Staff: Russia has lost 175,690 troops in Ukraine since Feb. 24, 2022 - Yahoo... |
| General Staff: Russia has lost 175,690 troops in Ukraine since Feb. 24, 2022 Yahoo News |
 "russia - ukraine war 2022" - Google News "russia - ukraine war 2022" - Google News | 2h | |
|
|
|
| GVSU drops COVID-19 vaccine requirement for students, staff - WOODTV.com |
| GVSU drops COVID-19 vaccine requirement for students, staff WOODTV.com |
 "COVID" - Google News "COVID" - Google News | 2h | |
|
|
|
| NIH awards MaineHealth $802K to study possible cause of Long ... - MaineHealth |
| NIH awards MaineHealth $802K to study possible cause of Long ... MaineHealth |
 "COVID" - Google News "COVID" - Google News | 2h | |
|
|
|
| Innovative Drugs Soothe Fosun Pharma From Pain Of Fading Covid ... - Seeking Alpha |
| Innovative Drugs Soothe Fosun Pharma From Pain Of Fading Covid ... Seeking Alpha |
 "COVID" - Google News "COVID" - Google News | 2h | |
|
|
|
| Three years after fire burned down its building – and COVID closed ... - ROI-NJ.com |
| Three years after fire burned down its building – and COVID closed ... ROI-NJ.com |
 "COVID" - Google News "COVID" - Google News | 2h | |
|
|
|
| Agricultural Variable Rate Technology Market Size, Sales, CAGR ... - Digital Journal |
| Agricultural Variable Rate Technology Market Size, Sales, CAGR ... Digital Journal |
 "Intelligence Assessments of Russia Ukraine War 2022" - Google News "Intelligence Assessments of Russia Ukraine War 2022" - Google News | 2h | |
|
|
|
| Microcontroller Market Size 2022 Latest Insights, Growth Rate, Future Trends, Outlook... |
| Microcontroller Market Size 2022 Latest Insights, Growth Rate, Future Trends, Outlook by Types, Applications, openPR |
 "Intelligence Assessments of Russia Ukraine War 2022" - Google News "Intelligence Assessments of Russia Ukraine War 2022" - Google News | 2h | |
|
|
|
| Donald Trump set to be arraigned in historic court moment - Northwest Arkansas Democrat-Gazette |
| Donald Trump set to be arraigned in historic court moment Northwest Arkansas Democrat-Gazette |
 "Mar-a-Lago documents" - Google News "Mar-a-Lago documents" - Google News | 2h | |
|
|
|
| Son of Krasnoyarsk Governor Back in Russia After Escaping House ... - The Moscow... |
| Son of Krasnoyarsk Governor Back in Russia After Escaping House ... The Moscow Times |
 "Will Russia turn to the West?" - Google News "Will Russia turn to the West?" - Google News | 2h | |
|
|
|
| Ukraine's Zelensky Congratulates Finland On Joining NATO - Barron's |
| Ukraine's Zelensky Congratulates Finland On Joining NATO Barron's |
 "zelensky" - Google News "zelensky" - Google News | 2h | |
|
|
|
 | Avalanche Sweeps Away Tourists in Northeast India; 7 Killed |
| NEW DELHI—An avalanche swept away a group of tourists in the Himalayas in northeastern India on Tuesday,... |
 The Epoch Times | The Epoch Times The Epoch Times | The Epoch Times | 2h | |
|
|
|
| Live blog: US to send $2.6B in military aid to Ukraine - TRT World |
| Live blog: US to send $2.6B in military aid to Ukraine TRT World |
 "Biden, Scholz, Macron, Putin" - Google News "Biden, Scholz, Macron, Putin" - Google News | 2h | |
|
|
|
| Biden needs to upgrade weapons to Ukraine, defense commitment ... - msnNOW |
| Biden needs to upgrade weapons to Ukraine, defense commitment ... msnNOW |
 "Putin in Beijing" - Google News "Putin in Beijing" - Google News | 2h | |
|
|
|
| Ukraine news latest — Watch the dramatic moment Kyiv's troops ... - The Sun |
| Ukraine news latest — Watch the dramatic moment Kyiv's troops ... The Sun |
 "Gen. Gerasimov was wounded" - Google News "Gen. Gerasimov was wounded" - Google News | 2h | |
|
|
|
 | Trump's arraignment: What to expect after his surrender |
| Former President Donald Trump is to surrender and be arraigned on criminal charges stemming from 2016... |
 Associated Press Associated Press | 2h | |
|
|
|
 | Tiger cubs emerge from den at UK zoo |
| (4 Apr 2023) Tiger cubs emerge from den at UK zoo Subscribe for more Breaking News: http://smarturl.it/AssociatedPress... |
 Associated Press Associated Press | 2h | |
|
|
|
| Officials: US providing Ukraine $2.6 billion in military aid - The Seattle Times |
| Officials: US providing Ukraine $2.6 billion in military aid The Seattle Times |
 "Russians halt their offensive in Ukraine" - Google News "Russians halt their offensive in Ukraine" - Google News | 2h | |
|
|
|
| Ukraine-NATO Commission convenes for first time since 2017 after ... - Euromaidan... |
| Ukraine-NATO Commission convenes for first time since 2017 after ... Euromaidan Press |
 "Russian troops enter Donbas" - Google News "Russian troops enter Donbas" - Google News | 2h | |
|
|
|
| |
| @POTUS We can all learn a lot from watching these champions compete — and I look forward to welcoming... |
 President Biden (Twitter) President Biden (Twitter) | 2h | |
|
|
|
| |
| @POTUS Meanwhile, @UConnMBB returned to glory with a series of dominant performances that were often... |
 President Biden (Twitter) President Biden (Twitter) | 2h | |
|
|
|
| |
| @POTUS Congrats to @LSUwbkb who demonstrated excellence on and off the court. They showed us what it... |
 President Biden (Twitter) President Biden (Twitter) | 2h | |
|
|
|
| |
| In a year when March Madness often lived up to its name, both our women's champions, @LSU, and men's... |
 President Biden (Twitter) President Biden (Twitter) | 2h | |
|
|
|
| Twisting with our Mystery Guest Chubby Checker - WGN TV Chicago |
| Twisting with our Mystery Guest Chubby Checker WGN TV Chicago |
 "special counsel jack smith" - Google News "special counsel jack smith" - Google News | 2h | |
|
|
|
| UK peer brands Afghan pilot's deportation ordeal 'totally cruel ... - Arab News |
| UK peer brands Afghan pilot's deportation ordeal 'totally cruel ... Arab News |
 "US Intel: Putin gave orders to invade Ukraine" - Google News "US Intel: Putin gave orders to invade Ukraine" - Google News | 2h | |
|
|
|
| |
| Sincere congrats to Finland & President @niinisto on joining NATO on the 74th anniversary of its... |
 Володимир Зеленський (Twitter) Володимир Зеленський (Twitter) | 2h | |
|
|
|
| |
| Щиро вітаю Фінляндію й Президента @niinisto зі вступом до НАТО у 74-ту річницю його заснування. В умовах... |
 Володимир Зеленський (Twitter) Володимир Зеленський (Twitter) | 2h | |
|
|
|
 | New Zealand Will 'Unlikely' Audit Chinese Security Cameras in Govt Buildings: Minister |
| New Zealand is "unlikely" to conduct an audit of government buildings with Chinese security cameras despite... |
 The Epoch Times | The Epoch Times The Epoch Times | The Epoch Times | 2h | |
|
|
|
 | AbouThai Owner Turns Prosecution Witness, in Ongoing 47 Court Trial Faces Business... |
| The Hong Kong 47 Case trial began on Feb. 6, 2023. The 47 defendants, charged under National Security... |
 The Epoch Times | The Epoch Times The Epoch Times | The Epoch Times | 2h | |
|
|
|
 | England's Swimming Governing Body Adds 'Open' Category for Transgender Athletes |
| A new "open" category will be added from September to cater for swimmers who identify as "transgender"... |
 The Epoch Times | The Epoch Times The Epoch Times | The Epoch Times | 2h | |
|
|
|
 | GOP Lawmakers Call for Alejandro Mayorkas to Lose Salary Over Border Crisis |
| GOP House members have urged for the cancellation of Homeland Security Secretary Alejandro Mayorkas'... |
 The Epoch Times | The Epoch Times The Epoch Times | The Epoch Times | 2h | |
|
|
|
 | NATO's Border With Russia Doubles as Finland Joins Military Bloc |
| Finland formally joined NATO on Tuesday and essentially doubled the military alliance's border with Russia... |
 The Epoch Times | The Epoch Times The Epoch Times | The Epoch Times | 2h | |
|
|
|
 | AK-47 vs. M16: Which Assault Rifle Is Better? |
| There are numerous debates that will likely never be resolved – Coke vs. Pepsi, rock vs. country – but... |
 19FortyFive 19FortyFive | 2h | |
|
|
|
 | Hunter Biden Has One Thing He Doesn't Want You To Know |
| In a new development, the judge in the case has ordered Hunter Biden's financial records related to his... |
 19FortyFive 19FortyFive | 2h | |
|
|
|
 | Ukraine War Hits Home? One of Russia's Largest Cities Rocked By Explosion |
| Russian pro-war blogger Vladlen Tatarsky, whose real name is Maxim Fomin, was killed in an explosion... |
 19FortyFive 19FortyFive | 2h | |
|
|
|
 | |
| Official #Russian responses to the April 2 assassination of Russian milblogger Maksim #Fomin, aka "Vladlen... |
 ISW (Twitter) ISW (Twitter) | 2h | |
|
|
|
 | |
| Southern #Ukraine Update: Satellite imagery posted on April 1 shows that #Russian forces have erected... |
 ISW (Twitter) ISW (Twitter) | 2h | |
|
|
|
 | |
| #Russian Occupation Update: Likely #Ukrainian partisans targeted a former Russian occupation official... |
 ISW (Twitter) ISW (Twitter) | 2h | |
|
|
|
| NATO Secretary General: We will welcome Finland as the 31st ... - NATO HQ |
| NATO Secretary General: We will welcome Finland as the 31st ... NATO HQ |
 "Stoltenberg" - Google News "Stoltenberg" - Google News | 2h | |
|
|
|
| U.S. And EU Pledge To Combat Any Attempts To Disrupt Global ... - OilPrice.com |
| U.S. And EU Pledge To Combat Any Attempts To Disrupt Global ... OilPrice.com |
 "global threats to U.S. security" - Google News "global threats to U.S. security" - Google News | 2h | |
|
|
|
| Jim Jordan Is Cool With Defunding the Police — as Long as it's the FBI and DOJ -... |
| Jim Jordan Is Cool With Defunding the Police — as Long as it's the FBI and DOJ Yahoo Entertainment |
 "FBI and election 2016" - Google News "FBI and election 2016" - Google News | 2h | |
|
|
|
| Last Call: The Stoneleigh P to Relocate After Turning the Big 5-0 - Dallas Observer |
| Last Call: The Stoneleigh P to Relocate After Turning the Big 5-0 Dallas Observer |
 "covid -19 origins" - Google News "covid -19 origins" - Google News | 2h | |
|
|
|
| Elon Musk-led Twitter plans to give FREE checkmarks – Know who ... - Times Now |
| Elon Musk-led Twitter plans to give FREE checkmarks – Know who ... Times Now |
 "twitter down" - Google News "twitter down" - Google News | 2h | |
|
|
|
| Russian Foreign Minister Lavrov vows 'tough' reply to 'hostile' EU - National Herald |
| Russian Foreign Minister Lavrov vows 'tough' reply to 'hostile' EU National Herald |
 "Israel and Russia- Ukraine war 2022" - Google News "Israel and Russia- Ukraine war 2022" - Google News | 2h | |
|
|
|
| From "Let It Go" To "Remember Me": Songwriters Bobby Lopez ... - The GRAMMYs |
| From "Let It Go" To "Remember Me": Songwriters Bobby Lopez ... The GRAMMYs |
 "project raven" - Google News "project raven" - Google News | 2h | |
|
|
|
| Google Nearby Share feature now available on desktops: Full details here - Times... |
| Google Nearby Share feature now available on desktops: Full details here Times Now |
 "donbass" - Google News "donbass" - Google News | 2h | |
|
|
|
| India's average crude oil imports from Russia at 1 million barrels/day in FY23 -... |
| India's average crude oil imports from Russia at 1 million barrels/day in FY23 BusinessLine |
 "g-7 2022" - Google News "g-7 2022" - Google News | 2h | |
|
|
|
| Air Cargo Shows Signs of Improvement in February - IATA |
| Air Cargo Shows Signs of Improvement in February IATA |
 "g-7 2022" - Google News "g-7 2022" - Google News | 2h | |
|
|
|
| NEVADA KING INTERCEPTS 2.74 G/T AU OVER 89M INCLUDING 7.65 G/T AU OVER 13.4M AT NEW... |
| NEVADA KING INTERCEPTS 2.74 G/T AU OVER 89M INCLUDING 7.65 G/T AU OVER 13.4M AT NEW 'WEST ATLANTA GRABEN'... |
 "g-7 2022" - Google News "g-7 2022" - Google News | 2h | |
|
|
|
 | Rep. Green Introduces Bill to Boost US-Poland Defense Ties on NATO Anniversary |
| Rep. Mark Green (R-Tenn.) introduced legislation on April 4, the 74th anniversary of the North Atlantic... |
 The Epoch Times | The Epoch Times The Epoch Times | The Epoch Times | 2h | |
|
|
|
| How to Protect Business Accounts From Bank Failure |
| The Federal Deposit Insurance Corporation (FDIC) has a track record of paying every depositor their money... |
 The Epoch Times | The Epoch Times The Epoch Times | The Epoch Times | 2h | |
|
|
|
 | Fire Races Through Clothing Market in Bangladesh Capital |
| DHAKA, Bangladesh—Firefighters were working to get under control a massive fire that burned through a... |
 The Epoch Times | The Epoch Times The Epoch Times | The Epoch Times | 2h | |
|
|
|
| How Will the ICC's Arrest Warrant for Putin Actually Work? - Russia Matters |
| How Will the ICC's Arrest Warrant for Putin Actually Work? Russia Matters |
 "russia-ukraine war 2022" - Google News "russia-ukraine war 2022" - Google News | 2h | |
|
|
|
| Here is what happened during jury selection in Lori Vallow's murder ... - KREM.com |
| Here is what happened during jury selection in Lori Vallow's murder ... KREM.com |
 "Idaho murders" - Google News "Idaho murders" - Google News | 2h | |
|
|
|
| AFRICA/SOUTH SUDAN - The artist who designed the statue for the Mass of Pope Francis... |
| AFRICA/SOUTH SUDAN - The artist who designed the statue for the Mass of Pope Francis in Juba has been... |
 "pope francis" - Google News "pope francis" - Google News | 2h | |
|
|
|
| The Brief — The German Greens' third wheel syndrome - EURACTIV |
| The Brief — The German Greens' third wheel syndrome EURACTIV |
 "scholz and putin" - Google News "scholz and putin" - Google News | 2h | |
|
|
|
| Tight security ahead of Trump arraignment - KKCO |
| Tight security ahead of Trump arraignment KKCO |
 "Investigations of US Elections 2016" - Google News "Investigations of US Elections 2016" - Google News | 2h | |
|
|
|
 | Stormy Daniels Said She's Received Death Threats In Lead-Up To Trump Indictment |
| Daniels first went public with her alleged affair with Trump in 2018. |
 Markets and Business News Review Markets and Business News Review | 2h | |
|
|
|
 | Wisconsin Supreme Court Election: Why You Should Watch The Most Expensive Judicial... |
| Tuesday's election could have far-reaching impacts on abortion and the 2024 election. |
 Markets and Business News Review Markets and Business News Review | 2h | |
|
|
|
 | Elche Launch Official Appeal Against FC Barcelona And Gavi Selection Which Could... |
| Elche have launched an appeal against FC Barcelona for their selection of midfielder Gavi on Saturday,... |
 Markets and Business News Review Markets and Business News Review | 2h | |
|
|
|
 | So Many Things Can Go Wrong With HBO's 'Harry Potter' Show |
| There have been rumblings this was happening for a long while now, but it appears to be close to fruition.... |
 Markets and Business News Review Markets and Business News Review | 2h | |
|
|
|
 | Mideast Chaos Scrambles Energy Equation |
| Last week saw scenes of chaos never before seen in the Middle East, which is saying something given the... |
 Markets and Business News Review Markets and Business News Review | 2h | |
|
|
|
 | JPMorgan's Dimon: Effects Of Bank Failures Will Be Felt For 'Years To Come' |
| It's "absurd" to say the failure of regional banks was beneficial for large institutions like JPMorgan,... |
 Markets and Business News Review Markets and Business News Review | 2h | |
|
|
|
 | Harry Styles, Selena Gomez, Lizzo, 'Ted Lasso,' Gucci Among 2023 Webby Noms |
| Reflecting the industry's focus on AI, this year's nominees also include work from companies including... |
 Markets and Business News Review Markets and Business News Review | 2h | |
|
|
|
 | Cleveland Guardians Require Early Test Of Organizational Pitching Depth |
| The Cleveland Guardians have to rely upon their outstanding organizational pitching depth to cover recent... |
 Markets and Business News Review Markets and Business News Review | 2h | |
|
|
|
 | Only 37% Of Viewers Finished Amazon's 'Rings Of Power,' Which Is Very Bad |
| Despite a billion dollar spend, the report says that just 37% of viewers finished Amazon's Rings of Power. |
 Markets and Business News Review Markets and Business News Review | 2h | |
|
|
|
 | 3 Steps To Bankroll Your Retirement Forever |
| Let's be honest: despite today's high interest rates, it's still an income desert out there. |
 Markets and Business News Review Markets and Business News Review | 2h | |
|
|
|
| GameSir G7 review: beats Xbox at its own game - Creative Bloq |
| GameSir G7 review: beats Xbox at its own game Creative Bloq |
 "G7" - Google News "G7" - Google News | 2h | |
|
|
|
| The hypocrisy of Japan's punitive drug policy - East Asia Forum |
| The hypocrisy of Japan's punitive drug policy East Asia Forum |
 "G7" - Google News "G7" - Google News | 2h | |
|
|
|
| Russia launches 17 drones on Ukraine, 14 destroyed, says Kyiv - WION |
| Russia launches 17 drones on Ukraine, 14 destroyed, says Kyiv WION |
 "kyiv" - Google News "kyiv" - Google News | 2h | |
|
|
|
| 13 Things to Know About the New Superiority Burger - Eater NY |
| 13 Things to Know About the New Superiority Burger Eater NY |
 "Odessa" - Google News "Odessa" - Google News | 2h | |
|
|
|
| Ector County Courthouse closed due to water leak - KOSA |
| Ector County Courthouse closed due to water leak KOSA |
 "Odessa" - Google News "Odessa" - Google News | 2h | |
|
|
|
 | Trump to turn himself in, facing historic day in New York court |
| 2023-04-04T14:07:20ZFormer U.S. President Donald Trump walked into Trump Tower in Manhattan on Monday... |
 Reuters Reuters | 2h | |
|
|
|
 | SBU: Moscow Patriarchate Official Blessed Russian Soldiers During Occupation of ...... |
| LatestLY |
 "kharkiv" - Google News "kharkiv" - Google News | 2h | |
|
|
|
 | Some 1,373 objects of cultural infrastructure suffered due to Russian aggression... |
| Interfax-Ukraine |
 "kharkiv" - Google News "kharkiv" - Google News | 2h | |
|
|
|
 | Priest of Ukrainian Orthodox Church of Moscow Patriarchate blesses Russian army during... |
| Yahoo News |
 "kharkiv" - Google News "kharkiv" - Google News | 2h | |
|
|
|
| University facing class-action over COVID campus lockdown - WGN TV Chicago |
| University facing class-action over COVID campus lockdown WGN TV Chicago |
 "COVID" - Google News "COVID" - Google News | 2h | |
|
|
|
| Still no plan for long Covid treatment, doctors say - POLITICO |
| Still no plan for long Covid treatment, doctors say POLITICO |
 "COVID" - Google News "COVID" - Google News | 2h | |
|
|
|
| Samaritan Health COVID-19 testing site closes after 3 years - WWTI - InformNNY.com |
| Samaritan Health COVID-19 testing site closes after 3 years WWTI - InformNNY.com |
 "COVID" - Google News "COVID" - Google News | 2h | |
|
|
|
| Report: FDA to Authorize Another Updated COVID-19 Booster Shot ... - U.S. News &... |
| Report: FDA to Authorize Another Updated COVID-19 Booster Shot ... U.S. News & World Report |
 "COVID" - Google News "COVID" - Google News | 2h | |
|
|
|
| Long COVID Trials Raise Alarm; Marburg Concerns Emerge ... - Medpage Today |
| Long COVID Trials Raise Alarm; Marburg Concerns Emerge ... Medpage Today |
 "COVID" - Google News "COVID" - Google News | 2h | |
|
|
|
| The Post-Covid Nonprofit: Burnout, Chaos, and the Search for Staff ... - The Chronicle... |
| The Post-Covid Nonprofit: Burnout, Chaos, and the Search for Staff ... The Chronicle of Philanthropy |
 "COVID" - Google News "COVID" - Google News | 2h | |
|
|
|
| A social and medical examination of Long COVID as a "mass ... - WSWS |
| A social and medical examination of Long COVID as a "mass ... WSWS |
 "COVID" - Google News "COVID" - Google News | 2h | |
|
|
|
| Pharmacy Management Systems Market Size, Sales, CAGR And ... - Digital Journal |
| Pharmacy Management Systems Market Size, Sales, CAGR And ... Digital Journal |
 "Intelligence Assessments of Russia Ukraine War 2022" - Google News "Intelligence Assessments of Russia Ukraine War 2022" - Google News | 2h | |
|
|
|
| Vegan Protein Powder Market to exceed $8.8 Bn by 2032, Says ... - GlobeNewswire |
| Vegan Protein Powder Market to exceed $8.8 Bn by 2032, Says ... GlobeNewswire |
 "Intelligence Assessments of Russia Ukraine War 2022" - Google News "Intelligence Assessments of Russia Ukraine War 2022" - Google News | 2h | |
|
|
|
| Construction Lasers Market 2023 Report By Key Companies, Regional Analysis And Forecast... |
| Construction Lasers Market 2023 Report By Key Companies, Regional Analysis And Forecast 2032 openPR |
 "Intelligence Assessments of Russia Ukraine War 2022" - Google News "Intelligence Assessments of Russia Ukraine War 2022" - Google News | 2h | |
|
|
|
| Santos Heckled in Chaotic Scene Outside Manhattan Courthouse - The Daily Beast |
| Santos Heckled in Chaotic Scene Outside Manhattan Courthouse The Daily Beast |
 "George Santos" - Google News "George Santos" - Google News | 2h | |
|
|
|
| Rep. George Santos at courthouse ahead of Trump arraignment - CBS New York |
| Rep. George Santos at courthouse ahead of Trump arraignment CBS New York |
 "George Santos" - Google News "George Santos" - Google News | 2h | |
|
|
|
| Santos mocked as he appears at Trump arraignment rally: 'George, you should have... |
| Santos mocked as he appears at Trump arraignment rally: 'George, you should have shown up in drag' The... |
 "George Santos" - Google News "George Santos" - Google News | 2h | |
|
|
|
| Trump indictment live updates: Trump's lawyer talks next steps ... - GMA |
| Trump indictment live updates: Trump's lawyer talks next steps ... GMA |
 "George Santos" - Google News "George Santos" - Google News | 2h | |
|
|
|
| Finland joins Nato, Russia threatens 'counter-measures' - The Business Standard |
| Finland joins Nato, Russia threatens 'counter-measures' The Business Standard |
 "Scholz, Macron, Putin" - Google News "Scholz, Macron, Putin" - Google News | 2h | |
|
|
|
| Running on Ice: China's Chipmakers in a Post-October 7 World - Rhodium Group |
| Running on Ice: China's Chipmakers in a Post-October 7 World Rhodium Group |
 "global threats to U.S. security 2023" - Google News "global threats to U.S. security 2023" - Google News | 2h | |
|
|
|
| Zelensky, von der Leyen discuss need for 11th package of sanctions against Russia... |
| Zelensky, von der Leyen discuss need for 11th package of sanctions against Russia Ukrinform |
 "zelensky" - Google News "zelensky" - Google News | 2h | |
|
|
|
 | LIVE 1:15 PM ET: White House Briefing With Karine Jean-Pierre |
| White House press secretary Karine Jean-Pierre holds the daily briefing. .. |
 The Epoch Times | The Epoch Times The Epoch Times | The Epoch Times | 2h | |
|
|
|
 | South African Court Urged to Revoke Authorization of Pfizer's COVID-19 Vaccine |
| A court in South Africa is being urged to revoke the authorization for Pfizer's COVID-19 vaccine, noting... |
 The Epoch Times | The Epoch Times The Epoch Times | The Epoch Times | 2h | |
|
|
|
 | FDIC Looking to Sell $60 Billion Loan Portfolio It Acquired From Failed Signature... |
| The Federal Deposit Insurance Corporation (FDIC) is looking to sell a $60 billion loan portfolio in the... |
 The Epoch Times | The Epoch Times The Epoch Times | The Epoch Times | 2h | |
|
|
|
 | Branson's Virgin Orbit Files for Bankruptcy After Failed Rocket Launch |
| Virgin Orbit filed for Chapter 11 bankruptcy after failing to get additional funding from its backers.... |
 The Epoch Times | The Epoch Times The Epoch Times | The Epoch Times | 2h | |
|
|
|
 | Overdoses Now a Leading Cause of Death for Pregnant Women |
| Joanne Harrison Clough, a single mother, and attorney raising her granddaughter, said that when her daughter,... |
 The Epoch Times | The Epoch Times The Epoch Times | The Epoch Times | 2h | |
|
|
|
 | These Extra-Crispy Carrot Fries Are an Easy Way to Eat More Vegetables |
| Never had a carrot fry before? I hadn't either, until a recent trip to my in-laws' for the holidays.... |
 The Epoch Times | The Epoch Times The Epoch Times | The Epoch Times | 2h | |
|
|
|
 | Stabbings Prompt Calgary Mayor Jyoti Gondek to Announce New Transit Safety Measures |
| Calgary announced a new action plan Monday to make its transit system safer after two women were stabbed... |
 The Epoch Times | The Epoch Times The Epoch Times | The Epoch Times | 2h | |
|
|
|
| Putin ally accuses Western leaders of blood on their hands for ... - Business Recorder |
| Putin ally accuses Western leaders of blood on their hands for ... Business Recorder |
 "Biden, Scholz, Macron, Putin" - Google News "Biden, Scholz, Macron, Putin" - Google News | 2h | |
|
|
|
| Timeline: Donald Trump, Stormy Daniels and the $130,000 payment to buy her silence... |
| Timeline: Donald Trump, Stormy Daniels and the $130,000 payment to buy her silence CBS News |
 "FBI AND ITS ROLE IN ELECTION 2016" - Google News "FBI AND ITS ROLE IN ELECTION 2016" - Google News | 2h | |
|
|
|
| Macron and VDL to visit China in 'ambitious' bid to woo Xi away from Putin - Express |
| Macron and VDL to visit China in 'ambitious' bid to woo Xi away from Putin Express |
 "Putin in Beijing" - Google News "Putin in Beijing" - Google News | 2h | |
|
|
|
| Vladlen Tatarsky video: Moment bomb-laden statue explodes after ... - Finnoexpert |
| Vladlen Tatarsky video: Moment bomb-laden statue explodes after ... Finnoexpert |
 "Is Putin MAD?" - Google News "Is Putin MAD?" - Google News | 2h | |
|
|
|
| Xi told Putin China no longer supports Japan's claim to Russian-held islands, source... |
| Xi told Putin China no longer supports Japan's claim to Russian-held islands, source says, in shift from... |
 "Putin and Xi" - Google News "Putin and Xi" - Google News | 2h | |
|
|
|
| Russian sought for extradition by U.S. over alleged tech sales to arms company back... |
| Russian sought for extradition by U.S. over alleged tech sales to arms company back home after escape... |
 "U.S. and Russia" - Google News "U.S. and Russia" - Google News | 2h | |
|
|
|
| Officials: US providing Ukraine $2.6 billion in military aid - San Francisco Chronicle |
| Officials: US providing Ukraine $2.6 billion in military aid San Francisco Chronicle |
 "Russians halt their offensive in Ukraine" - Google News "Russians halt their offensive in Ukraine" - Google News | 2h | |
|
|
|
| Ultranationalist blogger's killing in St Petersburg café exposes Russia’s... |
| Ultranationalist blogger's killing in St Petersburg café exposes Russia's security woes FRANCE 24 English |
 "Russian troops enter Donbas" - Google News "Russian troops enter Donbas" - Google News | 2h | |
|
|
|
| Russia doubles its air and artillery strikes on Bakhmut - Euromaidan Press |
| Russia doubles its air and artillery strikes on Bakhmut Euromaidan Press |
 "Russian troops enter Donbas" - Google News "Russian troops enter Donbas" - Google News | 2h | |
|
|
|
 | Russian leadership seeks alternative to Wagner Group - UK Intelligence |
| UK Defence Intelligence has suggested that Russia is likely working on the creation of new private military... |
 Michael Novakhov's saved web pages on Inoreader Michael Novakhov's saved web pages on Inoreader | 2h | |
|
|
|
 | Putin plots to replace Wagner thugs amid high-profile military feud |
| 3 hours ago12:24 Alessandra Scotto di SantoloPolish Prime Minister Mateusz Morawiecki hailed Finland's... |
 Michael Novakhov's saved web pages on Inoreader Michael Novakhov's saved web pages on Inoreader | 2h | |
|
|
|
| Pompeo meets Zelenskyy in Kyiv visit, tells Fox arming Ukraine is 'least costly way... |
| Pompeo meets Zelenskyy in Kyiv visit, tells Fox arming Ukraine is 'least costly way to move forward' Fox... |
 "Ukraine" - Google News "Ukraine" - Google News | 2h | |
|
|
|
| "Farming Marshall Plan" Needed For Ukraine, as Wheat Variables ... - Farm Policy... |
| "Farming Marshall Plan" Needed For Ukraine, as Wheat Variables ... Farm Policy News |
 "Ukraine" - Google News "Ukraine" - Google News | 2h | |
|
|
|
| Polish farmers threaten to disrupt Zelenskyy visit as Ukrainian grain ... - EURACTIV |
| Polish farmers threaten to disrupt Zelenskyy visit as Ukrainian grain ... EURACTIV |
 "Ukraine" - Google News "Ukraine" - Google News | 2h | |
|
|
|
| |
| Foreign veterinarians have visited a sickly elephant at a southern Pakistani zoo amid widespread concern... |
 The Associated Press (Twitter) The Associated Press (Twitter) | 2h | |
|
|
|
| |
| "I was actually crying." Viewers of the Minnesota Department of Natural Resources EagleCam were heartbroken... |
 The Associated Press (Twitter) The Associated Press (Twitter) | 2h | |
|
|
|
| Stoltenberg, Finnish president say Sweden's accession to NATO is 'top priority' -... |
| Stoltenberg, Finnish president say Sweden's accession to NATO is 'top priority' Global News |
 "Stoltenberg" - Google News "Stoltenberg" - Google News | 2h | |
|
|
|
 | The Kamala Harris Comeback Has Begun |
| I have written that Kamala Harris always has the potential and prior experience to someday silence her... |
 19FortyFive 19FortyFive | 2h | |
|
|
|
| Small Dehumidifier Market Size, Share and Global Industry Analysis by Top Key Players... |
| Small Dehumidifier Market Size, Share and Global Industry Analysis by Top Key Players - Carrier, Haier,... |
 "intelligence assessments and analysis of the Russia - Ukraine War 2022" - Google News "intelligence assessments and analysis of the Russia - Ukraine War 2022" - Google News | 2h | |
|
|
|
| Most Efficient Solar Panels Market Size and Share Analysis by Top Key Players - CentroSolar,... |
| Most Efficient Solar Panels Market Size and Share Analysis by Top Key Players - CentroSolar, Green Brilliance, openPR |
 "intelligence assessments and analysis of the Russia - Ukraine War 2022" - Google News "intelligence assessments and analysis of the Russia - Ukraine War 2022" - Google News | 2h | |
|
|
|
 | Denver mayor's race centers on crime, housing, homelessness |
| DENVER (AP) — As Denver faces a rising crime rate, growing homeless encampments and dizzying housing... |
 Associated Press News: Breaking News | Latest News Today Associated Press News: Breaking News | Latest News Today | 2h | |
|
|
|
 | Light, sound show transforms Berlin museum's exhibits |
| BERLIN (AP) — Hadad, the ancient weather god at Berlin's Pergamon Museum, growls deeply as he casts his... |
 Associated Press News: Breaking News | Latest News Today Associated Press News: Breaking News | Latest News Today | 2h | |
|
|
|
 | UConn wins March Madness with 76-59 smothering of SDSU |
| HOUSTON (AP) — UConn topped off an impressive March Madness run on Monday night, clamping down early... |
 Associated Press News: Breaking News | Latest News Today Associated Press News: Breaking News | Latest News Today | 2h | |
|
|
|
| Shoigu deputy's wife vacations in French Alps as husband watches Russian soldiers... |
| Shoigu deputy's wife vacations in French Alps as husband watches Russian soldiers die Yahoo News |
 "shoigu" - Google News "shoigu" - Google News | 2h | |
|
|
|
| Ex-Russian General Blasts Putin's Military Chiefs As 'Idiots' - Radar Online |
| Ex-Russian General Blasts Putin's Military Chiefs As 'Idiots' Radar Online |
 "shoigu" - Google News "shoigu" - Google News | 2h | |
|
|
|
| News - Schriever Wargame 2023 concludes - DVIDS |
| News - Schriever Wargame 2023 concludes DVIDS |
 "global threats to U.S. security" - Google News "global threats to U.S. security" - Google News | 2h | |
|
|
|
| AFGE Urges Pentagon to Invest in Its Own Military Supply ... - AFGE |
| AFGE Urges Pentagon to Invest in Its Own Military Supply ... AFGE |
 "global threats to U.S. security" - Google News "global threats to U.S. security" - Google News | 2h | |
|
|
|
| What legal woes does Trump face? - Marketscreener.com |
| What legal woes does Trump face? Marketscreener.com |
 "Mar-a-Lago searched by FBI 2022" - Google News "Mar-a-Lago searched by FBI 2022" - Google News | 2h | |
|
|
|
 | AP Headline News - Apr 04 2023 10:00 (EDT) |
| |
 Associated Press Bulletins Associated Press Bulletins | 2h | |
|
|
|
| Drug-related deaths at Angola prompted strip searches, but who is bringing in contraband?... |
| Drug-related deaths at Angola prompted strip searches, but who is bringing in contraband? The Lens |
 "project raven" - Google News "project raven" - Google News | 2h | |
|
|
|
| In Western Ukraine, Far From the Battlefield but Not the War - The New York Times |
| In Western Ukraine, Far From the Battlefield but Not the War The New York Times |
 "Russia-Ukraine war" - Google News "Russia-Ukraine war" - Google News | 2h | |
|
|
|
| Cases collapse against 27 accused of rape and murder in India's 2002 religious riots... |
| Cases collapse against 27 accused of rape and murder in India's 2002 religious riots AOL |
 "Putin seeks foreign volunteers" - Google News "Putin seeks foreign volunteers" - Google News | 2h | |
|
|
|
| Online Sleuths Can Help — And Hurt — Murder Investigations, According To Paul Holes,... |
| Online Sleuths Can Help — And Hurt — Murder Investigations, According To Paul Holes, Whose Team Identified... |
 "Idaho murders" - Google News "Idaho murders" - Google News | 2h | |
|
|
|
 | German opposition seeks inquiry over Scholz and tax scheme - KELOLAND.com |
| KELOLAND.com |
 "scholz" - Google News "scholz" - Google News | 2h | |
|
|
|
| $411B to Rebuild Ukraine - Statista |
| $411B to Rebuild Ukraine Statista |
 "russia-ukraine war 2022" - Google News "russia-ukraine war 2022" - Google News | 2h | |
|
|
|
| Pompeo in Kyiv tells Fox News arming Ukraine is 'least costly way to move forward'... |
| Pompeo in Kyiv tells Fox News arming Ukraine is 'least costly way to move forward' Fox News |
 "kyiv" - Google News "kyiv" - Google News | 3h | |
|
|
|
| Ford’s Board Chair Overpaid by $17 Million |
| Executive Chair Bill Ford, who really runs Ford Motor Co. (NYSE: F) (and not CEO Jim Farley), made $17,302,266... |
 Markets and Business News Review Markets and Business News Review | 3h | |
|
|
|
| Opening Bell Analysts Research Calls for Tuesday, April 4 |
| This report was sent to Briefing.com subscribers earlier today. Research calls posted earlier this... |
 Markets and Business News Review Markets and Business News Review | 3h | |
|
|
|
| Marjorie Taylor Greene Headlines Trump Support Rally; Mayor's Crowd Message: ‘Control... |
| Marjorie Taylor Greene Headlines Trump Support Rally; Mayor's Crowd Message: 'Control Yourselves' NBC... |
 trump - Google News trump - Google News | 3h | |
|
|
|
| New polling suggests GOP line on Trump's indictment isn't working - MSNBC |
| New polling suggests GOP line on Trump's indictment isn't working MSNBC |
 trump - Google News trump - Google News | 3h | |
|
|
|
| Biden expresses concern for Israel judicial overhaul plan - ksjd.org |
| Biden expresses concern for Israel judicial overhaul plan ksjd.org |
 "Biden in Israel" - Google News "Biden in Israel" - Google News | 3h | |
|
|
|
 | Finland joins NATO, Russia threatens "counter-measures" |
| 2023-04-04T13:33:01ZFinland formally joined the NATO military alliance on Tuesday in a historic policy... |
 Reuters Reuters | 3h | |
|
|
|
 | India avalanche kills seven near Himalayan pass to Tibet |
| 2023-04-04T13:46:46ZAn avalanche killed seven tourists in India's Himalayan state of Sikkim near a mountain... |
 Reuters Reuters | 3h | |
|
|
|
| Preparing for the End of the COVID-19 Emergency: Tri-Agencies ... - JD Supra |
| Preparing for the End of the COVID-19 Emergency: Tri-Agencies ... JD Supra |
 "COVID" - Google News "COVID" - Google News | 3h | |
|
|
|
| Colorado researchers launch trial for new COVID vaccine for children - CBS Colardo |
| Colorado researchers launch trial for new COVID vaccine for children CBS Colardo |
 "COVID" - Google News "COVID" - Google News | 3h | |
|
|
|
| Arbutus files patent infringement lawsuit against Pfizer/BioNTech ... - Reuters |
| Arbutus files patent infringement lawsuit against Pfizer/BioNTech ... Reuters |
 "COVID" - Google News "COVID" - Google News | 3h | |
|
|
|
| Why major study argues Florida's COVID death rate compares favorably to California's... |
| Why major study argues Florida's COVID death rate compares favorably to California's The Seattle Times |
 "COVID" - Google News "COVID" - Google News | 3h | |
|
|
|
| Trump arraignment live: Indicted ex-president to appear in court - Al Jazeera English |
| Trump arraignment live: Indicted ex-president to appear in court Al Jazeera English |
 "Investigations of US Elections 2016" - Google News "Investigations of US Elections 2016" - Google News | 3h | |
|
|
|
| Fire Testing Market Analysis 2023-2032: Forecast Market Size, Top Segments And Largest... |
| Fire Testing Market Analysis 2023-2032: Forecast Market Size, Top Segments And Largest Region openPR |
 "Intelligence Assessments of Russia Ukraine War 2022" - Google News "Intelligence Assessments of Russia Ukraine War 2022" - Google News | 3h | |
|
|
|
| Aerospace Interior Adhesive Market Size, Precise Outlook and ... - Digital Journal |
| Aerospace Interior Adhesive Market Size, Precise Outlook and ... Digital Journal |
 "Intelligence Assessments of Russia Ukraine War 2022" - Google News "Intelligence Assessments of Russia Ukraine War 2022" - Google News | 3h | |
|
|
|
| EU lashes out at China for support of Russia in Ukraine war - Yahoo News |
| EU lashes out at China for support of Russia in Ukraine war Yahoo News |
 "russia-ukraine war news" - Google News "russia-ukraine war news" - Google News | 3h | |
|
|
|
| EU lashes out at China for support of Russia in Ukraine war - 69News WFMZ-TV |
| EU lashes out at China for support of Russia in Ukraine war 69News WFMZ-TV |
 "russia - ukraine war 2022" - Google News "russia - ukraine war 2022" - Google News | 3h | |
|
|
|
| Column: Wake Up, West – a new energy world order is building, fast - BOE Report |
| Column: Wake Up, West – a new energy world order is building, fast BOE Report |
 "Will Russia turn to the West?" - Google News "Will Russia turn to the West?" - Google News | 3h | |
|
|
|
 | Florida Senate Passes 6-week Abortion Ban: 'Life Is Sacred and Must Be Protected' |
| The Florida Senate on April 3 passed a bill prohibiting abortions after six weeks, a measure backed by... |
 The Epoch Times | The Epoch Times The Epoch Times | The Epoch Times | 3h | |
|
|
|
 | TikTok Fined $15.9 Million in the UK |
| A British data watchdog imposed a fine of £12.7 million ($15.9 million) on the video-sharing application... |
 The Epoch Times | The Epoch Times The Epoch Times | The Epoch Times | 3h | |
|
|
|
 | Wall Street Opens Mixed Ahead of Jobs Data; Tesla Gains |
| Wall Street's main indexes opened mixed on Tuesday ahead of jobs data that could decide the Federal Reserve's... |
 The Epoch Times | The Epoch Times The Epoch Times | The Epoch Times | 3h | |
|
|
|
 | Trump to Appear in New York Court Today |
| NEW YORK—Former President Donald Trump is expected to appear in a New York court Tuesday for an arraignment... |
 The Epoch Times | The Epoch Times The Epoch Times | The Epoch Times | 3h | |
|
|
|
 | Former Assistant US Attorney Weighs in on Trump's Defense Strategy Ahead of Arraignment |
| Former President Donald Trump could deploy several legal tactics to fight off criminal charges against... |
 The Epoch Times | The Epoch Times The Epoch Times | The Epoch Times | 3h | |
|
|
|
 | BC Throat-Slashing Suspect Charged With Terrorism Linked to Islamic State Group |
| A suspect accused of slashing a person's throat on a bus in Surrey, B.C., on Saturday has been charged... |
 The Epoch Times | The Epoch Times The Epoch Times | The Epoch Times | 3h | |
|
|
|
 | Ending Tax Exemptions for Real Estate Investment Trusts Would Save Government Nearly... |
| A report by the Parliamentary Budget Officer (PBO) estimates that the federal government could collect... |
 The Epoch Times | The Epoch Times The Epoch Times | The Epoch Times | 3h | |
|
|
|
| Allbirds' New Retro-Inspired Shoe Is the Ultimate Spring Sneaker - The Daily Beast |
| Allbirds' New Retro-Inspired Shoe Is the Ultimate Spring Sneaker The Daily Beast |
 "George Santos" - Google News "George Santos" - Google News | 3h | |
|
|
|
| Raquel Welch Died From Cardiac Arrest, Alzheimer's Disease: TMZ - The Daily Beast |
| Raquel Welch Died From Cardiac Arrest, Alzheimer's Disease: TMZ The Daily Beast |
 "George Santos" - Google News "George Santos" - Google News | 3h | |
|
|
|
| Embattled NY Rep. George Santos has a challenger, with Kellen ... - USA TODAY |
| Embattled NY Rep. George Santos has a challenger, with Kellen ... USA TODAY |
 "George Santos" - Google News "George Santos" - Google News | 3h | |
|
|
|
| Medical Examiner Rules Irvo Otieno's Death a Homicide - The Daily Beast |
| Medical Examiner Rules Irvo Otieno's Death a Homicide The Daily Beast |
 "George Santos" - Google News "George Santos" - Google News | 3h | |
|
|
|
| Another Body Found After Injured Teen Turns Up Near Corpse on ... - The Daily Beast |
| Another Body Found After Injured Teen Turns Up Near Corpse on ... The Daily Beast |
 "George Santos" - Google News "George Santos" - Google News | 3h | |
|
|
|
| Jim Jordan Is Cool With Defunding the Police — as Long as it's the FBI and DOJ -... |
| Jim Jordan Is Cool With Defunding the Police — as Long as it's the FBI and DOJ Yahoo News |
 "FBI AND ITS ROLE IN ELECTION 2016" - Google News "FBI AND ITS ROLE IN ELECTION 2016" - Google News | 3h | |
|
|
|
| Adviser to Lula met Putin to discuss peace talks for Ukraine - Buenos Aires Times |
| Adviser to Lula met Putin to discuss peace talks for Ukraine Buenos Aires Times |
 "Putin in Beijing" - Google News "Putin in Beijing" - Google News | 3h | |
|
|
|
| Nearly half of parents always take children to same holiday ... - Coventry Live |
| Nearly half of parents always take children to same holiday ... Coventry Live |
 "Is Putin MAD?" - Google News "Is Putin MAD?" - Google News | 3h | |
|
|
|
| Martha MacCallum Points Out Greg Gutfeld's Hypocrisy On Fox News' Trump Coverage... |
| Martha MacCallum Points Out Greg Gutfeld's Hypocrisy On Fox News' Trump Coverage Yahoo Eurosport UK |
 "Is Putin MAD?" - Google News "Is Putin MAD?" - Google News | 3h | |
|
|
|
| China Makes Casting Call for Putin's Successor - Yahoo News |
| China Makes Casting Call for Putin's Successor Yahoo News |
 "Putin and Xi Jinping" - Google News "Putin and Xi Jinping" - Google News | 3h | |
|
|
|
 | Mantas hechas a mano dan la bienvenida a los inmigrantes a EE.UU. |
| (4 Apr 2023) Una mujer de Massachusetts y su nieta están confeccionando a mano una colorida manta para... |
 Associated Press Associated Press | 3h | |
|
|
|
| March 17, 2023 Russia-Ukraine news - CNN International |
| March 17, 2023 Russia-Ukraine news CNN International |
 "U.S. and Russia" - Google News "U.S. and Russia" - Google News | 3h | |
|
|
|
| Ukraine: WAR BULLETIN April 3, 7.00 pm EST - Glory to Ukraine ... - smallwarsjournal |
| Ukraine: WAR BULLETIN April 3, 7.00 pm EST - Glory to Ukraine ... smallwarsjournal |
 "Russian troops enter Donbas" - Google News "Russian troops enter Donbas" - Google News | 3h | |
|
|
|
| GOP warns Trump charges will lead to more political prosecutions - The Hill |
| GOP warns Trump charges will lead to more political prosecutions The Hill |
 "special counsel jack smith" - Google News "special counsel jack smith" - Google News | 3h | |
|
|
|
 | CNN speaks with Artemis II crew |
| NASA announced the four astronauts who will helm the first crewed moon mission in five decades, queuing... |
 CNN.com - Top Stories CNN.com - Top Stories | 3h | |
|
|
|
 | |
| Thousands of UConn fans, most of them students, spilled onto campus after watching a broadcast of the... |
 The Associated Press (Twitter) The Associated Press (Twitter) | 3h | |
|
|
|
| |
| A major moment in U.S. history is set to soon unfold in a Manhattan courthouse: Former President Donald... |
 The Associated Press (Twitter) The Associated Press (Twitter) | 3h | |
|
|
|
 | |
| After six games and 240 minutes of pure dominance, it became clear there was only one thing that could... |
 The Associated Press (Twitter) The Associated Press (Twitter) | 3h | |
|
|
|
| NATO should strengthen ties with Asia-Pacific partners as China ... - Anadolu Agency... |
| NATO should strengthen ties with Asia-Pacific partners as China ... Anadolu Agency | English |
 "Stoltenberg" - Google News "Stoltenberg" - Google News | 3h | |
|
|
|
| Teaching 4th Grade In the Era of School Shootings - Men's Health |
| Teaching 4th Grade In the Era of School Shootings Men's Health |
 "Robb Elementary Uvalde" - Google News "Robb Elementary Uvalde" - Google News | 3h | |
|
|
|
| Adaptive Learning Global Market Report 2023: Growing Use of ... - GlobeNewswire |
| Adaptive Learning Global Market Report 2023: Growing Use of ... GlobeNewswire |
 "intelligence assessments and analysis of the Russia - Ukraine War 2022" - Google News "intelligence assessments and analysis of the Russia - Ukraine War 2022" - Google News | 3h | |
|
|
|
| Practice Management System Market Product Overview to 2031 - Digital Journal |
| Practice Management System Market Product Overview to 2031 Digital Journal |
 "intelligence assessments and analysis of the Russia - Ukraine War 2022" - Google News "intelligence assessments and analysis of the Russia - Ukraine War 2022" - Google News | 3h | |
|
|
|
| CIA Veteran Shares Thoughts About the Future of Putin's Presidency - ClearanceJobs |
| CIA Veteran Shares Thoughts About the Future of Putin's Presidency ClearanceJobs |
 "shoigu" - Google News "shoigu" - Google News | 3h | |
|
|
|
| Ukrainian Presidential Representative on Russians in Crimea: Cross Kerch bridge and... |
| Ukrainian Presidential Representative on Russians in Crimea: Cross Kerch bridge and go home Yahoo News |
 "Crimean bridge" - Google News "Crimean bridge" - Google News | 3h | |
|
|
|
 | Foreign veterinarians visit ailing elephant in Pakistani zoo |
| KARACHI, Pakistan (AP) — Foreign veterinarians visited a sickly elephant at a southern Pakistani zoo... |
 Associated Press News: Breaking News | Latest News Today Associated Press News: Breaking News | Latest News Today | 3h | |
|
|
|
| LIVING WITH CHUCKY: Director Kyra Elise Gardner On Breathing Life Into Her Debut... |
| LIVING WITH CHUCKY: Director Kyra Elise Gardner On Breathing Life Into Her Debut Documentary! Icon Vs.... |
 "covid -19 origins" - Google News "covid -19 origins" - Google News | 3h | |
|
|
|
| Map shows how Russia's border with NATO more than doubles with ... - msnNOW |
| Map shows how Russia's border with NATO more than doubles with ... msnNOW |
 "Kaliningrad oblast, lithuania, ukraine, nato" - Google News "Kaliningrad oblast, lithuania, ukraine, nato" - Google News | 3h | |
|
|
|
| Donald Trump legal issues: What charges, lawsuits and ... - Reuters |
| Donald Trump legal issues: What charges, lawsuits and ... Reuters |
 "Mar-a-Lago searched by FBI 2022" - Google News "Mar-a-Lago searched by FBI 2022" - Google News | 3h | |
|
|
|
| MDR, MTH, MSSP | A Guide to Finding the Right Managed Services ... - SentinelOne |
| MDR, MTH, MSSP | A Guide to Finding the Right Managed Services ... SentinelOne |
 "global threats to U.S. security" - Google News "global threats to U.S. security" - Google News | 3h | |
|
|
|
| Fortinet Unveils New Real-Time Response and Automation Capabilities Across its Security... |
| Fortinet Unveils New Real-Time Response and Automation Capabilities Across its Security Fabric, Empowering... |
 "global threats to U.S. security" - Google News "global threats to U.S. security" - Google News | 3h | |
|
|
|
| Cybereason Raises $100 Million, Appoints New CEO - SecurityWeek |
| Cybereason Raises $100 Million, Appoints New CEO SecurityWeek |
 "global threats to U.S. security" - Google News "global threats to U.S. security" - Google News | 3h | |
|
|
|
| Election Violence: Over 1100 Nigerians Sign Petition To ... - SaharaReporters.com |
| Election Violence: Over 1100 Nigerians Sign Petition To ... SaharaReporters.com |
 "global threats to U.S. security" - Google News "global threats to U.S. security" - Google News | 3h | |
|
|
|
| Gary Lineker slapped down by David Baddiel over 'Nazi' tweet that sparked BBC row... |
| Gary Lineker slapped down by David Baddiel over 'Nazi' tweet that sparked BBC row Express |
 "twitter down" - Google News "twitter down" - Google News | 3h | |
|
|
|
| Nation's Governors Meet with Ukrainian President, Back Ukraine - National Governors... |
| Nation's Governors Meet with Ukrainian President, Back Ukraine National Governors Association |
 "Biden in Kyiv 2023" - Google News "Biden in Kyiv 2023" - Google News | 3h | |
|
|
|
 | LIVE 1:15 PM ET: CNAS Releases Report on 'Enhancing US-South Korea Cooperation on... |
| The Center for a New American Security (CNAS) releases a report 'Peninsula Plus: Enhancing U.S.-South... |
 The Epoch Times | The Epoch Times The Epoch Times | The Epoch Times | 3h | |
|
|
|
 | The US Dollar Will Stay the World's Reserve Currency |
| Commentary There has been a lot of worry about the burgeoning partnership between Russia and China.... |
 The Epoch Times | The Epoch Times The Epoch Times | The Epoch Times | 3h | |
|
|
|
 | California Snowpack Breaks Record as Drought Conditions Ease |
| The snowpack in California is at its highest level in decades, bringing drought relief to several regions... |
 The Epoch Times | The Epoch Times The Epoch Times | The Epoch Times | 3h | |
|
|
|
 | Wednesday, April 5, 2023: Epoch Crossword |
| ... |
 The Epoch Times | The Epoch Times The Epoch Times | The Epoch Times | 3h | |
|
|
|
| Emerita Intersects 32.6 Meters Grading 0.2 % Copper; 1.9 % Lead ... - GlobeNewswire |
| Emerita Intersects 32.6 Meters Grading 0.2 % Copper; 1.9 % Lead ... GlobeNewswire |
 "g-7 2022" - Google News "g-7 2022" - Google News | 3h | |
|
|
|
| Photo Of Pope Francis With Two Women In A Hot Tub Is An AI-Generated Fake | BOOM... |
| Photo Of Pope Francis With Two Women In A Hot Tub Is An AI-Generated Fake | BOOM BOOM |
 "pope francis" - Google News "pope francis" - Google News | 3h | |
|
|
|
| Polish farmers threaten to 'ruin' Zelenskiy visit amid grain dispute - The Guardian |
| Polish farmers threaten to 'ruin' Zelenskiy visit amid grain dispute The Guardian |
 "russia-ukraine war 2022" - Google News "russia-ukraine war 2022" - Google News | 3h | |
|
|
|
| Russian Commander Called 'Crazy Idiot' for Sending Troops to Certain Death - Newsweek |
| Russian Commander Called 'Crazy Idiot' for Sending Troops to Certain Death Newsweek |
 "russia-ukraine war 2022" - Google News "russia-ukraine war 2022" - Google News | 3h | |
|
|
|
| The World’s Most Respected Brand |
| Brands are ranked in several ways. The brand-ranking business has become an industry of its own. Research... |
 Markets and Business News Review Markets and Business News Review | 3h | |
|
|
|
 | Stocks This Week: Buy Apple And Microsoft |
| The recommended stocks have been selected from the Cycles Research Long-Short Equity Report. |
 Markets and Business News Review Markets and Business News Review | 3h | |
|
|
|
 | Iman Project Founder And Creative Director Bree Clarke Pivots With Plants |
| The founder and creative director of Iman Co. can be found six days a week, wrist-deep in soil as she... |
 Markets and Business News Review Markets and Business News Review | 3h | |
|
|
|
 | With 74 Locations And Growing, Fogo De Chao Is A Powerhouse Brazilian Steak House... |
| A Brazilian all you can eat steakhouse Fogo de Chao, owned by a private equity company, is growing at... |
 Markets and Business News Review Markets and Business News Review | 3h | |
|
|
|
 | Only Three Korean Musicians Have Charted Hot 100 Top 10 Hits: BTS, Psy, And Now Jimin |
| Jimin's "Like Crazy" debuts at No. 1 on this week's Hot 100. |
 Markets and Business News Review Markets and Business News Review | 3h | |
|
|
|
 | TikTok Fined $16 Million For Misusing U.K. Children's Data |
| "TikTok should have known better. TikTok should have done better," said U.K. Information Commissioner... |
 Markets and Business News Review Markets and Business News Review | 3h | |
|
|
|
 | Fiorentina Quietly Building Momentum At Just The Right Time |
| Fiorentina's win at Inter was their fifth consecutive win, and Vincenzo Italiano's side is building momentum... |
 Markets and Business News Review Markets and Business News Review | 3h | |
|
|
|
 | 'Truly Sorry': Credit Suisse Chairman Apologizes To Shareholders For Bank's Failure |
| Tuesday's meeting in Zurich was the first opportunity for Credit Suisse's angry shareholders to confront... |
 Markets and Business News Review Markets and Business News Review | 3h | |
|
|
|
 | Shin Hyun-Soo Teaches Students To Fight Aliens In 'Duty After School |
| Shin's character must remain firm with his charges, even as he feels sorry for what they lost. |
 Markets and Business News Review Markets and Business News Review | 3h | |
|
|
|
 | Why Retail Transformation Takes So Long |
| Retail today needs a lot of changes to be positioned for the future. Why is it taking so long? |
 Markets and Business News Review Markets and Business News Review | 3h | |
|
|
|
 | Topgolf Callaway Brands Positioned To Thrive As Golf Industry Evolves |
| With a variety of brands under its umbrella including Callaway, Topgolf, TravisMathew and Toptracer,... |
 Markets and Business News Review Markets and Business News Review | 3h | |
|
|
|
 | Explainer: After Finland joins NATO, why is Turkey making Sweden wait? |
| 2023-04-04T13:06:18ZThe Finnish and Ukrainian flags flutter outside the city hall, as Finland becomes... |
 Reuters Reuters | 3h | |
|
|
|
 | Timeline of Donald Trump-Stormy Daniels hush money case |
| 2023-03-31T15:56:22ZFormer U.S. President Donald Trump speaks during the first rally for his re-election... |
 Reuters Reuters | 3h | |
|
|
|
 | Trump to turn himself in, faces day in court |
| 2023-04-04T13:04:09ZFormer U.S. President Donald Trump walked into Trump Tower in Manhattan on Monday... |
 Reuters Reuters | 3h | |
|
|
|
 | Donald Trump legal issues: what charges, lawsuits and investigations is he facing? |
| 2023-04-04T13:17:49ZNew York prosecutors took a historic step on Thursday by filing criminal charges... |
 Reuters Reuters | 3h | |
|
|
|
 | Alvin Bragg: Who is the Manhattan District Attorney who got Trump indicted? |
| 2023-04-04T13:20:39ZNew York District Attorney Alvin Bragg leaves after former U.S. President Donald... |
 Reuters Reuters | 3h | |
|
|
|
 | Finland joins NATO, Russia warns of counter-measures |
| 2023-04-04T12:55:18ZFinland formally joined the NATO military alliance on Tuesday in a historic policy... |
 Reuters Reuters | 3h | |
|
|
|
| DTEK Kyiv Grids plans to restore more than 800 power facilities, 100 km of lines... |
| DTEK Kyiv Grids plans to restore more than 800 power facilities, 100 km of lines in preparation for winter... |
 "kyiv" - Google News "kyiv" - Google News | 3h | |
|
|
|
| Trump holds 13-point lead over DeSantis in New Hampshire: poll - The Hill |
| Trump holds 13-point lead over DeSantis in New Hampshire: poll The Hill |
 trump - Google News trump - Google News | 3h | |
|
|
|
| 'The helicopter lost track of Trump': how the BBC News channel picked the wildest... |
| 'The helicopter lost track of Trump': how the BBC News channel picked the wildest day for a revamp The... |
 trump - Google News trump - Google News | 3h | |
|
|
|
| Watch: Trump posts video from his motorcade while en route to New ... - CNN |
| Watch: Trump posts video from his motorcade while en route to New ... CNN |
 trump - Google News trump - Google News | 3h | |
|
|
|
| Cognitive impairment in people living with HIV not made worse by COVID-19 in those... |
| Cognitive impairment in people living with HIV not made worse by COVID-19 in those who are vaccinated,... |
 "COVID" - Google News "COVID" - Google News | 3h | |
|
|
|
| Veru Announces Preclinical Results from Expanded Sabizabulin Program into Influenza-Induced... |
| Veru Announces Preclinical Results from Expanded Sabizabulin Program into Influenza-Induced Severe Acute... |
 "COVID" - Google News "COVID" - Google News | 3h | |
|
|
|
| Book Review: 'Who We Are Now' is the tales of COVID's impact and ... - The Philadelphia... |
| Book Review: 'Who We Are Now' is the tales of COVID's impact and ... The Philadelphia Tribune |
 "COVID" - Google News "COVID" - Google News | 3h | |
|
|
|
| Ask the Doctors | Managing symptoms of lingering COVID - Eureka Times-Standard |
| Ask the Doctors | Managing symptoms of lingering COVID Eureka Times-Standard |
 "COVID" - Google News "COVID" - Google News | 3h | |
|
|
|
| Children receive music therapy at oncological hospital in Kharkiv - Yeni Şafak English |
| Children receive music therapy at oncological hospital in Kharkiv Yeni Şafak English |
 "kharkiv" - Google News "kharkiv" - Google News | 3h | |
|
|
|
| Natural Fragrance Market Size, Status, Global Outlook 2023-2029 ... - Digital Journal |
| Natural Fragrance Market Size, Status, Global Outlook 2023-2029 ... Digital Journal |
 "Intelligence Assessments of Russia Ukraine War 2022" - Google News "Intelligence Assessments of Russia Ukraine War 2022" - Google News | 3h | |
|
|
|
| Pet Doors Market Size, Share, Growth Analysis, and Forecast 2029 ... - Digital Journal |
| Pet Doors Market Size, Share, Growth Analysis, and Forecast 2029 ... Digital Journal |
 "Intelligence Assessments of Russia Ukraine War 2022" - Google News "Intelligence Assessments of Russia Ukraine War 2022" - Google News | 3h | |
|
|
|
| ROBERT L. MARONIC: America's Endless Wars for Endless Peace ... - The Roanoke Star |
| ROBERT L. MARONIC: America's Endless Wars for Endless Peace ... The Roanoke Star |
 "Intelligence Assessments of Russia Ukraine War 2022" - Google News "Intelligence Assessments of Russia Ukraine War 2022" - Google News | 3h | |
|
|
|
| Air defense forces destroy 14 of 17 Shahed UAVs in Odesa region - Ukrinform |
| Air defense forces destroy 14 of 17 Shahed UAVs in Odesa region Ukrinform |
 "Odessa" - Google News "Odessa" - Google News | 3h | |
|
|
|
| Authorities: Russian drone attack on Ukrainian port city of Odessa - INDONEWYORK |
| Authorities: Russian drone attack on Ukrainian port city of Odessa INDONEWYORK |
 "Odessa" - Google News "Odessa" - Google News | 3h | |
|
|
|
| Zelensky, on Bucha anniversary, vows to defeat 'Russian evil' - Yahoo News |
| Zelensky, on Bucha anniversary, vows to defeat 'Russian evil' Yahoo News |
 "Zelensky and Putin" - Google News "Zelensky and Putin" - Google News | 3h | |
|
|
|
 | Russian businessman back after fleeing house arrest in Italy - ABC News |
| ABC News |
 "Will Russia turn to the West?" - Google News "Will Russia turn to the West?" - Google News | 3h | |
|
|
|
| Richard Branson's Space X Rival Virgin Orbit Files for Bankruptcy - The Daily Beast |
| Richard Branson's Space X Rival Virgin Orbit Files for Bankruptcy The Daily Beast |
 "George Santos" - Google News "George Santos" - Google News | 3h | |
|
|
|
| Woman Claiming to Be Madeleine McCann Proved Wrong by DNA ... - The Daily Beast |
| Woman Claiming to Be Madeleine McCann Proved Wrong by DNA ... The Daily Beast |
 "George Santos" - Google News "George Santos" - Google News | 3h | |
|
|
|
| Woman Now Charged With Terrorism Over Pro-War Blogger's Death - The Daily Beast |
| Woman Now Charged With Terrorism Over Pro-War Blogger's Death The Daily Beast |
 "George Santos" - Google News "George Santos" - Google News | 3h | |
|
|
|
| Foreign veterinarians visit ailing elephant in Pakistani zoo |
| |
 All Stories All Stories | 3h | |
|
|
|
| Denver mayor's race centers on crime, housing, homelessness |
| |
 All Stories All Stories | 3h | |
|
|
|
| Chiefs' Travis Kelce to host music festival in Kansas City |
| |
 All Stories All Stories | 3h | |
|
|
|
| China's precarious balancing act - The Japan Times |
| China's precarious balancing act The Japan Times |
 "Putin and Xi" - Google News "Putin and Xi" - Google News | 3h | |
|
|
|
| From Columbine to Uvalde to Nashville, school shootings impact all - The Daily Memphian |
| From Columbine to Uvalde to Nashville, school shootings impact all The Daily Memphian |
 "Uvalde" - Google News "Uvalde" - Google News | 3h | |
|
|
|
| Trump's Secret Service agents set to testify to grand jury in Mar-a ... - Ponca City... |
| Trump's Secret Service agents set to testify to grand jury in Mar-a ... Ponca City News |
 "special counsel jack smith" - Google News "special counsel jack smith" - Google News | 3h | |
|
|
|
| Russia Warns of 'Countermeasures' to Finland's NATO Membership - The Moscow Times |
| Russia Warns of 'Countermeasures' to Finland's NATO Membership The Moscow Times |
 "US Intel: Putin gave orders to invade Ukraine" - Google News "US Intel: Putin gave orders to invade Ukraine" - Google News | 3h | |
|
|
|
| Putin protection officer DEFECTS and labels despot a 'war criminal' - Daily Mail |
| Putin protection officer DEFECTS and labels despot a 'war criminal' Daily Mail |
 "US Intel: Putin gave orders to invade Ukraine" - Google News "US Intel: Putin gave orders to invade Ukraine" - Google News | 3h | |
|
|
|
 | |
| The Associated Press retweeted: Ben Affleck's... |
 The Associated Press (Twitter) The Associated Press (Twitter) | 3h | |
|
|
|
| |
| Manhattan District Attorney Alvin Bragg arrived at the court in New York ahead of former President Donald... |
 The Associated Press (Twitter) The Associated Press (Twitter) | 3h | |
|
|
|
 | |
| A passenger train slammed into a construction crane and derailed in the Netherlands near The Hague in... |
 The Associated Press (Twitter) The Associated Press (Twitter) | 3h | |
|
|
|
 | |
| BREAKING: Finland joins NATO alliance, dealing a major blow to Russia. The move reflects a historic realignment... |
 The Associated Press (Twitter) The Associated Press (Twitter) | 3h | |
|
|
|
| |
| The Associated Press retweeted: Los Angeles... |
 The Associated Press (Twitter) The Associated Press (Twitter) | 3h | |
|
|
|
 | |
| The Associated Press retweeted: ON THIS DAY... |
 The Associated Press (Twitter) The Associated Press (Twitter) | 3h | |
|
|
|
| |
| The Associated Press retweeted: Ice and easy... |
 The Associated Press (Twitter) The Associated Press (Twitter) | 3h | |
|
|
|
 | |
| Journalists waited outside a New York City courthouse early Tuesday, in preparation for former President... |
 The Associated Press (Twitter) The Associated Press (Twitter) | 3h | |
|
|
|
| |
| The chairman of Credit Suisse has apologized to shareholders for failures and acknowledged the shock... |
 The Associated Press (Twitter) The Associated Press (Twitter) | 3h | |
|
|
|
| |
| The military in the West African nation of Burkina Faso has denied responsibility for the violent killing... |
 The Associated Press (Twitter) The Associated Press (Twitter) | 3h | |
|
|
|
| |
| Harry Styles, Post Malone, Lizzo, Doja Cat, Megan Thee Stallion, the cast of "Ted Lasso" and the web... |
 The Associated Press (Twitter) The Associated Press (Twitter) | 3h | |
|
|
|
| |
| An avalanche has swept away a group of tourists in the Himalayas in northeastern India, killing at least... |
 The Associated Press (Twitter) The Associated Press (Twitter) | 3h | |
|
|
|
| |
| Voters in Chicago will choose a new mayor on Tuesday as two candidates with contrasting views on issues... |
 The Associated Press (Twitter) The Associated Press (Twitter) | 3h | |
|
|
|
| |
| The Biden administration is making $450 million available for solar farms and other clean energy projects... |
 The Associated Press (Twitter) The Associated Press (Twitter) | 3h | |
|
|
|
| Ukraine downs 14 of 17 Russian kamikaze drones during nighttime ... - Euromaidan... |
| Ukraine downs 14 of 17 Russian kamikaze drones during nighttime ... Euromaidan Press |
 "Russian troops enter Donbas" - Google News "Russian troops enter Donbas" - Google News | 3h | |
|
|
|
| Is America's global preeminence under threat? - The Hill |
| Is America's global preeminence under threat? The Hill |
 "Russians halt their offensive in Ukraine" - Google News "Russians halt their offensive in Ukraine" - Google News | 3h | |
|
|
|
| Russians take equipment out of Mariupol due to logistical problems - Yahoo News |
| Russians take equipment out of Mariupol due to logistical problems Yahoo News |
 "Russians halt their offensive in Ukraine" - Google News "Russians halt their offensive in Ukraine" - Google News | 3h | |
|
|
|
| |
| I had a phone call with Prime Minister of Canada @JustinTrudeau. I thanked him for CAD 2.4 billion in... |
 Володимир Зеленський (Twitter) Володимир Зеленський (Twitter) | 3h | |
|
|
|
| |
| Провів телефонну розмову з Прем'єр-міністром Канади @JustinTrudeau. Подякував за 2,4 млрд CAD допомоги... |
 Володимир Зеленський (Twitter) Володимир Зеленський (Twitter) | 3h | |
|
|
|
| Finland joins NATO, dealing blow to Russia for Ukraine war - The Ridgefield Press |
| Finland joins NATO, dealing blow to Russia for Ukraine war The Ridgefield Press |
 "ukraine neutrality" - Google News "ukraine neutrality" - Google News | 3h | |
|
|
|
| Finland joins NATO, dealing blow to Russia for Ukraine war - KKTV |
| Finland joins NATO, dealing blow to Russia for Ukraine war KKTV |
 "ukraine neutrality" - Google News "ukraine neutrality" - Google News | 3h | |
|
|
|
| States aim to boost school safety after Tennessee shooting - The Sumter Item |
| States aim to boost school safety after Tennessee shooting The Sumter Item |
 "Robb Elementary Uvalde" - Google News "Robb Elementary Uvalde" - Google News | 3h | |
|
|
|
| Donald Trump to surrender to history-making criminal charges |
| AP correspondent Julie Walker reports on Trump Rally Preview |
 AP Audio Wire AP Audio Wire | 3h | |
|
|
|
| Macron heads to China for delicate talks on Ukraine, trade - Times of India |
| Macron heads to China for delicate talks on Ukraine, trade Times of India |
 "Russia Ukraine peace talks" - Google News "Russia Ukraine peace talks" - Google News | 3h | |
|
|
|
| Russia to offer food for North Korean weapons - US - BBC |
| Russia to offer food for North Korean weapons - US BBC |
 "weapons for ukraine" - Google News "weapons for ukraine" - Google News | 3h | |
|
|
|
| TSX REPORT: Swiss tiptoe into Winter Games talks; Taekwondo readmits Russians; Swim... |
| TSX REPORT: Swiss tiptoe into Winter Games talks; Taekwondo readmits Russians; Swim England creates "Open"... |
 "Olympic Gymnasts Scandal!" - Google News "Olympic Gymnasts Scandal!" - Google News | 3h | |
|
|
|
 | Credit Suisse shareholders get last crack at annual meeting |
| GENEVA (AP) — Once-venerable Credit Suisse is heading into a possible firestorm Tuesday as shareholders... |
 Associated Press News: Breaking News | Latest News Today Associated Press News: Breaking News | Latest News Today | 3h | |
|
|
|
 | A ship for windpower is taking shape in Lousiana oil country |
| HOUMA, La. (AP) — In Louisiana bayou country, where oil rig supply ships are as much a part of the waterside... |
 Associated Press News: Breaking News | Latest News Today Associated Press News: Breaking News | Latest News Today | 3h | |
|
|
|
| World News | ⚡ICC Issues Arrest Warrant for Russian President Vladimir Putin - LatestLY |
| World News | ⚡ICC Issues Arrest Warrant for Russian President Vladimir Putin LatestLY |
 "International criminal court issues arrest warrant for Putin" - Google News "International criminal court issues arrest warrant for Putin" - Google News | 3h | |
|
|
|
| Michelle Yeoh to Be Feted at Japan Festival – Global Bulletin - Yahoo Entertainment |
| Michelle Yeoh to Be Feted at Japan Festival – Global Bulletin Yahoo Entertainment |
 "covid -19 origins" - Google News "covid -19 origins" - Google News | 3h | |
|
|
|
 | AP Headline News - Apr 04 2023 09:00 (EDT) |
| |
 Associated Press Bulletins Associated Press Bulletins | 3h | |
|
|
|
| The complex web of interdependence and threat balancing that ... - Middle East Institute |
| The complex web of interdependence and threat balancing that ... Middle East Institute |
 "global threats to U.S. security" - Google News "global threats to U.S. security" - Google News | 3h | |
|
|
|
| Fortinet Unveils New Real-Time Response and Automation Capabilities Across its Security... |
| Fortinet Unveils New Real-Time Response and Automation Capabilities Across its Security Fabric, Empowering... |
 "global threats to U.S. security" - Google News "global threats to U.S. security" - Google News | 3h | |
|
|
|
| Johnson Controls deepens its collaboration with the International ... - Johnson Controls |
| Johnson Controls deepens its collaboration with the International ... Johnson Controls |
 "global threats to U.S. security" - Google News "global threats to U.S. security" - Google News | 3h | |
|
|
|
| Your Daily Phil: Ukrainian Jews prepare for Passover + Christian ... - eJewish Philanthropy |
| Your Daily Phil: Ukrainian Jews prepare for Passover + Christian ... eJewish Philanthropy |
 "Israel and Russia- Ukraine war 2022" - Google News "Israel and Russia- Ukraine war 2022" - Google News | 3h | |
|
|
|
 | Was Vladlen Tatarsky liquidated by the GRU to control the information war and as... |
| Michael Novakhov @mikenovposted at 11:22:15 UTC by Michael Novakhov via Tweets by @mikenov#VladlenTatarsky #GRU #RussianGenerals Was... |
 The News And Times The News And Times | 3h | |
|
|
|
| Ann Cleeves on Shetland, tunnel visions and the romance of the ferry - HeraldScotland |
| Ann Cleeves on Shetland, tunnel visions and the romance of the ferry HeraldScotland |
 "project raven" - Google News "project raven" - Google News | 3h | |
|
|
|
| Finland joins NATO alliance, dealing major blow to Russia with historic realignment... |
| Finland joins NATO alliance, dealing major blow to Russia with historic realignment triggered by Ukraine... |
 "Russia-Ukraine war" - Google News "Russia-Ukraine war" - Google News | 3h | |
|
|
|
| Fact Check-Screenshot showing Telegraph tweet on Pope Francis ... - Reuters.com |
| Fact Check-Screenshot showing Telegraph tweet on Pope Francis ... Reuters.com |
 "pope francis" - Google News "pope francis" - Google News | 4h | |
|
|
|
| Former Top U.S. Diplomat Pompeo Visits Kyiv, Underscores Support - Radio Free Europe... |
| Former Top U.S. Diplomat Pompeo Visits Kyiv, Underscores Support Radio Free Europe / Radio Liberty |
 "scholz and putin" - Google News "scholz and putin" - Google News | 4h | |
|
|
|
 | Webby Award nominations for Harry Styles, Lizzo, Post Malone |
| NEW YORK (AP) — Harry Styles, Post Malone, Lizzo, Doja Cat, Megan Thee Stallion, the cast of "Ted Lasso"... |
 Associated Press News: Breaking News | Latest News Today Associated Press News: Breaking News | Latest News Today | 4h | |
|
|
|
| Tuesday’s Top Analyst Upgrades and Downgrades: Agnico Eagle Mines, Bloom Energy,... |
| The futures were trading higher, as the second quarter got underway with a big rally for the Dow Jones... |
 Markets and Business News Review Markets and Business News Review | 4h | |
|
|
|
| TikTok fined £12.7mn for failing to protect children's privacy |
| Fine by UK watchdog comes amid growing global concerns over use of data at the Chinese-owned social media... |
 Markets and Business News Review Markets and Business News Review | 4h | |
|
|
|
| Who Is Trump Arraignment Judge? What to Know About Juan Merchan - NBC New York |
| Who Is Trump Arraignment Judge? What to Know About Juan Merchan NBC New York |
 trump - Google News trump - Google News | 4h | |
|
|
|
| Why does Trump think attacking his Manhattan judge is a good plan? - Yahoo News |
| Why does Trump think attacking his Manhattan judge is a good plan? Yahoo News |
 trump - Google News trump - Google News | 4h | |
|
|
|
 | Finland becomes member of NATO |
| 2023-04-04T12:50:08ZThe Finnish flag flutters outside the city hall, as Finland becomes a member of NATO,... |
 Reuters Reuters | 4h | |
|
|
|
 | Factbox: Who is Stormy Daniels and what did she say happened with Trump? |
| 2023-04-04T12:51:57ZAdult film actress Stormy Daniels attends the Venus erotic fair in Berlin, Germany,... |
 Reuters Reuters | 4h | |
|
|
|
| War in Ukraine, live: Moscow sends drones to Odessa and digs ... - Globe Echo |
| War in Ukraine, live: Moscow sends drones to Odessa and digs ... Globe Echo |
 "Odessa" - Google News "Odessa" - Google News | 4h | |
|
|
|
| Some People Who Suffered Covid Shot Injuries Haven't Yet Been ... - Kaiser Health... |
| Some People Who Suffered Covid Shot Injuries Haven't Yet Been ... Kaiser Health News |
 "COVID" - Google News "COVID" - Google News | 4h | |
|
|
|
| China is trying to move on from Covid. But is it prepared for the next outbreak?... |
| China is trying to move on from Covid. But is it prepared for the next outbreak? South China Morning... |
 "COVID" - Google News "COVID" - Google News | 4h | |
|
|
|
| Finland joins NATO as Russia's war rages on in Ukraine - Al Jazeera English |
| Finland joins NATO as Russia's war rages on in Ukraine Al Jazeera English |
 "russia-ukraine war news" - Google News "russia-ukraine war news" - Google News | 4h | |
|
|
|
 | Margaret Thatcher's Former Chancellor Nigel Lawson Dies at 91 |
| Former Prime Minister Margaret Thatcher's Chancellor, Lord Nigel Lawson, has died at the age of 91. The... |
 The Epoch Times | The Epoch Times The Epoch Times | The Epoch Times | 4h | |
|
|
|
| Five Urgent Questions on Ecological Security (April, 2023) - World - ReliefWeb |
| Five Urgent Questions on Ecological Security (April, 2023) - World ReliefWeb |
 "global threats to U.S. security 2023" - Google News "global threats to U.S. security 2023" - Google News | 4h | |
|
|
|
| PYMNTS Intelligence: How SMBs Can Fight the Fraud Threats of Remote Work - PYMNTS.com |
| PYMNTS Intelligence: How SMBs Can Fight the Fraud Threats of Remote Work PYMNTS.com |
 "global threats to U.S. security 2023" - Google News "global threats to U.S. security 2023" - Google News | 4h | |
|
|
|
| Direct-Path Attacks Surge in 2022 Making Up Half of All DDoS Attacks According to... |
| Direct-Path Attacks Surge in 2022 Making Up Half of All DDoS Attacks According to Latest NETSCOUT DDoS... |
 "global threats to U.S. security 2023" - Google News "global threats to U.S. security 2023" - Google News | 4h | |
|
|
|
| US and Ukraine fighting for common goals for over a year - Zelensky - Ukrinform |
| US and Ukraine fighting for common goals for over a year - Zelensky Ukrinform |
 "zelensky" - Google News "zelensky" - Google News | 4h | |
|
|
|
| Russian Copper Billionaire Bankrolling Military Unit Fighting in ... - The Moscow... |
| Russian Copper Billionaire Bankrolling Military Unit Fighting in ... The Moscow Times |
 "Will Russia turn to the West?" - Google News "Will Russia turn to the West?" - Google News | 4h | |
|
|
|
| AP News Summary at 7:01 a.m. EDT - FOX 28 Spokane |
| AP News Summary at 7:01 a.m. EDT FOX 28 Spokane |
 "FBI AND ITS ROLE IN ELECTION 2016" - Google News "FBI AND ITS ROLE IN ELECTION 2016" - Google News | 4h | |
|
|
|
| Finland joins NATO alliance, dealing major blow to Russia with historic realignment... |
| |
 All Stories All Stories | 4h | |
|
|
|
| NHL's Pride nights collide with LGBTQ+ political climate |
| |
 All Stories All Stories | 4h | |
|
|
|
| New images from inside Fukushima reactor spark safety worry |
| |
 All Stories All Stories | 4h | |
|
|
|
| Santos faces his first primary challenger for 2024 - CNN |
| Santos faces his first primary challenger for 2024 CNNGeorge Santos Gets NY Primary Challenger in Former... |
 "George Santos" - Google News "George Santos" - Google News | 4h | |
|
|
|
| Harry Potter TV Show Could Be Coming Soon: Report - The Daily Beast |
| Harry Potter TV Show Could Be Coming Soon: Report The Daily Beast |
 "George Santos" - Google News "George Santos" - Google News | 4h | |
|
|
|
| House Democrats targeting 33 GOP-held and open seats next year - Brunswick News |
| House Democrats targeting 33 GOP-held and open seats next year Brunswick News |
 "George Santos" - Google News "George Santos" - Google News | 4h | |
|
|
|
| Video of wombats mating sideways offers rare glimpse into ... - Australian Geographic |
| Video of wombats mating sideways offers rare glimpse into ... Australian Geographic |
 "aggressive rats in new york city" - Google News "aggressive rats in new york city" - Google News | 4h | |
|
|
|
| Ukraine's Zelenskyy is 'ready' for Chinese leader to visit - The Independent |
| Ukraine's Zelenskyy is 'ready' for Chinese leader to visit The Independent |
 "Putin in Beijing" - Google News "Putin in Beijing" - Google News | 4h | |
|
|
|
| Joint Statement on the U.S. - EU Energy Council - United States ... - Department... |
| Joint Statement on the U.S. - EU Energy Council - United States ... Department of State |
 "G7 and Russia Ukraine war" - Google News "G7 and Russia Ukraine war" - Google News | 4h | |
|
|
|
| Who blew up Vladlen Tatarsky? Assassination of pro-war blogger sparks mystery - Daily... |
| Who blew up Vladlen Tatarsky? Assassination of pro-war blogger sparks mystery Daily Mail |
 "Gen. Gerasimov was wounded" - Google News "Gen. Gerasimov was wounded" - Google News | 4h | |
|
|
|
| Putin's Neo-Realism: Is Russia Paving the Way for a New World Order in Asia-Pacific?... |
| Putin's Neo-Realism: Is Russia Paving the Way for a New World Order in Asia-Pacific? Modern Diplomacy |
 "Is Putin MAD?" - Google News "Is Putin MAD?" - Google News | 4h | |
|
|
|
| Wolf-Masked Chiefs Fan on the Run After Suspected Bank Robbery - The Daily Beast |
| Wolf-Masked Chiefs Fan on the Run After Suspected Bank Robbery The Daily Beast |
 "Is Putin MAD?" - Google News "Is Putin MAD?" - Google News | 4h | |
|
|
|
 | Is a New Russia-China-India Bloc Forming in the East? - The Diplomat |
| The Diplomat |
 "Putin and Xi Jinping" - Google News "Putin and Xi Jinping" - Google News | 4h | |
|
|
|
| Communiqué of the 1143rd meeting of the PSC held on 7 March ... - ReliefWeb |
| Communiqué of the 1143rd meeting of the PSC held on 7 March ... ReliefWeb |
 "National Security Council" - Google News "National Security Council" - Google News | 4h | |
|
|
|
| ICYMI: Experts Agree: Chips Manufacturing and National Security ... - The White House |
| ICYMI: Experts Agree: Chips Manufacturing and National Security ... The White House |
 "National Security Council" - Google News "National Security Council" - Google News | 4h | |
|
|
|
 | Ukrainian ambassador Oksana Markarova is Washington's No. 1 party guest - The Washington... |
| The Washington Post |
 "Ukraine" - Google News "Ukraine" - Google News | 4h | |
|
|
|
 | Music brings message of hope from Long Island to Ukraine - CBS New York |
| CBS New York |
 "Ukraine" - Google News "Ukraine" - Google News | 4h | |
|
|
|
| China floating nuclear power plants in South China Sea - Modern Diplomacy |
| China floating nuclear power plants in South China Sea Modern Diplomacy |
 "US Intel: Putin gave orders to invade Ukraine" - Google News "US Intel: Putin gave orders to invade Ukraine" - Google News | 4h | |
|
|
|
| |
| I'm in constant contact with @vonderleyen. Thanked her for participating in the Bucha Summit. Discussed... |
 Володимир Зеленський (Twitter) Володимир Зеленський (Twitter) | 4h | |
|
|
|
| |
| Підтримую постійний контакт із @vonderleyen. Подякував за участь у Бучанському саміті, обговорили майбутні... |
 Володимир Зеленський (Twitter) Володимир Зеленський (Twitter) | 4h | |
|
|
|
 | The city where the oceans collide |
| Cape Town is the embodiment of multicultural South Africa. Long home to nomadic pastoralists, the country's... |
 CNN.com - Top Stories CNN.com - Top Stories | 4h | |
|
|
|
 | Forecast Warns of More Severe Storms in South, Midwest |
| Forecasters are warning of more severe weather, including tornadoes, Tuesday and Wednesday in parts of... |
 The Epoch Times | The Epoch Times The Epoch Times | The Epoch Times | 4h | |
|
|
|
 | Palau Bans Import, Sale and Advertising of E-cigarettes |
| Palau's government has imposed a ban on the sale and use of electronic cigarettes in the Pacific Island... |
 The Epoch Times | The Epoch Times The Epoch Times | The Epoch Times | 4h | |
|
|
|
 | Creating When You Feel Resistance |
| I've noticed that most of us let ourselves be driven by our resistance to something difficult, frightening,... |
 The Epoch Times | The Epoch Times The Epoch Times | The Epoch Times | 4h | |
|
|
|
 | Texas Judge Orders Books Banned From Public Libraries Be Returned to Shelves |
| Dozens of books that were removed from public libraries by officials in Llano County, Texas, due to concerns... |
 The Epoch Times | The Epoch Times The Epoch Times | The Epoch Times | 4h | |
|
|
|
 | Netherlands Train Crashes Into Maintenance Crane, Killing One; Dozens Hurt |
| VOORSCHOTEN, Netherlands—A passenger train in the Netherlands rammed into a maintenance crane on the... |
 The Epoch Times | The Epoch Times The Epoch Times | The Epoch Times | 4h | |
|
|
|
 | Senior ISIS Leader Killed in US Military Operation in Syria |
| A senior ISIS leader has been killed in a U.S. military operation in Syria, the U.S. Central Command... |
 The Epoch Times | The Epoch Times The Epoch Times | The Epoch Times | 4h | |
|
|
|
 | Nearly 100 Deaths Caused by COVID-19 Vaccines: Government Data From Major Countries... |
| While potentially fatal blood clots and heart inflammation have been acknowledged as rare side effects... |
 The Epoch Times | The Epoch Times The Epoch Times | The Epoch Times | 4h | |
|
|
|
 | An Empty World Explodes With Life: Tintoretto's 'Creation of the Animals' |
| It's an immense task to try to capture the essence of God's creation, although one artist made a powerful... |
 The Epoch Times | The Epoch Times The Epoch Times | The Epoch Times | 4h | |
|
|
|
 | Pound Hits Highest Since June, Euro up as Dollar Under Pressure |
| LONDON/SINGAPORE—The pound rose to a new 10-month high against the dollar on Tuesday, and the euro reached... |
 The Epoch Times | The Epoch Times The Epoch Times | The Epoch Times | 4h | |
|
|
|
 | 'Militant' Atheist NBA Employee Driven to Disprove God Ends Up Proving Him, Converting... |
| Marc Lozano had it all. Working for the NBA, he had achieved his dream job. He had a beautiful wife,... |
 The Epoch Times | The Epoch Times The Epoch Times | The Epoch Times | 4h | |
|
|
|
 | Teachers to Strike Again as Union Rejects Government Pay Offer |
| Teachers in England are set to strike again in the following months as the largest teachers union overwhelmingly... |
 The Epoch Times | The Epoch Times The Epoch Times | The Epoch Times | 4h | |
|
|
|
| Legal Tech Artificial Intelligence Market on the Rise: Exclusive ... - Digital Journal |
| Legal Tech Artificial Intelligence Market on the Rise: Exclusive ... Digital Journal |
 "intelligence assessments and analysis of the Russia - Ukraine War 2022" - Google News "intelligence assessments and analysis of the Russia - Ukraine War 2022" - Google News | 4h | |
|
|
|
| Secretary Blinken Meets with NATO Secretary General in Brussels - C-SPAN |
| Secretary Blinken Meets with NATO Secretary General in Brussels C-SPAN |
 "Stoltenberg" - Google News "Stoltenberg" - Google News | 4h | |
|
|
|
| NATO Foreign Ministers to discuss urgent aid to Ukraine, further support - Stoltenberg... |
| NATO Foreign Ministers to discuss urgent aid to Ukraine, further support - Stoltenberg Ukrinform |
 "Stoltenberg" - Google News "Stoltenberg" - Google News | 4h | |
|
|
|
| NATO's nuclear posture remains the same, despite Putin's rhetoric - Stoltenberg -... |
| NATO's nuclear posture remains the same, despite Putin's rhetoric - Stoltenberg Euronews |
 "Stoltenberg" - Google News "Stoltenberg" - Google News | 4h | |
|
|
|
 | 'Donald Trump Is Crazy': Biden's Strategy to Win in 2024 |
| The forty-sixth president wants to paint Donald Trump as totally unhinged. Should Biden opt to run for... |
 19FortyFive 19FortyFive | 4h | |
|
|
|
 | Sssssh! Dutch Schiphol airport will tone down the noise |
| THE HAGUE (AP) — Amsterdam's Schiphol, one of the top airports in Europe, announced Tuesday it will turn... |
 Associated Press News: Breaking News | Latest News Today Associated Press News: Breaking News | Latest News Today | 4h | |
|
|
|
 | TikTok fined $15.9M by UK watchdog over misuse of kids' data |
| Britain's privacy watchdog hit TikTok with a multimillion-dollar penalty on Tuesday for a slew of data... |
 Associated Press News: Breaking News | Latest News Today Associated Press News: Breaking News | Latest News Today | 4h | |
|
|
|
| Donald Trump set to be arraigned in historic court moment |
| AP Washington correspondent Sagar Meghani reports on Trump-Indictment. |
 AP Audio Wire AP Audio Wire | 4h | |
|
|
|
| Officials: US providing Ukraine $2.6 billion in military aid |
| AP correspondent Charles de Ledesma reports on Russia Ukraine War Military Aid-US |
 AP Audio Wire AP Audio Wire | 4h | |
|
|
|
| Michelle Yeoh to Be Feted at Japan Festival – Global Bulletin - Variety |
| Michelle Yeoh to Be Feted at Japan Festival – Global Bulletin Variety |
 "covid -19 origins" - Google News "covid -19 origins" - Google News | 4h | |
|
|
|
| Finland set for NATO membership in major blow to Russia - Global News |
| Finland set for NATO membership in major blow to Russia Global News |
 "global threats to U.S. security" - Google News "global threats to U.S. security" - Google News | 4h | |
|
|
|
| Metallica Unveil the Length of Each Song on '72 Seasons' – One ... - Loudwire |
| Metallica Unveil the Length of Each Song on '72 Seasons' – One ... Loudwire |
 "project raven" - Google News "project raven" - Google News | 4h | |
|
|
|
| US, EU vow to combat any attempts to disrupt energy markets - Reuters |
| US, EU vow to combat any attempts to disrupt energy markets Reuters |
 "g-7 2022" - Google News "g-7 2022" - Google News | 4h | |
|
|
|
| German opposition seeks inquiry over Scholz and tax scheme - WHIO |
| German opposition seeks inquiry over Scholz and tax scheme WHIO |
 "scholz" - Google News "scholz" - Google News | 4h | |
|
|
|
| German opposition seeks inquiry over Scholz and tax scheme - MyStateline.com |
| German opposition seeks inquiry over Scholz and tax scheme MyStateline.com |
 "scholz" - Google News "scholz" - Google News | 4h | |
|
|
|
| A pope observed but not revealed – Catholic World Report - Catholic World Report |
| A pope observed but not revealed – Catholic World Report Catholic World Report |
 "pope francis" - Google News "pope francis" - Google News | 4h | |
|
|
|
 | Asian shares mixed as surging oil prices fan inflation fears |
| BANGKOK (AP) — Shares were mixed in Asia on Tuesday as investors watched for the latest moves by central... |
 Associated Press News: Breaking News | Latest News Today Associated Press News: Breaking News | Latest News Today | 4h | |
|
|
|
| Bulletproof Vest Global Market to 2032: Players Include MARS ... - GlobeNewswire |
| Bulletproof Vest Global Market to 2032: Players Include MARS ... GlobeNewswire |
 "russia-ukraine war 2022" - Google News "russia-ukraine war 2022" - Google News | 4h | |
|
|
|
| Peptide Therapeutics Global Market Report 2023 - GlobeNewswire |
| Peptide Therapeutics Global Market Report 2023 GlobeNewswire |
 "Intelligence Assessments of Russia Ukraine War 2022" - Google News "Intelligence Assessments of Russia Ukraine War 2022" - Google News | 4h | |
|
|
|
| Door Frame Market Average Price by Manufacturers - Digital Journal |
| Door Frame Market Average Price by Manufacturers Digital Journal |
 "Intelligence Assessments of Russia Ukraine War 2022" - Google News "Intelligence Assessments of Russia Ukraine War 2022" - Google News | 4h | |
|
|
|
| Hotel Market Intelligence Software Market 2023-2028 | Key Players ... - Digital Journal |
| Hotel Market Intelligence Software Market 2023-2028 | Key Players ... Digital Journal |
 "Intelligence Assessments of Russia Ukraine War 2022" - Google News "Intelligence Assessments of Russia Ukraine War 2022" - Google News | 4h | |
|
|
|
| First Look Analysts Research Calls for Tuesday, April 4 |
| This report was sent to Briefing.com subscribers earlier today. Research calls posted earlier this... |
 Markets and Business News Review Markets and Business News Review | 4h | |
|
|
|
 | NASCAR Grassroots Racing Advancing Into The Future |
| NASCAR's Weekly Short Track series is more than simply a 'feeder series', for many, local short tracks... |
 Markets and Business News Review Markets and Business News Review | 4h | |
|
|
|
| Before the Bell: Tesla, AMC Hammered, DeSantis-Disney Feud Heats Up |
| Premarket action on Tuesday had the three major U.S. indexes trading higher. The Dow Jones industrials... |
 Markets and Business News Review Markets and Business News Review | 4h | |
|
|
|
 | Manchester United Race To Sign Lionel Messi And Give Him Cristiano Ronaldo's Number... |
| Manchester United are interested in signing Lionel Messi and could even offer him the iconic number '7'... |
 Markets and Business News Review Markets and Business News Review | 4h | |
|
|
|
| Opec takes the reins |
| Also in today's newsletter, a look at what's slowing the energy transition |
 Markets and Business News Review Markets and Business News Review | 4h | |
|
|
|
 | Using ChatGPT To Control And Leverage Other AI Apps Such As Hugging Face Gets You... |
| An emerging trend is to use ChatGPT as the front-end for accessing other AI apps. One such example consists... |
 Markets and Business News Review Markets and Business News Review | 4h | |
|
|
|
 | Sikkim avalanche kills seven near India"s border with China, others trapped |
| 2023-04-04T12:17:55ZAn avalanche killed at least seven tourists in India's Himalayan state of Sikkim... |
 Reuters Reuters | 4h | |
|
|
|
 | Russia charges St Petersburg bomb suspect with terrorism |
| 2023-04-04T12:16:06ZDarya Trepova, suspected of bringing explosives to the cafe where war blogger Vladlen... |
 Reuters Reuters | 4h | |
|
|
|
| Inside Donald Trump's rocky relationship with the Supreme Court - WENY-TV |
| Inside Donald Trump's rocky relationship with the Supreme Court WENY-TV |
 "Zelensky rejects the idea of Ukraine neutrality" - Google News "Zelensky rejects the idea of Ukraine neutrality" - Google News | 4h | |
|
|
|
| New Zealand in talks over partial membership of Aukus - AOL |
| New Zealand in talks over partial membership of Aukus AOL |
 "Zelensky rejects the idea of Ukraine neutrality" - Google News "Zelensky rejects the idea of Ukraine neutrality" - Google News | 4h | |
|
|
|
| African Aviation Has Now Recovered To 93% Of Pre-COVID Levels - Simple Flying |
| African Aviation Has Now Recovered To 93% Of Pre-COVID Levels Simple Flying |
 "COVID" - Google News "COVID" - Google News | 4h | |
|
|
|
| Governor Hochul Updates New Yorkers on State's Progress ... - ny.gov |
| Governor Hochul Updates New Yorkers on State's Progress ... ny.gov |
 "COVID" - Google News "COVID" - Google News | 4h | |
|
|
|
| Dendias Speaks With UNESCO Director-General Azoulay About City Of Odessa - GreekCityTimes.com |
| Dendias Speaks With UNESCO Director-General Azoulay About City Of Odessa GreekCityTimes.com |
 "Odessa" - Google News "Odessa" - Google News | 4h | |
|
|
|
| Former President Trump to be arraigned in Manhattan court - Fox News |
| Former President Trump to be arraigned in Manhattan court Fox News |
 trump - Google News trump - Google News | 4h | |
|
|
|
| Live updates: Trump makes appearance in New York court following grand jury indictment... |
| Live updates: Trump makes appearance in New York court following grand jury indictment CNN |
 trump - Google News trump - Google News | 4h | |
|
|
|
| New Hampshire Poll: Trump 42, DeSantis 29, Sununu 14, Haley 4 - National Review |
| New Hampshire Poll: Trump 42, DeSantis 29, Sununu 14, Haley 4 National Review |
 trump - Google News trump - Google News | 4h | |
|
|
|
| Live updates: Trump to surrender for arraignment today in New York ... - NPR |
| Live updates: Trump to surrender for arraignment today in New York ... NPR |
 trump - Google News trump - Google News | 4h | |
|
|
|
| Everything you need to know about judge presiding over Trump's legal case, Juan Merchan... |
| Everything you need to know about judge presiding over Trump's legal case, Juan Merchan Fox News |
 trump - Google News trump - Google News | 4h | |
|
|
|
| Meet the judge presiding over Trump's criminal arraignment - CNN |
| Meet the judge presiding over Trump's criminal arraignment CNN |
 trump - Google News trump - Google News | 4h | |
|
|
|
| Video Trump to return to Mar-a-Lago after New York arraignment - ABC News |
| Video Trump to return to Mar-a-Lago after New York arraignment ABC News |
 "Mar-a-Lago" - Google News "Mar-a-Lago" - Google News | 4h | |
|
|
|
| Lavrov ready to meet Blinken if there's willingness from US: Russian ... - Morung... |
| Lavrov ready to meet Blinken if there's willingness from US: Russian ... Morung Express |
 "blinken and lavrov" - Google News "blinken and lavrov" - Google News | 4h | |
|
|
|
| Finland parliament website targeted ahead of NATO entry - ABC News |
| Finland parliament website targeted ahead of NATO entry ABC News |
 "Will Russia turn to the West?" - Google News "Will Russia turn to the West?" - Google News | 4h | |
|
|
|
| Ukraine launches investigation into unarmed soldier killing - BBC |
| Ukraine launches investigation into unarmed soldier killing BBC |
 "zelensky" - Google News "zelensky" - Google News | 4h | |
|
|
|
| Celebrations, destruction on campus follow UConn victory |
| |
 All Stories All Stories | 4h | |
|
|
|
| DNA: Woman was on famed 17th century Swedish warship |
| |
 All Stories All Stories | 4h | |
|
|
|
| Nadal, Alcaraz pull out of clay-court Monte Carlo Masters |
| |
 All Stories All Stories | 4h | |
|
|
|
| Arrest Gun-Loving Members of Congress—Not Grieving Fathers - Yahoo News |
| Arrest Gun-Loving Members of Congress—Not Grieving Fathers Yahoo News |
 "Is Putin PSYCHOTIC?" - Google News "Is Putin PSYCHOTIC?" - Google News | 4h | |
|
|
|
| Ukraine deputy minister praises Kishida's visit to Kyiv and Bucha - The Japan Times |
| Ukraine deputy minister praises Kishida's visit to Kyiv and Bucha The Japan Times |
 "G7 and Russia Ukraine war" - Google News "G7 and Russia Ukraine war" - Google News | 4h | |
|
|
|
| QAnon Shaman's New Roommate Shocked to Discover Who He Is - The Daily Beast |
| QAnon Shaman's New Roommate Shocked to Discover Who He Is The Daily Beast |
 "Biden, Scholz, Macron, Putin" - Google News "Biden, Scholz, Macron, Putin" - Google News | 4h | |
|
|
|
| Trump is similar to the manipulative character in 'A Face in the Crowd'. - Salt Lake... |
| Trump is similar to the manipulative character in 'A Face in the Crowd'. Salt Lake Tribune |
 "George Santos" - Google News "George Santos" - Google News | 4h | |
|
|
|
| Truly Sorry: The Bloomberg Open, Americas Open - Bloomberg |
| Truly Sorry: The Bloomberg Open, Americas Open Bloomberg |
 "George Santos" - Google News "George Santos" - Google News | 4h | |
|
|
|
| WATCH: Florida Dem Party Chair Among a Dozen Detained at ... - The Daily Beast |
| WATCH: Florida Dem Party Chair Among a Dozen Detained at ... The Daily Beast |
 "George Santos" - Google News "George Santos" - Google News | 4h | |
|
|
|
| Dave Portnoy Slammed on Twitter After Lashing Out at LSU Star ... - The Daily Beast |
| Dave Portnoy Slammed on Twitter After Lashing Out at LSU Star ... The Daily Beast |
 "George Santos" - Google News "George Santos" - Google News | 4h | |
|
|
|
| George Santos appears set to 'face the music' in 2024 - liherald.com |
| George Santos appears set to 'face the music' in 2024 liherald.com |
 "George Santos" - Google News "George Santos" - Google News | 4h | |
|
|
|
| International Criminal Court Issues Arrest Warrant for Putin - The New York Times |
| International Criminal Court Issues Arrest Warrant for Putin The New York Times |
 "Putin and Xi" - Google News "Putin and Xi" - Google News | 4h | |
|
|
|
| Russian wanted in US who fled Italy says he is back in Russia - RIA - Reuters |
| Russian wanted in US who fled Italy says he is back in Russia - RIA Reuters |
 "U.S. and Russia" - Google News "U.S. and Russia" - Google News | 4h | |
|
|
|
| US says Russia not benefiting from +$60/bbl oil to India - Reuters |
| US says Russia not benefiting from +$60/bbl oil to India Reuters |
 "U.S. and Russia" - Google News "U.S. and Russia" - Google News | 4h | |
|
|
|
| 100+ Journalists Line Up at Dawn Outside Courthouse Ahead of ... - The Daily Beast |
| 100+ Journalists Line Up at Dawn Outside Courthouse Ahead of ... The Daily Beast |
 "Scholz, Macron, Putin" - Google News "Scholz, Macron, Putin" - Google News | 4h | |
|
|
|
| EU seeks reset with China in shadow of Ukraine war - Yahoo News |
| EU seeks reset with China in shadow of Ukraine war Yahoo News |
 "Scholz, Macron, Putin" - Google News "Scholz, Macron, Putin" - Google News | 4h | |
|
|
|
| Secretary General welcomes Foreign Minister of Ukraine to NATO - NATO HQ |
| Secretary General welcomes Foreign Minister of Ukraine to NATO NATO HQ |
 "Ukraine" - Google News "Ukraine" - Google News | 4h | |
|
|
|
| Ukrainian city mourns champion kickboxer killed fighting Russian troops - Yahoo Sports |
| Ukrainian city mourns champion kickboxer killed fighting Russian troops Yahoo Sports |
 "Ukraine" - Google News "Ukraine" - Google News | 4h | |
|
|
|
| Ukraine Farms Attract Money and Help From Allies, Top Food ... - The Wall Street... |
| Ukraine Farms Attract Money and Help From Allies, Top Food ... The Wall Street Journal |
 "Ukraine" - Google News "Ukraine" - Google News | 4h | |
|
|
|
| Lawsuit Seeks Records Of Toxic Exposures At Uzbek Air Base - Radio Free Europe /... |
| Lawsuit Seeks Records Of Toxic Exposures At Uzbek Air Base Radio Free Europe / Radio Liberty |
 "US Intel: Putin gave orders to invade Ukraine" - Google News "US Intel: Putin gave orders to invade Ukraine" - Google News | 4h | |
|
|
|
| Police chief: Establishing independent 'national guard' will 'harm ... - The Times... |
| Police chief: Establishing independent 'national guard' will 'harm ... The Times of Israel |
 "National Security Council" - Google News "National Security Council" - Google News | 4h | |
|
|
|
| Nato 'will ensure' Sweden becomes full member, Stoltenberg says ... - The Independent |
| Nato 'will ensure' Sweden becomes full member, Stoltenberg says ... The Independent |
 "Stoltenberg" - Google News "Stoltenberg" - Google News | 4h | |
|
|
|
| NATO says Russian aggression against Georgia, Ukraine pushed its ... - Agenda.ge |
| NATO says Russian aggression against Georgia, Ukraine pushed its ... Agenda.ge |
 "Stoltenberg" - Google News "Stoltenberg" - Google News | 4h | |
|
|
|
| UPDATE 1-Putin triggered 'historic' Nordic enlargement of NATO ... - Yahoo Finance |
| UPDATE 1-Putin triggered 'historic' Nordic enlargement of NATO ... Yahoo Finance |
 "Stoltenberg" - Google News "Stoltenberg" - Google News | 4h | |
|
|
|
 | 'Trump in Heels': Marjorie Taylor Greene's Moment Has Arrived |
| MTG has demonstrated a keen ability to be a major political player, even if her politics are widely panned... |
 19FortyFive 19FortyFive | 4h | |
|
|
|
 | Ukraine Video Shows Exact Moment Russian Tank Blown to Bits by Javelin Missile |
| "A Russian T-80BV tank was struck and destroyed by what appears to be an FGM-148 Javelin ATGM fired by... |
 19FortyFive 19FortyFive | 4h | |
|
|
|
 | AOC Has Another Legal Headache to Deal With |
| AOC's Ethics Complaint Explained – Rep. Alexandria Ocasio-Cortez (D-NY), or AOC, has been hit with an... |
 19FortyFive 19FortyFive | 4h | |
|
|
|
| Shoigu Claims Russia Placed Aircraft, Missile Systems in Belarus Capable of ... -... |
| Shoigu Claims Russia Placed Aircraft, Missile Systems in Belarus Capable of ... - Latest Tweet by The... |
 "shoigu" - Google News "shoigu" - Google News | 4h | |
|
|
|
| Russia passes nuclear-capable Iskanders to Belarus - Shoigu - Ukrinform |
| Russia passes nuclear-capable Iskanders to Belarus - Shoigu Ukrinform |
 "shoigu" - Google News "shoigu" - Google News | 4h | |
|
|
|
| Russia issues chilling nuke warning as Finland's entry into Nato TODAY takes bloc... |
| Russia issues chilling nuke warning as Finland's entry into Nato TODAY takes bloc just 78 miles from... |
 "shoigu" - Google News "shoigu" - Google News | 4h | |
|
|
|
| Ukraine war - latest updates: Finland joins NATO as Moscow issues ... - Sky News |
| Ukraine war - latest updates: Finland joins NATO as Moscow issues ... Sky News |
 "shoigu" - Google News "shoigu" - Google News | 4h | |
|
|
|
| The Technology of Taming Weapons - Geopolitical Futures |
| The Technology of Taming Weapons Geopolitical Futures |
 "weapons for ukraine" - Google News "weapons for ukraine" - Google News | 4h | |
|
|
|
 | Virgin Orbit seeks bankruptcy protection after mission fail |
| Richard Branson's Virgin Orbit is filing for Chapter 11 bankruptcy protection after a failed mission... |
 Associated Press News: Breaking News | Latest News Today Associated Press News: Breaking News | Latest News Today | 4h | |
|
|
|
 | Officials: US providing Ukraine $2.6 billion in military aid |
| WASHINGTON (AP) — The U.S. will send Ukraine about $500 million in ammunition and equipment and will... |
 Associated Press News: Breaking News | Latest News Today Associated Press News: Breaking News | Latest News Today | 4h | |
|
|
|
| How Israel has transformed from orange groves to a science and ... - The Jewish Chronicle |
| How Israel has transformed from orange groves to a science and ... The Jewish Chronicle |
 "Israel and Russia- Ukraine war 2022" - Google News "Israel and Russia- Ukraine war 2022" - Google News | 4h | |
|
|
|
 | AP Headline News - Apr 04 2023 08:00 (EDT) |
| |
 Associated Press Bulletins Associated Press Bulletins | 4h | |
|
|
|
 | Ex-Kosovo leader Thaci tells war crimes court he will be exonerated |
| 2023-04-04T11:49:52ZKosovo's former president Hashim Thaci expressed sorrow on Tuesday for all victims... |
 Reuters Reuters | 4h | |
|
|
|
 | Trump faces day in court, a first in US |
| 2023-04-04T11:51:37ZFormer U.S. President Donald Trump walked into Trump Tower in Manhattan on Monday... |
 Reuters Reuters | 4h | |
|
|
|
 | Pakistan court orders provincial votes in win for ex-PM Khan |
| 2023-04-04T11:39:54ZPakistan's Supreme Court ordered on Tuesday that elections in two provinces should... |
 Reuters Reuters | 4h | |
|
|
|
| Daily Kickoff: Interview with Richmond's Levar Stoney + Passover in ... - Jewish... |
| Daily Kickoff: Interview with Richmond's Levar Stoney + Passover in ... Jewish Insider |
 "Biden in Kyiv 2023" - Google News "Biden in Kyiv 2023" - Google News | 4h | |
|
|
|
| Russia blames Ukraine for bomb that killed military blogger - Idaho Press |
| Russia blames Ukraine for bomb that killed military blogger Idaho Press |
 "Idaho murders" - Google News "Idaho murders" - Google News | 4h | |
|
|
|
| Photo Of Pope Francis With Two Women In A Hot Tub Is An AI-Generated Fake | BOOM... |
| Photo Of Pope Francis With Two Women In A Hot Tub Is An AI-Generated Fake | BOOM BOOM |
 "pope francis" - Google News "pope francis" - Google News | 4h | |
|
|
|
| Germany's Scholz Faces Possible Parliamentary Tax Fraud Probe - Barron's |
| Germany's Scholz Faces Possible Parliamentary Tax Fraud Probe Barron's |
 "scholz" - Google News "scholz" - Google News | 4h | |
|
|
|
 | Avalanche sweeps away tourists in northeast India; 6 killed |
| NEW DELHI (AP) — An avalanche swept away a group of tourists in the Himalayas in northeastern India on... |
 Associated Press News: Breaking News | Latest News Today Associated Press News: Breaking News | Latest News Today | 5h | |
|
|
|
 | Biden to meet with experts on AI 'risks and opportunities' |
| WASHINGTON (AP) — President Joe Biden on Tuesday will meet with his council of advisers on science and... |
 Associated Press News: Breaking News | Latest News Today Associated Press News: Breaking News | Latest News Today | 5h | |
|
|
|
| Spinal Surgical Devices Market Size 2023 – Industry Overview ... - Digital Journal |
| Spinal Surgical Devices Market Size 2023 – Industry Overview ... Digital Journal |
 "Intelligence Assessments of Russia Ukraine War 2022" - Google News "Intelligence Assessments of Russia Ukraine War 2022" - Google News | 5h | |
|
|
|
| Goods exports touched $447 billion in 2022-23; final numbers awaited: Piyush Goyal... |
| Goods exports touched $447 billion in 2022-23; final numbers awaited: Piyush Goyal The Economic Times |
 "russia-ukraine war 2022" - Google News "russia-ukraine war 2022" - Google News | 5h | |
|
|
|
| New variant of COVID-19's Omicron detected in Nepal, 10 confirmed cases found - ETHealthWorld |
| New variant of COVID-19's Omicron detected in Nepal, 10 confirmed cases found ETHealthWorld |
 "XBB.1.5" - Google News "XBB.1.5" - Google News | 5h | |
|
|
|
 | Here's A Better Pick Over Textron Stock |
| We believe that Boeing stock (NYSE: BA) is currently a better pick than Textron stock (NYSE: TXT) despite... |
 Markets and Business News Review Markets and Business News Review | 5h | |
|
|
|
 | The World’s Most Respected Brand |
| Brands are ranked in several ways. The brand-ranking business has become an industry of its own. Research... |
 Markets and Business News Review Markets and Business News Review | 5h | |
|
|
|
| Donald Trump set to be arraigned in historic court moment - Billings Gazette |
| Donald Trump set to be arraigned in historic court moment Billings Gazette |
 "Investigations of US Elections 2016" - Google News "Investigations of US Elections 2016" - Google News | 5h | |
|
|
|
| Japan rejects Russian Sovcombank's allegation that sanctions are ... - TODAY |
| Japan rejects Russian Sovcombank's allegation that sanctions are ... TODAY |
 "G7" - Google News "G7" - Google News | 5h | |
|
|
|
| Explained: Why India & Other BRICS Nations Want To Create A New Currency For Trade... |
| Explained: Why India & Other BRICS Nations Want To Create A New Currency For Trade Payments Indiatimes.com |
 "Russia - China new strategic alliance by Putin and Xi" - Google News "Russia - China new strategic alliance by Putin and Xi" - Google News | 5h | |
|
|
|
 | Bakhmut residents evacuated under heavy shelling |
| (4 Apr 2023) Under heavy shelling, evacuation from Bakhmut has become almost impossible for residents... |
 Associated Press Associated Press | 5h | |
|
|
|
| Finland set to join NATO, dealing major blow to Russia - WBKO |
| Finland set to join NATO, dealing major blow to Russia WBKO |
 "global threats to U.S. security 2023" - Google News "global threats to U.S. security 2023" - Google News | 5h | |
|
|
|
| Trump indictment live updates: Former president's arraignment expected today - NBC... |
| Trump indictment live updates: Former president's arraignment expected today NBC NewsDonald Trump to... |
 trump - Google News trump - Google News | 5h | |
|
|
|
| TikTok fined $15.9M by UK watchdog over misuse of kids' data |
| |
 All Stories All Stories | 5h | |
|
|
|
| Avalanche sweeps away tourists in northeast India; 7 killed |
| |
 All Stories All Stories | 5h | |
|
|
|
| Biden offers $450M for clean energy projects at coal mines |
| |
 All Stories All Stories | 5h | |
|
|
|
| Credit Suisse chairman admits failure, anger to shareholders |
| |
 All Stories All Stories | 5h | |
|
|
|
| Japan rejects Russian Sovcombank's allegation that sanctions are ... - Reuters |
| Japan rejects Russian Sovcombank's allegation that sanctions are ... Reuters |
 "G7 and Russia Ukraine war" - Google News "G7 and Russia Ukraine war" - Google News | 5h | |
|
|
|
| As Finland gets NATO membership, here's what it means and why it matters - Yahoo... |
| As Finland gets NATO membership, here's what it means and why it matters Yahoo News |
 "Will Russia turn to the West?" - Google News "Will Russia turn to the West?" - Google News | 5h | |
|
|
|
| Trump arraignment: What to expect during his arrest in Manhattan - MSNBC |
| Trump arraignment: What to expect during his arrest in Manhattan MSNBC |
 "Mar-a-Lago documents" - Google News "Mar-a-Lago documents" - Google News | 5h | |
|
|
|
| Ukraine war latest: 'High profile feud' likely prompting Russia to try to ... - Sky... |
| Ukraine war latest: 'High profile feud' likely prompting Russia to try to ... Sky News |
 "Gen. Gerasimov was wounded" - Google News "Gen. Gerasimov was wounded" - Google News | 5h | |
|
|
|
| Blame Biden for Deadly St. Petersburg Bombing, Putin Ally Says - The Daily Beast |
| Blame Biden for Deadly St. Petersburg Bombing, Putin Ally Says The Daily Beast |
 "Biden, Scholz, Macron, Putin" - Google News "Biden, Scholz, Macron, Putin" - Google News | 5h | |
|
|
|
| Goods exports touched $447 billion in 2022-23 — final numbers awaited, says Piyush... |
| Goods exports touched $447 billion in 2022-23 — final numbers awaited, says Piyush Goyal CNBCTV18 |
 "russia - ukraine war 2022" - Google News "russia - ukraine war 2022" - Google News | 5h | |
|
|
|
| EARTH CALLER // Renormalization Tour feat Sweden's Aviana and ... - Hysteria Mag |
| EARTH CALLER // Renormalization Tour feat Sweden's Aviana and ... Hysteria Mag |
 "aggressive rats in new york city" - Google News "aggressive rats in new york city" - Google News | 5h | |
|
|
|
| Trump v. New York - TBD - POLITICO - POLITICO |
| Trump v. New York - TBD - POLITICO POLITICO |
 "George Santos" - Google News "George Santos" - Google News | 5h | |
|
|
|
| George Santos Will Face Afghanistan Veteran in Primary Challenge - The Daily Beast |
| George Santos Will Face Afghanistan Veteran in Primary Challenge The Daily Beast |
 "George Santos" - Google News "George Santos" - Google News | 5h | |
|
|
|
| What to Know in Washington: Trump to Surrender, Plead Not Guilty ... - Bloomberg... |
| What to Know in Washington: Trump to Surrender, Plead Not Guilty ... Bloomberg Government |
 "George Santos" - Google News "George Santos" - Google News | 5h | |
|
|
|
| Oscar-Winning Composer Ryuichi Sakamoto Dies at 71 - The Daily Beast |
| Oscar-Winning Composer Ryuichi Sakamoto Dies at 71 The Daily Beast |
 "George Santos" - Google News "George Santos" - Google News | 5h | |
|
|
|
| Enemy Drops Guided Aerial Bombs On Kherson Region's Beryslav - MENAFN.COM |
| Enemy Drops Guided Aerial Bombs On Kherson Region's Beryslav MENAFN.COM |
 "kherson" - Google News "kherson" - Google News | 5h | |
|
|
|
| Thaci Voices 'Regrets And Pain' For Kosovo War Victims At Hague Trial - Radio Free... |
| Thaci Voices 'Regrets And Pain' For Kosovo War Victims At Hague Trial Radio Free Europe / Radio Liberty |
 "US Intel: Putin gave orders to invade Ukraine" - Google News "US Intel: Putin gave orders to invade Ukraine" - Google News | 5h | |
|
|
|
| Russia takes over presidency of UN Security Council; 'bad optics' for ... - Yahoo... |
| Russia takes over presidency of UN Security Council; 'bad optics' for ... Yahoo News |
 "US Intel: Putin gave orders to invade Ukraine" - Google News "US Intel: Putin gave orders to invade Ukraine" - Google News | 5h | |
|
|
|
| Ukrainian Writer Artem Chapeye On His Decision To Fight for His ... - Electric Literature |
| Ukrainian Writer Artem Chapeye On His Decision To Fight for His ... Electric Literature |
 "Russian troops enter Donbas" - Google News "Russian troops enter Donbas" - Google News | 5h | |
|
|
|
| Paranoid Vladimir Putin never uses phone and stays in his bunker, defector says -... |
| Paranoid Vladimir Putin never uses phone and stays in his bunker, defector says The Mirror |
 "Putin and Xi Jinping" - Google News "Putin and Xi Jinping" - Google News | 5h | |
|
|
|
| Russian university campus in China's Hainan to focus on aviation ... - South China... |
| Russian university campus in China's Hainan to focus on aviation ... South China Morning Post |
 "Putin and Xi Jinping" - Google News "Putin and Xi Jinping" - Google News | 5h | |
|
|
|
| China's renminbi replaces US dollar as most traded currency in Russia - The Straits... |
| China's renminbi replaces US dollar as most traded currency in Russia The Straits Times |
 "Putin and Xi Jinping" - Google News "Putin and Xi Jinping" - Google News | 5h | |
|
|
|
| China backs Putin's new foreign policy: Says ready to boost ties with Russia, India... |
| China backs Putin's new foreign policy: Says ready to boost ties with Russia, India OrissaPOST |
 "Putin and Xi Jinping" - Google News "Putin and Xi Jinping" - Google News | 5h | |
|
|
|
| Russia Ukraine War Bucha Anniversary | Nation/World | bdtonline.com - Bluefield Daily... |
| Russia Ukraine War Bucha Anniversary | Nation/World | bdtonline.com Bluefield Daily Telegraph |
 "Bucha" - Google News "Bucha" - Google News | 5h | |
|
|
|
| |
| Richard Branson's Virgin Orbit is filing for Chapter 11 bankruptcy protection after a failed mission... |
 The Associated Press (Twitter) The Associated Press (Twitter) | 5h | |
|
|
|
 | Around the world, criminal charges are no barrier to high office |
| Donald Trump may be the first former US president to face criminal charges, but around the world many... |
 CNN.com - Top Stories CNN.com - Top Stories | 5h | |
|
|
|
 | Finland's acceptance into NATO will present a blow to Vladimir Putin |
| • Live updates: Finland to become 31st NATO member, doubling military alliance's border with Russia •... |
 CNN.com - Top Stories CNN.com - Top Stories | 5h | |
|
|
|
 | Former Maryland governor's one-time chief of staff dies after confrontation with... |
| |
 CNN.com - Top Stories CNN.com - Top Stories | 5h | |
|
|
|
 | See deepest fish ever caught on camera |
| Scientists captured the unknown snailfish species at a depth of more than 27,000 feet, as part of an... |
 CNN.com - Top Stories CNN.com - Top Stories | 5h | |
|
|
|
| Finland gets 'ironclad security guarantee' as new NATO member ... - Anadolu Agency... |
| Finland gets 'ironclad security guarantee' as new NATO member ... Anadolu Agency | English |
 "Stoltenberg" - Google News "Stoltenberg" - Google News | 5h | |
|
|
|
| Putin triggered 'historic' Nordic enlargement of NATO - Stoltenberg - Reuters |
| Putin triggered 'historic' Nordic enlargement of NATO - Stoltenberg Reuters |
 "Stoltenberg" - Google News "Stoltenberg" - Google News | 5h | |
|
|
|
| Belarus warplanes have been upgraded so they can carry NUKES - Daily Mail |
| Belarus warplanes have been upgraded so they can carry NUKES Daily Mail |
 "shoigu" - Google News "shoigu" - Google News | 5h | |
|
|
|
 | No One Cares About Kamala Harris |
| That being said, Kamala Harris is inconsequential, quiet, and uninfluential through no choice of her... |
 19FortyFive 19FortyFive | 5h | |
|
|
|
| One dead, one detained after shooting in Southeast Memphis - WREG NewsChannel 3 |
| One dead, one detained after shooting in Southeast Memphis WREG NewsChannel 3 |
 "special counsel jack smith" - Google News "special counsel jack smith" - Google News | 5h | |
|
|
|
 | Virgin Media down leaving thousands across UK without internet - Metro.co.uk |
| Metro.co.uk |
 "twitter down" - Google News "twitter down" - Google News | 5h | |
|
|
|
| Carson Briere dismissed from Mercyhurst hockey team - TribLIVE |
| Carson Briere dismissed from Mercyhurst hockey team TribLIVE |
 "twitter down" - Google News "twitter down" - Google News | 5h | |
|
|
|
| Watch: Germany 'deeply ashamed' Berlin took so long to send Ukraine weapons - The... |
| Watch: Germany 'deeply ashamed' Berlin took so long to send Ukraine weapons The Telegraph |
 "weapons for ukraine" - Google News "weapons for ukraine" - Google News | 5h | |
|
|
|
 | Bringing Lolita home: How to release a long-captive orca? |
| SEATTLE (AP) — An ambitious plan announced last week to return Lolita, a killer whale held captive for... |
 Associated Press News: Breaking News | Latest News Today Associated Press News: Breaking News | Latest News Today | 5h | |
|
|
|
| Ghosting as a Symptom of Our Wounded World - Psychology Today |
| Ghosting as a Symptom of Our Wounded World Psychology Today |
 "covid -19 origins" - Google News "covid -19 origins" - Google News | 5h | |
|
|
|
 | Shares rise, but risks of inflation flare-up pick up |
| 2023-04-04T11:12:22ZGlobal stocks rose in cautious trade on Tuesday as investors grappled with the possibility... |
 Reuters Reuters | 5h | |
|
|
|
 | Chicago to elect new mayor as crime emerges as key issue |
| 2023-04-04T11:04:32ZThe skyline is seen in Chicago, Illinois, U.S., October 19, 2017. REUTERS/John... |
 Reuters Reuters | 5h | |
|
|
|
 | Finland"s NATO membership triggered by Putin"s invasion of Ukraine - Stoltenberg |
| 2023-04-04T11:14:42ZFinland will become a member of NATO on Tuesday, completing a historic security policy... |
 Reuters Reuters | 5h | |
|
|
|
 | Putin triggered "historic" Nordic enlargement of NATO - Stoltenberg |
| 2023-04-04T11:01:31ZRussian President Vladimir Putin has achieved the opposite of his Ukraine war aims... |
 Reuters Reuters | 5h | |
|
|
|
 | India avalanche kills seven on road to Tibet, more trapped |
| 2023-04-04T11:18:40ZAn avalanche in India's northeastern state of Sikkim on Tuesday killed at least seven... |
 Reuters Reuters | 5h | |
|
|
|
| Russia Assumes UNSC Chairmanship Amidst Global Outrage - SOFREP |
| Russia Assumes UNSC Chairmanship Amidst Global Outrage SOFREP |
 "Zelensky" - Google News "Zelensky" - Google News | 5h | |
|
|
|
| 'I have forgiven them' - Women kidnapped by Boko Haram met with ... - The Pillar |
| 'I have forgiven them' - Women kidnapped by Boko Haram met with ... The Pillar |
 "pope francis" - Google News "pope francis" - Google News | 5h | |
|
|
|
| Pope: no one can determine the identity of a nation or group - Aleteia |
| Pope: no one can determine the identity of a nation or group Aleteia |
 "pope francis" - Google News "pope francis" - Google News | 5h | |
|
|
|
| Lawyers screen potential jurors in Idaho slain kids' trial - Post Register |
| Lawyers screen potential jurors in Idaho slain kids' trial Post Register |
 "Idaho murders" - Google News "Idaho murders" - Google News | 5h | |
|
|
|
| Here are the Top 10 threats to the survival of civilization - Science News Magazine |
| Here are the Top 10 threats to the survival of civilization Science News Magazine |
 "global threats to U.S. security" - Google News "global threats to U.S. security" - Google News | 5h | |
|
|
|
 | #Opinion - Opinion: Religion and Spying #Religion #Spying This is a big issue:... |
| #Opinion - Opinion: Religion and Spying #Religion #Spying This is a big issue: ROC outside Russia, all... |
 The News And Times The News And Times | 5h | |
|
|
|
| Trilogy Metals Reports Best Grade-Thickness Intersection Ever ... - PR Newswire |
| Trilogy Metals Reports Best Grade-Thickness Intersection Ever ... PR Newswire |
 "g-7 2022" - Google News "g-7 2022" - Google News | 5h | |
|
|
|
 | Oil Extends Gains on OPEC+ Surprise Cuts |
| LONDON—Oil prices rose on Tuesday after OPEC+ plans to cut more production jolted markets the previous... |
 The Epoch Times | The Epoch Times The Epoch Times | The Epoch Times | 5h | |
|
|
|
 | Doctors Appeal Ruling in Favor of FDA Over Ivermectin Posts, Urge Court to Intervene |
| A group of doctors is urging a U.S. court to block the Food and Drug Administration (FDA) from issuing... |
 The Epoch Times | The Epoch Times The Epoch Times | The Epoch Times | 5h | |
|
|
|
 | ValueAct Questions Seven & I Strategy, Pushes 7-Eleven Spin-Off |
| NEW YORK—ValueAct Capital is pushing Seven & i Holdings to explain its corporate strategy to shareholders... |
 The Epoch Times | The Epoch Times The Epoch Times | The Epoch Times | 5h | |
|
|
|
 | Ben Affleck Hopes to Score Michael Jordan's Approval for Film 'Air' |
| LOS ANGELES—Actor Ben Affleck is hopeful for basketball legend Michael Jordan's seal of approval after... |
 The Epoch Times | The Epoch Times The Epoch Times | The Epoch Times | 5h | |
|
|
|
 | African Elephants Use Unique Body Odour to Communicate, Research Shows |
| African elephants use their unique sense of smell to communicate, distinguish their mates and outsiders,... |
 The Epoch Times | The Epoch Times The Epoch Times | The Epoch Times | 5h | |
|
|
|
 | FBI Jan. 6 Informant Says He Could Break the Law in Certain Situations |
| An FBI informant who joined the Proud Boys and helped breach the U.S. Capitol on Jan. 6, 2021, says there... |
 The Epoch Times | The Epoch Times The Epoch Times | The Epoch Times | 5h | |
|
|
|
 | Revlon Cleared to Exit Bankruptcy With $2.7 Billion Debt Reduction Deal |
| A U.S. judge on Monday approved Revlon Inc.'s reorganization plan, allowing the cosmetics maker to cut... |
 The Epoch Times | The Epoch Times The Epoch Times | The Epoch Times | 5h | |
|
|
|
| 'Paranoid Putin stays in bunker because he fears for his life' – live - The... |
| 'Paranoid Putin stays in bunker because he fears for his life' – live The Independent |
 "scholz and putin" - Google News "scholz and putin" - Google News | 5h | |
|
|
|
| Putin Says Russia Will Station Tactical Nuclear Weapons In Belarus - Radio Free Europe... |
| Putin Says Russia Will Station Tactical Nuclear Weapons In Belarus Radio Free Europe / Radio Liberty |
 "scholz and putin" - Google News "scholz and putin" - Google News | 5h | |
|
|
|
 | Australia bans TikTok from federal government devices |
| CANBERRA, Australia (AP) — Australia has become the last of the "Five Eyes" security partners to ban... |
 Associated Press News: Breaking News | Latest News Today Associated Press News: Breaking News | Latest News Today | 5h | |
|
|
|
| Crisis Management Market to cross $220 Bn by 2032, Says Global ... - GlobeNewswire |
| Crisis Management Market to cross $220 Bn by 2032, Says Global ... GlobeNewswire |
 "Intelligence Assessments of Russia Ukraine War 2022" - Google News "Intelligence Assessments of Russia Ukraine War 2022" - Google News | 5h | |
|
|
|
| Artificial Intelligence in Security, Public Safety and National Security ... - Digital... |
| Artificial Intelligence in Security, Public Safety and National Security ... Digital Journal |
 "Intelligence Assessments of Russia Ukraine War 2022" - Google News "Intelligence Assessments of Russia Ukraine War 2022" - Google News | 5h | |
|
|
|
| Artificial Intelligence (AI) Chip Market to Set New Heights: Analysis ... - Digital... |
| Artificial Intelligence (AI) Chip Market to Set New Heights: Analysis ... Digital Journal |
 "Intelligence Assessments of Russia Ukraine War 2022" - Google News "Intelligence Assessments of Russia Ukraine War 2022" - Google News | 5h | |
|
|
|
| Russia's war in Ukraine exacts heavy toll on women, says UNFPA | Women News - Al... |
| Russia's war in Ukraine exacts heavy toll on women, says UNFPA | Women News Al Jazeera English |
 "Russia-Ukraine war" - Google News "Russia-Ukraine war" - Google News | 5h | |
|
|
|
| Trump Prepares to Surrender, Plead Not Guilty in Manhattan Court - Bloomberg Law |
| Trump Prepares to Surrender, Plead Not Guilty in Manhattan Court Bloomberg Law |
 "Investigations of US Elections 2016" - Google News "Investigations of US Elections 2016" - Google News | 5h | |
|
|
|
| OPEC Stuns the World and Slashes Production: 7 ‘Strong Buy’ Dividend... |
| After catching some decent inflation data last week, the Federal Reserve probably could have had a better... |
 Markets and Business News Review Markets and Business News Review | 5h | |
|
|
|
 | All Things Considered, UConn Winning Fifth Final Four Is Worthy Of A Yawn |
| If you're counting, UConn now owns as many national championships in college basketball as Duke and Indiana.... |
 Markets and Business News Review Markets and Business News Review | 5h | |
|
|
|
 | Saudi Arabia Suffers 60% Fall In Inward Investment In Past Year |
| Foreign direct investment (FDI) into Saudi Arabia fell by 59% in 2022 compared to the year before, in... |
 Markets and Business News Review Markets and Business News Review | 5h | |
|
|
|
 | Trump's Arraignment: Here's What Time He'll Appear In Court And How To Get Updates |
| The president is slated to plead not guilty Tuesday afternoon. |
 Markets and Business News Review Markets and Business News Review | 5h | |
|
|
|
 | Raucous UConn NCAA championship celebrations |
| (4 Apr 2023) University of Connecticut students destroyed lampposts and stop signs after the UConn Huskies... |
 Associated Press Associated Press | 5h | |
|
|
|
 | On This Day: 4 April 2009 |
| (4 Apr 2023) In 2009, former Beatle bandmates Paul McCartney and Ringo Starr reunited on stage at Radio... |
 Associated Press Associated Press | 5h | |
|
|
|
| Ukrainian refugee starts anew due to family's Holocaust kindness - Los Angeles Times |
| Ukrainian refugee starts anew due to family's Holocaust kindness Los Angeles Times |
 "kharkiv" - Google News "kharkiv" - Google News | 5h | |
|
|
|
| Still under fire, Ukraine's Jews seek 'spiritual power' this Passover - eJewish Philanthropy |
| Still under fire, Ukraine's Jews seek 'spiritual power' this Passover eJewish Philanthropy |
 "kharkiv" - Google News "kharkiv" - Google News | 5h | |
|
|
|
| Shionogi Receives U.S. FDA Fast Track Designation for Ensitrelvir ... - Shionogi |
| Shionogi Receives U.S. FDA Fast Track Designation for Ensitrelvir ... Shionogi |
 "global threats to U.S. security 2023" - Google News "global threats to U.S. security 2023" - Google News | 5h | |
|
|
|
| Secretary Antony J. Blinken Remarks Before U.S.-EU Energy ... - Department of State |
| Secretary Antony J. Blinken Remarks Before U.S.-EU Energy ... Department of State |
 "global threats to U.S. security 2023" - Google News "global threats to U.S. security 2023" - Google News | 5h | |
|
|
|
| Donald Trump to surrender to history-making criminal charges - WHYY |
| Donald Trump to surrender to history-making criminal charges WHYY |
 "Mar-a-Lago" - Google News "Mar-a-Lago" - Google News | 5h | |
|
|
|
 | |
| Michael Novakhov retweeted: IT'S TIME FOR STRANGE... |
 Tweets by @mikenov Tweets by @mikenov | 5h | |
|
|
|
 | |
| #VladlenTatarsky #GRU #RussianGenerals Was Vladlen Tatarsky liquidated by the GRU to control the information... |
 Tweets by @mikenov Tweets by @mikenov | 5h | |
|
|
|
 | |
| Was Vladlen Tatarsky liquidated by the GRU? - Google Search google.com/search?q=Was+Vlad… |
 Tweets by @mikenov Tweets by @mikenov | 5h | |
|
|
|
 | |
| Michael Novakhov retweeted: It's full of #FSB... |
 Tweets by @mikenov Tweets by @mikenov | 5h | |
|
|
|
 | |
| Michael Novakhov retweeted: 16/2 lesion is... |
 Tweets by @mikenov Tweets by @mikenov | 5h | |
|
|
|
 | |
| Michael Novakhov retweeted: Reactions on #tatarsky... |
 Tweets by @mikenov Tweets by @mikenov | 5h | |
|
|
|
| |
| Michael Novakhov retweeted: 16/16 send them... |
 Tweets by @mikenov Tweets by @mikenov | 5h | |
|
|
|
| |
| Michael Novakhov retweeted: 16/15 Motorolls... |
 Tweets by @mikenov Tweets by @mikenov | 5h | |
|
|
|
| |
| Michael Novakhov retweeted: 16/14 chosen to... |
 Tweets by @mikenov Tweets by @mikenov | 5h | |
|
|
|
| |
| Michael Novakhov retweeted: 16/13 agenda "#Svo"... |
 Tweets by @mikenov Tweets by @mikenov | 5h | |
|
|
|
| |
| Michael Novakhov retweeted: 16/12 the last... |
 Tweets by @mikenov Tweets by @mikenov | 5h | |
|
|
|
| |
| Michael Novakhov retweeted: 16/11 of a similar... |
 Tweets by @mikenov Tweets by @mikenov | 5h | |
|
|
|
| |
| Michael Novakhov retweeted: 16/10 to the work... |
 Tweets by @mikenov Tweets by @mikenov | 5h | |
|
|
|
| |
| Michael Novakhov retweeted: 16/9 to dispose... |
 Tweets by @mikenov Tweets by @mikenov | 5h | |
|
|
|
 | |
| Michael Novakhov retweeted: 16/8 worthy of... |
 Tweets by @mikenov Tweets by @mikenov | 5h | |
|
|
|
 | |
| Michael Novakhov retweeted: 16/4 university... |
 Tweets by @mikenov Tweets by @mikenov | 5h | |
|
|
|
| UPDATE 1-US, EU vow to combat any attempts to disrupt energy markets - Yahoo Finance |
| UPDATE 1-US, EU vow to combat any attempts to disrupt energy markets Yahoo Finance |
 "G7 and Russia Ukraine war" - Google News "G7 and Russia Ukraine war" - Google News | 5h | |
|
|
|
| Trump set to surrender in New York following hush money indictment - The Guardian... |
| Trump set to surrender in New York following hush money indictment The Guardian US |
 trump - Google News trump - Google News | 5h | |
|
|
|
| Trump Indictment: Why It's So Hard to Forecast What Comes Next - Barron's |
| Trump Indictment: Why It's So Hard to Forecast What Comes Next Barron's |
 trump - Google News trump - Google News | 5h | |
|
|
|
| Live Updates: Trump's Arraignment Will Not Be Televised, Judge ... - Business Insider |
| Live Updates: Trump's Arraignment Will Not Be Televised, Judge ... Business Insider |
 trump - Google News trump - Google News | 5h | |
|
|
|
| Chris Christie takes wait-and-see approach to Trump indictment news - POLITICO |
| Chris Christie takes wait-and-see approach to Trump indictment news POLITICO |
 trump - Google News trump - Google News | 5h | |
|
|
|
| UConn emerges victorious after March Madness full of upsets |
| |
 All Stories All Stories | 5h | |
|
|
|
| Virgin Orbit seeks bankruptcy protection after mission fail |
| |
 All Stories All Stories | 5h | |
|
|
|
| Webby Award nominations for Harry Styles, Lizzo, Post Malone |
| |
 All Stories All Stories | 5h | |
|
|
|
| West Texas Intermediate to join global crude oil benchmark - Houston Chronicle |
| West Texas Intermediate to join global crude oil benchmark Houston Chronicle |
 "Will Russia turn to the West?" - Google News "Will Russia turn to the West?" - Google News | 5h | |
|
|
|
| Oil producers' cuts could boost gasoline prices, help Russia - Escanaba Daily Press |
| Oil producers' cuts could boost gasoline prices, help Russia Escanaba Daily Press |
 "Will Russia turn to the West?" - Google News "Will Russia turn to the West?" - Google News | 5h | |
|
|
|
| What's expected from Trump court appearance - Yahoo News |
| What's expected from Trump court appearance Yahoo News |
 "Mar-a-Lago documents" - Google News "Mar-a-Lago documents" - Google News | 5h | |
|
|
|
| Ukrainian POWs returned from Russia captivity |
| AP correspondent Charles de Ledesma reports on Russia Ukraine War POWs. |
 AP Audio Wire AP Audio Wire | 5h | |
|
|
|
| Tennessee GOP members move to oust 3 Dems after gun protest |
| AP correspondent Jennifer King reports on Tennessee Lawmakers Expulsion |
 AP Audio Wire AP Audio Wire | 5h | |
|
|
|
| Approximately $140 Million Available for Wildlife Habitat Projects ... - Oil City... |
| Approximately $140 Million Available for Wildlife Habitat Projects ... Oil City Derrick |
 "Biden, Scholz, Macron, Putin" - Google News "Biden, Scholz, Macron, Putin" - Google News | 5h | |
|
|
|
| Avalanche sweeps away tourists in northeast India; 6 killed - Oil City Derrick |
| Avalanche sweeps away tourists in northeast India; 6 killed Oil City Derrick |
 "Biden, Scholz, Macron, Putin" - Google News "Biden, Scholz, Macron, Putin" - Google News | 5h | |
|
|
|
| Montenegro's new president says country firmly on EU path - Oil City Derrick |
| Montenegro's new president says country firmly on EU path Oil City Derrick |
 "Biden, Scholz, Macron, Putin" - Google News "Biden, Scholz, Macron, Putin" - Google News | 5h | |
|
|
|
| Trump May Be Swabbed For DNA Sample Upon Surrender. How Might His DNA Be Used? -... |
| Trump May Be Swabbed For DNA Sample Upon Surrender. How Might His DNA Be Used? Forbes |
 "FBI AND ITS ROLE IN ELECTION 2016" - Google News "FBI AND ITS ROLE IN ELECTION 2016" - Google News | 5h | |
|
|
|
| Ukraine updates: Diplomat condemns German peace appeal - DW |
| Ukraine updates: Diplomat condemns German peace appeal DW |
 "Blinken: US to lead international Russia-Ukraine bloc against China" - Google News "Blinken: US to lead international Russia-Ukraine bloc against China" - Google News | 5h | |
|
|
|
| Ukraine: Education Sector Assessment in Conflict-Affected Areas ... - ReliefWeb |
| Ukraine: Education Sector Assessment in Conflict-Affected Areas ... ReliefWeb |
 "Ukraine" - Google News "Ukraine" - Google News | 5h | |
|
|
|
| Ukraine says city of Kostyantynivka hit by heavy Russian shelling - Euronews |
| Ukraine says city of Kostyantynivka hit by heavy Russian shelling Euronews |
 "Ukraine" - Google News "Ukraine" - Google News | 5h | |
|
|
|
| Officials: US providing Ukraine $2.6 billion in military aid - The New Indian Express |
| Officials: US providing Ukraine $2.6 billion in military aid The New Indian Express |
 "kherson" - Google News "kherson" - Google News | 5h | |
|
|
|
| Ukraine deputy minister praises Japan PM's visit to Kyiv, Bucha - Kyodo News Plus |
| Ukraine deputy minister praises Japan PM's visit to Kyiv, Bucha Kyodo News Plus |
 "Bucha" - Google News "Bucha" - Google News | 5h | |
|
|
|
| 'A bad joke': Ukraine cries foul as Russia takes the reins of the UN ... - msnNOW |
| 'A bad joke': Ukraine cries foul as Russia takes the reins of the UN ... msnNOW |
 "Biden: Putin's war on Ukraine is a genocide" - Google News "Biden: Putin's war on Ukraine is a genocide" - Google News | 5h | |
|
|
|
 | |
| The Associated Press retweeted: SHOWBIZ MINUTE:... |
 The Associated Press (Twitter) The Associated Press (Twitter) | 5h | |
|
|
|
| |
| Former President Donald Trump is set to appear in court for his arraignment. He will be booked, though... |
 The Associated Press (Twitter) The Associated Press (Twitter) | 5h | |
|
|
|
| The Underlying Message from Putin and Xi: War is Coming - The Cipher Brief |
| The Underlying Message from Putin and Xi: War is Coming The Cipher Brief |
 "Putin and Xi Jinping" - Google News "Putin and Xi Jinping" - Google News | 5h | |
|
|
|
| NATO not interested in "freezing" war in Ukraine - Stoltenberg - Ukrinform |
| NATO not interested in "freezing" war in Ukraine - Stoltenberg Ukrinform |
 "Stoltenberg" - Google News "Stoltenberg" - Google News | 5h | |
|
|
|
| We Ignore the 'Lippmann Gap' at Our Peril - RealClearDefense |
| We Ignore the 'Lippmann Gap' at Our Peril RealClearDefense |
 "Air Superiority Over Ukraine" - Google News "Air Superiority Over Ukraine" - Google News | 5h | |
|
|
|
| EU lashes out at China for support of Russia in Ukraine war - ABC News |
| EU lashes out at China for support of Russia in Ukraine war ABC News |
 "russia-ukraine war" - Google News "russia-ukraine war" - Google News | 5h | |
|
|
|
| US to provide Ukraine $2.6 billion to buy munitions, radar, weapons ... - Republic... |
| US to provide Ukraine $2.6 billion to buy munitions, radar, weapons ... Republic World |
 "weapons for ukraine" - Google News "weapons for ukraine" - Google News | 5h | |
|
|
|
| Rheinmetall to Open Maintenance Hub in Romania for Ukraine Weapons - The Defense... |
| Rheinmetall to Open Maintenance Hub in Romania for Ukraine Weapons The Defense Post |
 "weapons for ukraine" - Google News "weapons for ukraine" - Google News | 5h | |
|
|
|
 | EagleCam shows heavy winds blow nest from tree; eaglet dies |
| MINNEAPOLIS (AP) — Viewers of the Minnesota Department of Natural Resources EagleCam were heartbroken... |
 Associated Press News: Breaking News | Latest News Today Associated Press News: Breaking News | Latest News Today | 5h | |
|
|
|
 | AP Headline News - Apr 04 2023 07:00 (EDT) |
| |
 Associated Press Bulletins Associated Press Bulletins | 5h | |
|
|
|
| Shanghai Film Festival Sets Dates; Tolley Shields Exits Netflix; ‘Ralph & Katie’... |
| Shanghai Film Festival Sets Dates; Tolley Shields Exits Netflix; 'Ralph & Katie' Training; 'Sweet... |
 "project raven" - Google News "project raven" - Google News | 5h | |
|
|
|
| Alexander Rodnyansky On Fleeing Russia, Supporting Ukraine Talent & Why He Feels... |
| Alexander Rodnyansky On Fleeing Russia, Supporting Ukraine Talent & Why He Feels "Responsible For... |
 "project raven" - Google News "project raven" - Google News | 5h | |
|
|
|
 | Russia: Finland"s NATO accession carries risk of escalation |
| 2023-04-04T10:47:49ZFinnish and NATO flags are seen printed on paper this illustration taken April 13,... |
 Reuters Reuters | 5h | |
|
|
|
 | US to detail plan to draw clean energy into oil, coal communities |
| 2023-04-04T10:52:50ZA pile of coal in an active coal mine located next to a new solar power plant development... |
 Reuters Reuters | 5h | |
|
|
|
 | India avalanche kills six, injures 30 and traps many more - police |
| 2023-04-04T10:53:38ZAn avalanche in India's northeastern state of Sikkim on Tuesday killed at least six... |
 Reuters Reuters | 5h | |
|
|
|
 | Analysis: Russia"s military production, state splurge ease sanctions pain |
| 2023-04-04T10:36:48ZWorkers install Christmas and New Year decorations next to "Z", "V" and "O" symbols... |
 Reuters Reuters | 5h | |
|
|
|
| Idaho murder victim's boyfriend poses with survivor dog and her new niece - The Independent |
| Idaho murder victim's boyfriend poses with survivor dog and her new niece The Independent |
 "Idaho murders" - Google News "Idaho murders" - Google News | 5h | |
|
|
|
| Zelensky to UN nuclear watchdog: Russia holds nuclear plant hostage - RNZ |
| Zelensky to UN nuclear watchdog: Russia holds nuclear plant hostage RNZ |
 "Zelensky" - Google News "Zelensky" - Google News | 5h | |
|
|
|
| Biden's Coup In Israel - Gatestone Institute |
| Biden's Coup In Israel Gatestone Institute |
 "Biden in Israel" - Google News "Biden in Israel" - Google News | 5h | |
|
|
|
| Rights Groups Call For 'Immediate' Release Of Tajik Lawyer Kholiknazarov - Radio... |
| Rights Groups Call For 'Immediate' Release Of Tajik Lawyer Kholiknazarov Radio Free Europe / Radio Liberty |
 "scholz and putin" - Google News "scholz and putin" - Google News | 5h | |
|
|
|
| Europe's Dangerous Dependence on China - Carnegie Europe |
| Europe's Dangerous Dependence on China Carnegie Europe |
 "scholz and putin" - Google News "scholz and putin" - Google News | 5h | |
|
|
|
| Russia Allows $1.2 Billion Sakhalin-2 Payment To Shell - Radio Free Europe / Radio... |
| Russia Allows $1.2 Billion Sakhalin-2 Payment To Shell Radio Free Europe / Radio Liberty |
 "scholz and putin" - Google News "scholz and putin" - Google News | 5h | |
|
|
|
| Russian Independent Journalists Call For Release Of WSJ Reporter - Radio Free Europe... |
| Russian Independent Journalists Call For Release Of WSJ Reporter Radio Free Europe / Radio Liberty |
 "scholz and putin" - Google News "scholz and putin" - Google News | 5h | |
|
|
|
 | Hendrick Gets Big Win Off Track, Emotional Victory on Track |
| What a week for Hendrick Motorsports, which scored its first victory in NASCAR's version of a courtroom... |
 The Epoch Times | The Epoch Times The Epoch Times | The Epoch Times | 5h | |
|
|
|
| German opposition seeks inquiry over Scholz and tax scheme - ABC News |
| German opposition seeks inquiry over Scholz and tax scheme ABC News |
 "scholz" - Google News "scholz" - Google News | 5h | |
|
|
|
 | Rafael Nadal pulls out of clay-court Monte Carlo Masters |
| MONACO (AP) — Rafael Nadal pulled out of the clay-court Monte Carlo Masters on Tuesday, saying he is... |
 Associated Press News: Breaking News | Latest News Today Associated Press News: Breaking News | Latest News Today | 6h | |
|
|
|
| Boxboards Market Size Estimates and Forecasts to 2028 - Digital Journal |
| Boxboards Market Size Estimates and Forecasts to 2028 Digital Journal |
 "Intelligence Assessments of Russia Ukraine War 2022" - Google News "Intelligence Assessments of Russia Ukraine War 2022" - Google News | 6h | |
|
|
|
| Espresso coffee market size to grow by USD 4,559.96 million between 2022 and 2027;... |
| Espresso coffee market size to grow by USD 4,559.96 million between 2022 and 2027; Growing demand for... |
 "Intelligence Assessments of Russia Ukraine War 2022" - Google News "Intelligence Assessments of Russia Ukraine War 2022" - Google News | 6h | |
|
|
|
| Donald Trump Prepares to Surrender - The New York Times |
| Donald Trump Prepares to Surrender The New York Times |
 "James Comey" - Google News "James Comey" - Google News | 6h | |
|
|
|
| China seethes as US chip controls threaten tech ambitions |
| AP correspondent Charles de Ledesma reports on China US Tech Battle. |
 AP Audio Wire AP Audio Wire | 6h | |
|
|
|
| Russia ready for meeting between Lavrov, Blinken; Ukraine war, arrest of WSJ journo... |
| Russia ready for meeting between Lavrov, Blinken; Ukraine war, arrest of WSJ journo on top agenda India... |
 "Russia-Ukraine war" - Google News "Russia-Ukraine war" - Google News | 6h | |
|
|
|
| EU lashes out at China for support of Russia in Ukraine war - The Seattle Times |
| EU lashes out at China for support of Russia in Ukraine war The Seattle Times |
 "Russia-Ukraine war" - Google News "Russia-Ukraine war" - Google News | 6h | |
|
|
|
| China warns of 'nuclear sword' dangling over world - 9News |
| China warns of 'nuclear sword' dangling over world 9News |
 "Russia-Ukraine war" - Google News "Russia-Ukraine war" - Google News | 6h | |
|
|
|
 | |
| Important discussion at today's U.S.-EU Energy Council on our support for Ukraine and Moldova's critical... |
 Secretary Antony Blinken (Twitter) Secretary Antony Blinken (Twitter) | 6h | |
|
|
|
| Global Healthcare Fabrics Market Report 2023: Sector to Reach ... - GlobeNewswire |
| Global Healthcare Fabrics Market Report 2023: Sector to Reach ... GlobeNewswire |
 "russia-ukraine war 2022" - Google News "russia-ukraine war 2022" - Google News | 6h | |
|
|
|
| Goods Exports Touched $447 Billion In 2022-23; Final Numbers Awaited: Piyush Goyal... |
| Goods Exports Touched $447 Billion In 2022-23; Final Numbers Awaited: Piyush Goyal Outlook India |
 "russia-ukraine war 2022" - Google News "russia-ukraine war 2022" - Google News | 6h | |
|
|
|
| Future of Wall Street Journal's detained reporter depends on court ... - news.webindia123.com |
| Future of Wall Street Journal's detained reporter depends on court ... news.webindia123.com |
 "blinken and lavrov" - Google News "blinken and lavrov" - Google News | 6h | |
|
|
|
| Virgin Media glitch leaves thousands of UK customers without broadband |
| More than 28,000 reported connectivity problems this morning |
 Markets and Business News Review Markets and Business News Review | 6h | |
|
|
|
| Sterling hits 10-month high as recession fears ease |
| Investors bet on further Bank of England interest rate rises as UK weathers banking turmoil |
 Markets and Business News Review Markets and Business News Review | 6h | |
|
|
|
| Is UBS the new Swiss government (bond)? |
| Too Zug to fail |
 Markets and Business News Review Markets and Business News Review | 6h | |
|
|
|
 | UBS Stock Is Trading Below Its Fair Value |
| UBS' stock (NYSE: UBS) has gained 14% YTD, whereas the S&P500 has increased 7% over the same period.... |
 Markets and Business News Review Markets and Business News Review | 6h | |
|
|
|
 | Journalists wait outside court for Trump arraignment |
| (4 Apr 2023) Journalists waited outside a New York City courthouse early Tuesday, with an extraordinary... |
 Associated Press Associated Press | 6h | |
|
|
|
 | Emergency workers at train crash site in Netherlands |
| (4 Apr 2023) One person died and some 30 passengers were injured, many of them seriously, when a train... |
 Associated Press Associated Press | 6h | |
|
|
|
| EU-China ties determined by Beijing's support for Russia - Borrell - Euronews |
| EU-China ties determined by Beijing's support for Russia - Borrell Euronews |
 "Russia - China new strategic alliance by Putin and Xi" - Google News "Russia - China new strategic alliance by Putin and Xi" - Google News | 6h | |
|
|
|
| Officials: US providing Ukraine $2.6 billion in military aid - WTOP |
| Officials: US providing Ukraine $2.6 billion in military aid WTOP |
 "russia-ukraine war news" - Google News "russia-ukraine war news" - Google News | 6h | |
|
|
|
| RESTRICT Act Is a Threat to Digital Freedom - PIA VPN - Privacy News Online |
| RESTRICT Act Is a Threat to Digital Freedom - PIA VPN Privacy News Online |
 "global threats to U.S. security 2023" - Google News "global threats to U.S. security 2023" - Google News | 6h | |
|
|
|
| Quick Hits April 4, 2023 - Odessa American |
| Quick Hits April 4, 2023 Odessa American |
 "Odessa" - Google News "Odessa" - Google News | 6h | |
|
|
|
| Motorcycle crash in Lafayette County injures Odessa man - KMZU |
| Motorcycle crash in Lafayette County injures Odessa man KMZU |
 "Odessa" - Google News "Odessa" - Google News | 6h | |
|
|
|
| Russell Co. in single digits with new COVID cases this week - Laker Country |
| Russell Co. in single digits with new COVID cases this week Laker Country |
 "COVID" - Google News "COVID" - Google News | 6h | |
|
|
|
 | NTD Good Morning (April 4): Trump Indictment Information Leaked; Virginia Teacher... |
| The latest news on Former President Trump's arraignment. We have a reporter on the ground, and speak... |
 The Epoch Times | The Epoch Times The Epoch Times | The Epoch Times | 6h | |
|
|
|
 | Oscar Pistorius's Lawyer: 'Mistake' to Deny Parole, Appealing |
| CAPE TOWN, South Africa—There was an "obvious mistake" in the process to deny Oscar Pistorius parole... |
 The Epoch Times | The Epoch Times The Epoch Times | The Epoch Times | 6h | |
|
|
|
 | Hawaii Authorities Say 33 Swimmers Were Harassing Dolphins |
| HONOLULU—Hawaii authorities said they have referred 33 people to U.S. law enforcement after the group... |
 The Epoch Times | The Epoch Times The Epoch Times | The Epoch Times | 6h | |
|
|
|
 | Trump Fundraising Soars to $7 Million in Just 3 Days After Indictment |
| Donations have soared to former President Donald Trump's campaign, with $7 million raised in just three... |
 The Epoch Times | The Epoch Times The Epoch Times | The Epoch Times | 6h | |
|
|
|
 | Shares Rise, but Concern Mounts Over Inflation Flare-Up |
| LONDON—Global stocks rose in cautious trade on Tuesday as investors grappled with the possibility of... |
 The Epoch Times | The Epoch Times The Epoch Times | The Epoch Times | 6h | |
|
|
|
 | Nashville Police: School Shooter Planned Attack for Months |
| NASHVILLE, Tenn.—Police said the person who killed six people, including three 9-year-old children, at... |
 The Epoch Times | The Epoch Times The Epoch Times | The Epoch Times | 6h | |
|
|
|
 | VIDEO: Horse Makes Snow Angels With Her Owner 'Like We Did as Kids,' and See How... |
| A beautiful New Hampshire horse has been caught on camera imitating her owner by laying on the ground... |
 The Epoch Times | The Epoch Times The Epoch Times | The Epoch Times | 6h | |
|
|
|
 | |
| #Opinion - Opinion: Religion and Spying #Religion #Spying This is a big issue: ROC outside Russia,... |
 Tweets by @mikenov Tweets by @mikenov | 6h | |
|
|
|
 | |
| Religion and Spying - Google Search google.com/search?q=Religion… |
 Tweets by @mikenov Tweets by @mikenov | 6h | |
|
|
|
 | |
| Michael Novakhov retweeted: Hristo Grozev @christogrozev,... |
 Tweets by @mikenov Tweets by @mikenov | 6h | |
|
|
|
 | |
| Michael Novakhov retweeted: 16/1 200 grams... |
 Tweets by @mikenov Tweets by @mikenov | 6h | |
|
|
|
| |
| GRU #GRU "Many people could have wanted to kill Vladlen Tatarsky, the pro-war Russian blogger who died... |
 Tweets by @mikenov Tweets by @mikenov | 6h | |
|
|
|
 | |
| Michael Novakhov retweeted: "Putin (strategic... |
 Tweets by @mikenov Tweets by @mikenov | 6h | |
|
|
|
| |
| Michael Novakhov retweeted: 60 млн евро инвестирует... |
 Tweets by @mikenov Tweets by @mikenov | 6h | |
|
|
|
 | |
| Michael Novakhov retweeted: OTD April 4, 1906... |
 Tweets by @mikenov Tweets by @mikenov | 6h | |
|
|
|
| News reports say avalanche in India's northeastern Sikkim state kills at least six... |
| |
 All Stories All Stories | 6h | |
|
|
|
| Michigan Republicans defend former President Trump amid indictment - Axios |
| Michigan Republicans defend former President Trump amid indictment Axios |
 trump - Google News trump - Google News | 6h | |
|
|
|
| Opinion | Will Trump See Justice? New Yorkers Are Dubious. - The New York Times |
| Opinion | Will Trump See Justice? New Yorkers Are Dubious. The New York Times |
 trump - Google News trump - Google News | 6h | |
|
|
|
| Trump indictment: 'I worry for the times ahead' - BBC |
| Trump indictment: 'I worry for the times ahead' BBC |
 trump - Google News trump - Google News | 6h | |
|
|
|
| Pakistan court rules delay of provinces' votes unlawful - Oil City Derrick |
| Pakistan court rules delay of provinces' votes unlawful Oil City Derrick |
 "Biden, Scholz, Macron, Putin" - Google News "Biden, Scholz, Macron, Putin" - Google News | 6h | |
|
|
|
| Why Russia is Still Losing the Ukraine War - AGF Perspectives |
| Why Russia is Still Losing the Ukraine War AGF Perspectives |
 "Putin and Xi" - Google News "Putin and Xi" - Google News | 6h | |
|
|
|
| Klopp 'feels it's time to leave' Liverpool after 'informal exchanges' with 'number... |
| Klopp 'feels it's time to leave' Liverpool after 'informal exchanges' with 'number one' suitors Yahoo... |
 "Is Putin MAD?" - Google News "Is Putin MAD?" - Google News | 6h | |
|
|
|
| Russia is counting on 'Ukraine fatigue' to overwhelm us with its ... - Euronews |
| Russia is counting on 'Ukraine fatigue' to overwhelm us with its ... Euronews |
 "russia - ukraine war 2022" - Google News "russia - ukraine war 2022" - Google News | 6h | |
|
|
|
| Playbook: Trump comes home to face the music - POLITICO |
| Playbook: Trump comes home to face the music POLITICO |
 "George Santos" - Google News "George Santos" - Google News | 6h | |
|
|
|
| Fox News Host Accidentally Mocks His Own Network's Trump Coverage - Yahoo Eurosport... |
| Fox News Host Accidentally Mocks His Own Network's Trump Coverage Yahoo Eurosport UK |
 "George Santos" - Google News "George Santos" - Google News | 6h | |
|
|
|
| Embattled NY Rep. George Santos has a challenger, with Kellen Curry running in GOP... |
| Embattled NY Rep. George Santos has a challenger, with Kellen Curry running in GOP primary Yahoo News |
 "George Santos" - Google News "George Santos" - Google News | 6h | |
|
|
|
| At a Graphical Growth AI-powered Video Analytics Market is ... - Digital Journal |
| At a Graphical Growth AI-powered Video Analytics Market is ... Digital Journal |
 "intelligence assessments and analysis of the Russia - Ukraine War 2022" - Google News "intelligence assessments and analysis of the Russia - Ukraine War 2022" - Google News | 6h | |
|
|
|
| Pakistani Top Court Orders Snap Polls In Two Provinces By May 15 - Radio Free Europe... |
| Pakistani Top Court Orders Snap Polls In Two Provinces By May 15 Radio Free Europe / Radio Liberty |
 "US Intel: Putin gave orders to invade Ukraine" - Google News "US Intel: Putin gave orders to invade Ukraine" - Google News | 6h | |
|
|
|
| Enemy drops guided aerial bombs on Kherson region's Beryslav - Ukrinform |
| Enemy drops guided aerial bombs on Kherson region's Beryslav Ukrinform |
 "kherson" - Google News "kherson" - Google News | 6h | |
|
|
|
| |
| @TheStudyofWar Investigative project "Sistema" reported on Mar. 10 that Russian security officials told... |
 ISW (Twitter) ISW (Twitter) | 6h | |
|
|
|
 | |
| #Russian security services reportedly continue to confiscate the passports of senior officials and state... |
 ISW (Twitter) ISW (Twitter) | 6h | |
|
|
|
| |
| @TheStudyofWar The #Wagner Group likely will continue attempts to consolidate control of central #Bakhmut... |
 ISW (Twitter) ISW (Twitter) | 6h | |
|
|
|
| |
| @TheStudyofWar #Russian forces made further advances [in #Bakhmut] on April 3, with drone footage posted... |
 ISW (Twitter) ISW (Twitter) | 6h | |
|
|
|
 | |
| Wagner financier Prigozhin raised a 🇷🇺 flag in memory of assassinated milblogger Maksim Fomin across... |
 ISW (Twitter) ISW (Twitter) | 6h | |
|
|
|
 | |
| NEW: #Wagner Group fighters made further advances in central #Bakhmut and seized the Bakhmut City Administration... |
 ISW (Twitter) ISW (Twitter) | 6h | |
|
|
|
 | |
| ISW retweeted: NEW | The #Israel Defense Force... |
 ISW (Twitter) ISW (Twitter) | 6h | |
|
|
|
 | |
| Here are today's control-of-terrain maps of #Russia's invasion of #Ukraine from @TheStudyofWar and @criticalthreats.... |
 ISW (Twitter) ISW (Twitter) | 6h | |
|
|
|
 | |
| New: Today's report discusses the assassination of prominent pro-war Russian milblogger Maksim Fomin... |
 ISW (Twitter) ISW (Twitter) | 6h | |
|
|
|
| Live blog: Ukraine destroys 14 out of 17 drones Russia launched overnight - TRT World |
| Live blog: Ukraine destroys 14 out of 17 drones Russia launched overnight TRT World |
 "Scholz, Macron, Putin" - Google News "Scholz, Macron, Putin" - Google News | 6h | |
|
|
|
| |
| An extraordinary moment in U.S. history is scheduled to unfold in a New York City courthouse. Former... |
 The Associated Press (Twitter) The Associated Press (Twitter) | 6h | |
|
|
|
| Russia: Finland's NATO accession carries risk of escalation - National Post |
| Russia: Finland's NATO accession carries risk of escalation National Post |
 "shoigu" - Google News "shoigu" - Google News | 6h | |
|
|
|
 | Trump's appearance set to be a surreal moment in US history |
| Donald Trump will officially become the first former president to face criminal charges Tuesday when... |
 CNN.com - Top Stories CNN.com - Top Stories | 6h | |
|
|
|
| US review of Afghanistan withdrawal to be released in April - WTVM |
| US review of Afghanistan withdrawal to be released in April WTVM |
 "National Security Council" - Google News "National Security Council" - Google News | 6h | |
|
|
|
| Ukraine: Collapse and 'fragmentation' of Russia 'already underway' - Metro.co.uk |
| Ukraine: Collapse and 'fragmentation' of Russia 'already underway' Metro.co.uk |
 "Russians halt their offensive in Ukraine" - Google News "Russians halt their offensive in Ukraine" - Google News | 6h | |
|
|
|
| Europe Faces Narrow Path In Balancing Relations With China As Macron Goes To Beijing... |
| Europe Faces Narrow Path In Balancing Relations With China As Macron Goes To Beijing Radio Free Europe... |
 "Putin and Xi Jinping" - Google News "Putin and Xi Jinping" - Google News | 6h | |
|
|
|
| Lithuanian Secret Services Say Russia Ready For Two More Years Of War - Radio Free... |
| Lithuanian Secret Services Say Russia Ready For Two More Years Of War Radio Free Europe / Radio Liberty |
 "Kaliningrad oblast, lithuania, ukraine, nato" - Google News "Kaliningrad oblast, lithuania, ukraine, nato" - Google News | 6h | |
|
|
|
| Ukraine war: Russian winter offensive falling short of Kremlin's goals ... - Euronews |
| Ukraine war: Russian winter offensive falling short of Kremlin's goals ... Euronews |
 "russia-ukraine war" - Google News "russia-ukraine war" - Google News | 6h | |
|
|
|
 | Biden offers $450M for clean energy projects at coal mines |
| WASHINGTON (AP) — President Joe Biden's administration is making $450 million available for solar farms... |
 Associated Press News: Breaking News | Latest News Today Associated Press News: Breaking News | Latest News Today | 6h | |
|
|
|
| Donald Trump has already been indicted once. More indictments could be coming. -... |
| Donald Trump has already been indicted once. More indictments could be coming. Vox.com |
 "special counsel jack smith" - Google News "special counsel jack smith" - Google News | 6h | |
|
|
|
| Ukraine's tech entrepreneurs fight war on a different front - Reuters |
| Ukraine's tech entrepreneurs fight war on a different front Reuters |
 "Israel and Russia- Ukraine war 2022" - Google News "Israel and Russia- Ukraine war 2022" - Google News | 6h | |
|
|
|
| EU slams China for siding with 'aggressor' in Ukraine war - South China Morning Post |
| EU slams China for siding with 'aggressor' in Ukraine war South China Morning Post |
 "weapons for ukraine" - Google News "weapons for ukraine" - Google News | 6h | |
|
|
|
 | Ukraine"s tech entrepreneurs fight war on a different front |
| 2023-04-04T10:07:31ZA pigeon takes flight in a neighbourhood of Chasiv Yar, near the frontline, as Russia's... |
 Reuters Reuters | 6h | |
|
|
|
| India tests of eye drops linked to US deaths show no contamination - NDTV |
| 2023-04-04T10:11:49ZNo contamination was found in samples of eye drops made by India's Global Pharma... |
 Reuters Reuters | 6h | |
|
|
|
 | With abortion in the balance, Wisconsin voters to choose new high court judge |
| 2023-04-04T10:20:59ZWisconsin voters on Tuesday will select a new state Supreme Court justice in an election... |
 Reuters Reuters | 6h | |
|
|
|
| Analysis | Trump arraignment day: The first day of the 2024 ... - The Washington... |
| Analysis | Trump arraignment day: The first day of the 2024 ... The Washington Post |
 "FBI and election 2016" - Google News "FBI and election 2016" - Google News | 6h | |
|
|
|
 | Pregnancy Problems, Maternal Mortality at All-Time High |
| On Oct. 29, 2022, Whitney Reising Oliver died. She was 22 weeks pregnant with her first child, a little... |
 The Epoch Times | The Epoch Times The Epoch Times | The Epoch Times | 6h | |
|
|
|
 | How to Have More Money |
| You need more money, and you need it now. What are your choices? You have two: You can increase your... |
 The Epoch Times | The Epoch Times The Epoch Times | The Epoch Times | 6h | |
|
|
|
| Candida: A Fungus We All Carry That Can Lead to Most Common Fungal Infections, Tips... |
| Candida albicans is a type of fungus that causes some of the most common fungal diseases. The drug-resistant... |
 The Epoch Times | The Epoch Times The Epoch Times | The Epoch Times | 6h | |
|
|
|
| Israeli PM, Biden exchange frosty words over Netanyahu's legal overhaul plan - WYFF4... |
| Israeli PM, Biden exchange frosty words over Netanyahu's legal overhaul plan WYFF4 Greenville |
 "Biden in Israel" - Google News "Biden in Israel" - Google News | 6h | |
|
|
|
| Opening remarks at EU-US Energy Council - European Commission |
| Opening remarks at EU-US Energy Council European Commission |
 "global threats to U.S. security" - Google News "global threats to U.S. security" - Google News | 6h | |
|
|
|
| Direct-Path Attacks Surge in 2022 Making Up Half of All DDoS ... - InvestorsObserver |
| Direct-Path Attacks Surge in 2022 Making Up Half of All DDoS ... InvestorsObserver |
 "g-7 2022" - Google News "g-7 2022" - Google News | 6h | |
|
|
|
| At a Significant Growth Artificial Intelligence (AI) Hardware Market is ... - Digital... |
| At a Significant Growth Artificial Intelligence (AI) Hardware Market is ... Digital Journal |
 "Intelligence Assessments of Russia Ukraine War 2022" - Google News "Intelligence Assessments of Russia Ukraine War 2022" - Google News | 6h | |
|
|
|
| German opposition seeks inquiry over Scholz and tax scheme - ABC News |
| German opposition seeks inquiry over Scholz and tax scheme ABC News |
 "scholz" - Google News "scholz" - Google News | 6h | |
|
|
|
| German opposition seeks inquiry over Scholz and tax scheme - The Seattle Times |
| German opposition seeks inquiry over Scholz and tax scheme The Seattle Times |
 "scholz" - Google News "scholz" - Google News | 6h | |
|
|
|
| German opposition seeks inquiry over Scholz and tax scheme - WPXI Pittsburgh |
| German opposition seeks inquiry over Scholz and tax scheme WPXI Pittsburgh |
 "scholz" - Google News "scholz" - Google News | 6h | |
|
|
|
| German opposition seeks inquiry over Scholz and tax scheme - The Hill |
| German opposition seeks inquiry over Scholz and tax scheme The Hill |
 "scholz" - Google News "scholz" - Google News | 6h | |
|
|
|
 | Rendon suspended 5 games by MLB for interractions with fan |
| NEW YORK (AP) — Los Angeles Angels third baseman Anthony Rendon was suspended for five games and fined... |
 Associated Press News: Breaking News | Latest News Today Associated Press News: Breaking News | Latest News Today | 6h | |
|
|
|
| Putin teeters on knife edge as top lawyer warns arrest warrant could 'hasten his... |
| Putin teeters on knife edge as top lawyer warns arrest warrant could 'hasten his removal' Express |
 "Biden on Putin: The Butcher Of Bucha" - Google News "Biden on Putin: The Butcher Of Bucha" - Google News | 6h | |
|
|
|
 | Fire rips through Dhaka clothing market |
| (4 Apr 2023) A large fire broke out in a popular clothing market in Bangladesh's capital on Tuesday morning.... |
 Associated Press Associated Press | 6h | |
|
|
|
 | ShowBiz Minute: DiCaprio, Nathan Chasing Horse, Johnson |
| (4 Apr 2023) Leonardo DiCaprio testifies in money-laundering case of Fugees rapper; Sex abuse trial delayed... |
 Associated Press Associated Press | 6h | |
|
|
|
 | FC Barcelona Decide Starting Line Up For Copa Del Rey Clash With Real Madrid In El... |
| FC Barcelona have already decided upon their starting line up for Wednesday's Copa del Rey semi-final... |
 Markets and Business News Review Markets and Business News Review | 6h | |
|
|
|
 | Billionaire Richard Branson's Virgin Orbit Files For Bankruptcy After Failed Satellite... |
| Virgin Orbit, which laid off most of its staff last week, struggled to secure funding after a failed... |
 Markets and Business News Review Markets and Business News Review | 6h | |
|
|
|
 | McCarthy's Meeting With Taiwan's President Will Only Strengthen Fight For 'Reunification,'... |
| McCarthy will host a bipartisan meeting with Taiwanese President Tsai Ing-wen on Wednesday. |
 Markets and Business News Review Markets and Business News Review | 6h | |
|
|
|
 | FC Barcelona Could Receive Champions League Ban From UEFA Before June: Reports |
| FC Barcelona could receive a UEFA sanction such as being banned from the Champions League as early as... |
 Markets and Business News Review Markets and Business News Review | 6h | |
|
|
|
| Donald Trump To Surrender To History-Making Criminal Charges - News On 6 |
| Donald Trump To Surrender To History-Making Criminal Charges News On 6 |
 "Election 2016 Investigations" - Google News "Election 2016 Investigations" - Google News | 6h | |
|
|
|
| Russian Children's Commissioner Rejects ICC War Crime Allegations as False - Asharq... |
| Russian Children's Commissioner Rejects ICC War Crime Allegations as False Asharq Al-awsat - English |
 "Russia - China new strategic alliance by Putin and Xi" - Google News "Russia - China new strategic alliance by Putin and Xi" - Google News | 6h | |
|
|
|
| Joint Statement following the 10th EU-US Energy Council - European Commission |
| Joint Statement following the 10th EU-US Energy Council European Commission |
 "global threats to U.S. security 2023" - Google News "global threats to U.S. security 2023" - Google News | 6h | |
|
|
|
| Why Biden's new nuclear security agenda might not work as planned - Bulletin of the... |
| Why Biden's new nuclear security agenda might not work as planned Bulletin of the Atomic Scientists |
 "global threats to U.S. security 2023" - Google News "global threats to U.S. security 2023" - Google News | 6h | |
|
|
|
| Officials: US Providing Ukraine $2.6 Billion in Military Aid - U.S. News & World... |
| Officials: US Providing Ukraine $2.6 Billion in Military Aid U.S. News & World Report |
 "global threats to U.S. security 2023" - Google News "global threats to U.S. security 2023" - Google News | 6h | |
|
|
|
| Almost half of human rights defenders killed last year were in ... - The Guardian |
| Almost half of human rights defenders killed last year were in ... The Guardian |
 "russia-ukraine war 2022" - Google News "russia-ukraine war 2022" - Google News | 6h | |



No comments:
Post a Comment